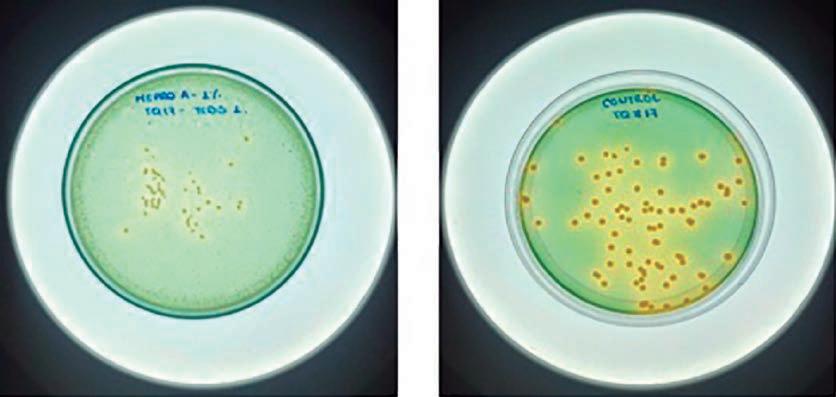
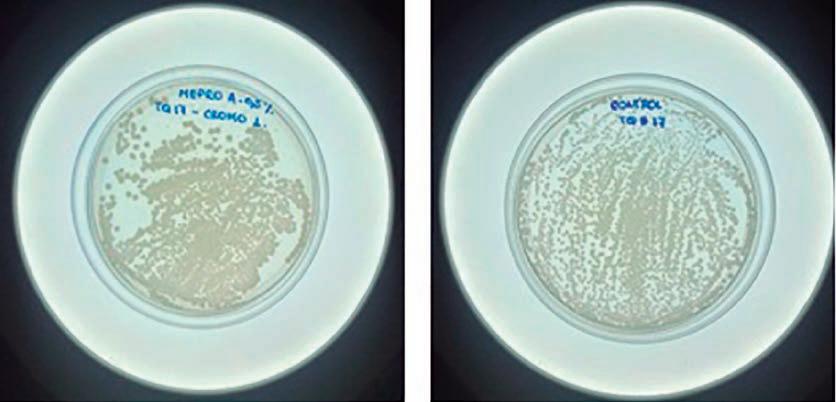
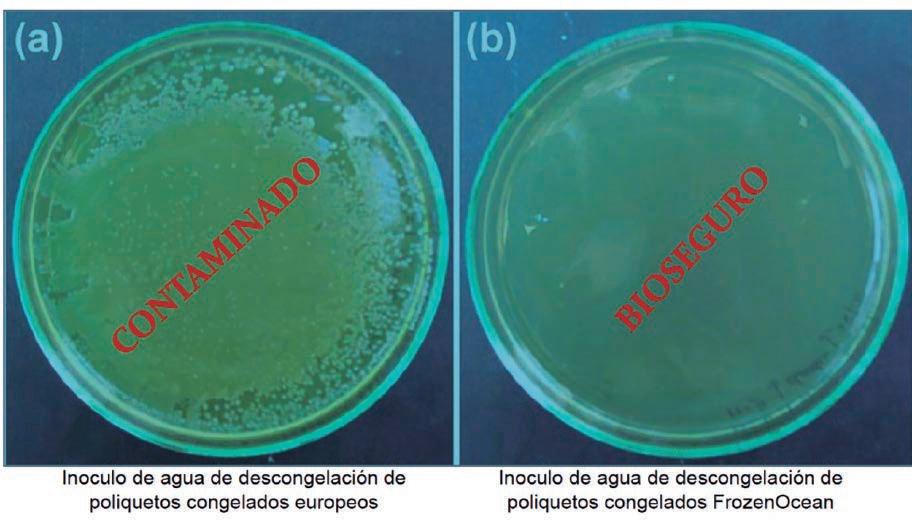

La industria de los reproductores de camarón está avanzando rápidamente, trayendo nuevos potenciales para crecimiento, resistencia a enfermedades y otras mejoras genéticas.
En su negocio Consejos de propietarios de pequeñas empresas exitosas.
Perspectivas
Desmitificando la acuicultura marina: críticas y suposiciones infundadas en Estados Unidos.
El efecto del revestimiento de estanques con geomembrana de polietileno en la dinámica de las bacterias del ciclo del azufre en estanques de cultivo intensivo de camarón Penaeus vannamei.
Sanidad acuícola Los probióticos modulan la resistencia y la respuesta inmune en la tilapia frente a la infección por el virus del lago de la Tilapia (TiLV).






Investigación y desarrollo Cómo mejorar la genética en la acuicultura.

Economía
20 años de revisión retrospectiva de la acuicultura mundial: Expansión global y desafíos persistentes.
Análisis
DIRECTOR
Salvador Meza info@dpinternationalinc.com
DIRECCIÓN ADMINISTRATIVA
Adriana Zayas Amezcua administracion@design-publications.com
GERENCIA ADMINISTRATIVA
Juan Manuel Martínez gerencia@design-publications.com
ASISTENTE EDITORIAL Lucía Araiza editorial@dpinternationalinc.com
COLABORADORES EDITORIALES
Carlos Rangel Dávalos
DISEÑO EDITORIAL Francisco Cibrian, Perla Neri
DISEÑO PUBLICITARIO Perla Neri design@design-publications.com
CIRCULACIÓN Y SUSCRIPCIONES
Renée Meza suscripciones@panoramaacuicola.com
COORDINADOR DE VENTAS Y MARKETING Juan Carlos Elizalde crm@dpinternationalinc.com
Ventas y Marketing Claudia Marín sse@dpinternationalinc.com
OFICINA EN LATINOAMÉRICA
Empresarios No. #135 No. Int. Piso 7 Oficina 723, Col. Puerta de Hierro, C.P. 45116 Zapopan, Jal., México. Cruza con las calles Av. Paseo Royal Country y Blvrd. Puerta de Hierro Tels: +(33) 8000 0578
OFICINA EN ESTADOS UNIDOS Design Publications International Inc. 203 S. St. Mary’s St. Ste. 160. San Antonio, TX 78205. USA Tel: +(210) 504 3642
COSTO DE SUSCRIPCIÓN ANUAL $750.00 M.N. DENTRO DE MÉXICO USD $100.00 EE.UU., CENTRO Y SUDAMÉRICA €80 EUROPA Y RESTO DEL MUNDO (SEIS NÚMEROS POR UN AÑO)
PANORAMA ACUÍCOLA MAGAZINE, Año 26, No. 4, mayo - junio 2021, es una publicación bimestral editada y distribuída por Design Publications, S.A. de C.V. Av. Empresarios #135 Piso 07 Oficina 723 Col. Puerta de Hierro CP. 45116. Zapopan, Jalisco, México. Tel: +52 (33) 80 00 05 78, www.panoramaacuicola.com, info@dpinternationalinc.com. Editor
Responsable: Salvador Antonio Meza García. Número de Reserva de Derechos de Uso Exclusivo 04-2019071712292400-01, licitud de Título No. 12732, Licitud de Contenido No. 10304, ambos otorgados por la Comisión Calificadora de Publicaciones y Revistas Ilustradas de la Secretaría de Gobernación. Permiso SEPOMEX No. PP-14-0033. Impresa por Negocios Graficos Grafinpren S.A. Telefono: 04-2221362 ext 28 / 0959537917. Av. C.J. Arosemena Km 2.5
Antiguo Coliseo Granasa, Guayaquil, Ecuador. Este número se terminó de imprimir el 31 de mayo de 2021 con un tiraje de 3,000 ejemplares.
La información, opinión y análisis contenidos en esta publicación son responsabilidad de los autores y no reflejan necesariamente el criterio de esta editorial.
Queda estrictamente prohibida la reproducción total o parcial de los contenidos e imágenes de la publicación sin previa autorización de Design Publications, S.A. de C.V.
Tiraje y distribución certificados por Lloyd International

Visite nuestra pagina web: www.panoramaacuicola.com
También síganos en:
FAO en la acuicultura
Carpe Diem
Artículo
#PescaConFuturo el movimiento de COMEPESCA por los pescados y mariscos sostenibles.
Artículo
Estreptococosis: métodos de control y prevención.


Artículo
El cultivo de langostino malayo M. rosenbergii en la región sureste de México. Una experiencia que concreta la cadena productiva y estimula la red de valor.






Artículo
La importancia de los nucleótidos en el desarrollo del tracto intestinal y la respuesta inmune de tilapias nilóticas.
Artículo
Los beneficios de la tecnificación con los equipos IOSA en la acuicultura.
Artículo Una mezcla de aminoácidos sustentable influye en la sobrevivencia de post larvas de camarón blanco ante la presencia de la Enfermedad de Necrosis Hepatopancreática Aguda y del Virus de la Mancha Blanca.
Artículo
Fuentes de proteína animal como sustituto de la harina de pescado en dietas de acuicultura: una revisión sistemática y un meta-análisis.
Artículo La cosecha de Artemia simplificada.
Producción de juveniles de Litopenaeus vannamei en un sistema de recirculación cerrado de agua dulce.

Nuevas soluciones para el control alimenticio del camarón.
Capacidad inhibitoria de una proteína microbiana mejorada ME-PRO® contra Vibrio spp en camarones blancos del Pacífico, Litopeneaus vannamei.

Efectos del alimento mezclado con bacterias del ácido láctico y del carbono, nitrógeno y fósforo suministrados al agua, sobre la tasa de crecimiento y supervivencia del camarón de pata blanca (Penaeus vannamei) infectado con la enfermedad de la necrosis hepatopancreática aguda causada por Vibrio parahaemolyticus.



FrozenOcean, Poliquetos Marinos de origen natural.
Una solución neurosensorial que optimiza el consumo y mejora la respuesta al estrés del camarón blanco Litopeneaus vannamei.
Nicovita Teráp E+, un resultado de la constante búsqueda de soluciones nutricionales terapéuticas costo-eficientes.
Interacción genotipo por ambiente en camarón blanco asociada a síndrome de mancha blanca.
Acuicultura y su contribución a la biodiversidad y la salud: dimensiones desconocidas.

¿Una nueva oportunidad para la Acuicultura en México?
Acuicultura y gobierno El gran potencial de las organizaciones de productores. La guía práctica Instrumentos de medición para oxígeno disuelto.

Marketing digital
Cinco temas de marketing digital a los que prestar atención en su empresa.
Nueva era en tecnologías acuícolas Nacimiento de una nueva tecnología acuícola: Acuicultura Multitrófica Integrada Simbiótica - AMTIS.

Nueva era en tecnologías acuícolas El siguiente paso en la evolución del cultivo de camarón: ¿un paso hacia adelante o hacia atrás?
Ferias y exposiciones
El 8 de junio se conmemora el Día Mundial de los Océanos. Este año a nivel mundial, se busca concientizar a la población sobre la importancia de la Innovación para desarrollar una economía oceánica sostenible, lo cual resuena con la apremiante necesidad de encontrar y desarrollar soluciones innovadoras para combatir el hambre y la falta de disponibilidad de alimentos en cantidad y en calidad para las sociedades humanas. Estos retos y la voluntad política y económica para confrontarlos ofrecen a su vez una gran oportunidad para la industria acuícola, de volverse parte y motor de una economía oceánica internacional sostenible, para el año 2030.


Está claro que la manera en que nuestro planeta se encuentra vinculado con la conservación de los ecosistemas y la seguridad alimentaria es una conexión muy profunda e interdependiente. Además, estos factores son muy relevantes para el mercado de pescados y mariscos, su distribución, comercialización, y sub sectores asociados que actualmente confrontan nuevos retos y dificultades alrededor del mundo, que han sido sobre todo acentuados por la pandemia derivada de COVID-19. Los efectos dominó que estamos experimentando como sociedad y el nivel al que se están manifestando no tienen precedente en la historia moderna, pero ciertamente son un referente de lo que podría devenir en los próximos años si como sociedad no atacamos el cambio
climático y nos comprometemos con las alianzas y colaboración que permitan combatirlo y mitigar nuestro impacto común, así como fortalecer nuestros sistemas de resiliencia, especialmente los asociados a la seguridad alimentaria.
En esta edición de Panorama Acuícola Magazine (26-4) mayo –junio 2021, presentamos una selección especializada de contenidos que profundizan en el estado actual del sector acuícola, las innovaciones que busca y las posibilidades que ofrece para que el sector tome parte activa en esta búsqueda de un desarrollo sostenible y el aprovisionamiento de alimentos saludables para la población. Esperamos que nuestros lectores disfruten de este número y encuentren en él información valiosa.
Email de contacto: editorial@dpinternationalinc.com


Una nueva iniciativa, liderada por la empresa Plasticopper, con apoyo del Centro de Innovación Acuícola AquaPacífico y la empresa Badinotti, busca desarrollar redes de cultivo antifouling a través de la incorporación de tecnología antimicrobiana.


Con diez años de experiencia y conocimiento en la aplicación y comercialización de tecnologías antimicrobiales basada en cobre, desarrolladas y patentadas por la Universidad de Chile, Plasticopper presenta hoy la posibilidad de desarrollar mejoras en herramientas de cultivo, con la innovadora incorporación de nanotecnología que podría disminuir el fouling marino (deposición indeseada compuesta por algas, moluscos y bacterias) en las redes.
El proyecto, recientemente adjudicado, es de rápida implementación con una duración de doce meses y financiado con fondos Corfo a través de su línea “Crea y Valida”, cuyo objetivo es apoyar el desarrollo de nuevos o mejorados productos, procesos y/o servicios de base tecnológica, a partir de prototipos hasta su validación técnica a escala industrial y comercial.
Se busca que los filamentos de estas redes, fabricados mediante la incorporación de nanoaditivos desarrollados por Plasticopper, en polietileno de alta densidad (HDPE), presenten una liberación de iones de cobre controlada y prolongada en el tiempo.
El fouling marino es uno de los principales problemas que afecta hoy a la industria acuícola, ejemplo de ello es lo observado en cultivos de salmones, donde la circulación del agua través de las mallas se reduce provocando acumulación de desechos de peces y disminución del oxígeno disponible. Esto repercute en la productividad por aumento de muerte, enfermedades y menor crecimiento de las especies. Por ello, el fouling necesita ser removido de las redes varias veces al año, lo que significa un aumento en los costos de operación en mantenimiento.
La propuesta responde entonces a una necesidad directamente asociada a la acuicultura, desde un punto de vista tecnológico e innovativo.
La empresa Badinotti, una de las principales fabricantes de redes acuícolas en Latinoamérica y el mundo,
es otra de las entidades asociadas al proyecto y quienes tendrán a cargo la elaboración de los prototipos de redes con el material desarrollado por Plasticopper.
De resultar exitosa la propuesta, la intención es implementar esta solución en las redes de cultivo elaboradas por Badinotti, y con ello, aportar al sector acuícola con beneficios como el incremento en la productividad, la reducción de costos de mantención, la disminución de los impactos al medio ambiente, entre otros. Cabe señalar que dada la contingencia sanitaria nacional, el inicio del proyecto se ha visto retrasado. Sin embargo, una vez se retomen las actividades, se podrá comenzar con la etapa de laboratorio y luego continuar con la validación técnica a mayor escala.
Más información: www.aquapacifico.cl
La Administración de Pesca del Ministerio de Agricultura y Desarrollo Rural de Vietnam trazó recientemente algunas nuevas medidas para desarrollar el cultivo acuícola nacional en la nueva coyuntura, informó el periódico electrónico Nhan Dan.
Para 2021, se debe mantener estable el actual área total del país destinada a dicho sector, precisamente un millón 300 mil hectáreas, incluidas 450 mil de agua dulce y 850 mil de agua salada y salobre.
En cuanto al volumen de producción, la entidad se ha fijado como meta una cifra de cuatro millones 750 mil toneladas, equivalente al
104.2% frente a la reportada en el año previo.
Para lograr esos resultados, según la institución, los sectores y localidades donde se practica la acuicultura necesitan impulsar la aplicación de la ciencia para aumentar la productividad y la calidad de cultivo.
También deben gestionar efectivamente la calidad de las variedades de especies criadas y de las instalaciones en el proceso, solventar las barreras técnicas, conservar el desarrollo del mercado tradicional y buscar a la vez nuevas salidas para sus productos.
Chile
por nanotecnología antifouling basada en cobre para mejorar redes de cultivo acuícola

lanza un curso online de formación en herramientas de gestión inteligente
Durante mayo, IMPAQT lanzó una formación online en formato MOOC con un contenido completo organizado en tres módulos que cubren temáticas como las prácticas IMTA (acuicultura multitrófica integrada) y retos como la evaluación de la sostenibilidad, la calidad y seguridad de pescado y marisco, las políticas que influyen en el desarrollo de la acuicultura en la UE o el funcionamiento de la plataforma de gestión IMPAQT.
Financiado dentro del programa europeo Horizonte 2020 y coordinado por el Marine Institute de Irlanda, IMPAQT (Intelligent Management System for MultiTrophic Aquaculture, en sus siglas inglesas) aúna a 21 socios multidisciplinarios de 12 países que destinan sus esfuerzos a promover y defender la eco intensificación y sostenibilidad de los sistemas de producción acuícolas.


Este curso hará accesible gran parte de los resultados del proyecto en un formato online, comprensible y dinámico y está dirigido a productores acuícolas, operadores y usuarios finales, a formadores que trabajan tanto con estos últimos como con los intermediarios de la industria, así como al personal de entidades reguladoras, políticas y organizaciones nacionales y pan-nacionales dedicadas al desarrollo de la acuicultura.
A la vez, IMPAQT trabaja mano a mano con otros proyectos EU H2020 relacionados con la economía azul y la acuicultura para establecer sinergias y ampliar el alcance de sus resultados.
Más información: https://impaqtproject.eu/knowledge-center/

La empresa de cultivo de salmón en tierra, Pure Salmon, ha firmado un acuerdo plurianual con Benchmark Genetics para el suministro ovas de salmón Atlántico a la totalidad de sus proyectos alrededor del mundo.
El volumen potencial del contrato representa más de 80 millones de ovas por año a plena capacidad y la primera entrega programada para 2022. El acuerdo también formaliza una colaboración estratégica entre las dos partes centrada en el desarrollo continuo de productos e I + D.
Con múltiples proyectos terrestres en ejecución a nivel mundial, que representan una producción objetivo de 260,000t de salmón Atlántico por año, Pure Salmon reconoce la importancia de la seguridad y continuidad en el suministro de ovas bioseguras, adaptadas a sus necesidades específicos, y entregadas a múltiples

localizaciones geografías durante el año.
La fase 1 del proyecto de expansión incluye unidades productivas en Japón, Estados Unidos
y Francia. La siguiente fase incluye la construcción y operación de granjas en China, sudeste asiático y los Emiratos Árabes Unidos.
Una de las amenazas más importantes para la salud humana en los años venideros es el de las resistencias antibióticas y, en particular, las que puedan adquirirse mediante la ingesta de alimentos. En el caso de la acuicultura y, en concreto, en los mariscos, existen pocos estudios sobre el tema. Para ello, el IRTA de Sant Carles de la Ràpita (Tarragona), trabajará durante los próximos tres años en el proyecto europeo SPARE-SEA en el que se busca conocer los mecanismos de adquisición de resistencias bacterianas por parte de las ostras con el objetivo de mejorar la práctica de su cultivo, reducir la propagación de dichas resistencias y, en última instancia, su impacto en la salud humana.
Las bacterias adquieren la resistencia a los antibióticos a través de genes que se conocen con el nombre de genes de resistencia antibiótica. Estos genes son diversos y para cada clase de antibiótico existen múltiples genes de resistencia. La adquisición de genes de resistencia a los antibióticos por parte de las bacterias, puede ser un factor que promueva la aparición de nuevos patógenos bacterianos que pasen desde el marisco a los humanos. El seguimiento de estos genes específicos en diferentes compartimentos ambientales (en el pescado que se alimenta del marisco, el agua, los sedimentos y el propio marisco) permitirá a los investigadores estudiar dónde existe cada clase de genes de resistencia antibiótica en la cadena alimentaria y ver cómo se transfieren entre compartimentos. Esto proporcionará información útil para gestionar las prácticas de cultivo de ostras de una manera que pueda reducir la propagación de genes de resistencia antibiótica y, en última instancia, su impacto en la salud humana.
Para ello, los investigadores del IRTA en el proyecto SPARE-SEA pretenden realizar el análisis genético comparativo de las ostras que recibieron en algún momento un tratamiento antibiótico en las fases de cría larvaria, con las ostras silvestres, con objeto de conocer hasta qué punto el uso de antibióticos, en los procesos de producción comercial, afecta a la abundancia y diversidad de bacterias resistentes en las ostras. Cabe resaltar que el uso de antibióticos en la acuicultura

europea se encuentra muy regulado y restringido.
El plan de trabajo incluye la secuenciación del genoma de especies bacterianas capaces de infectar tanto a los mariscos como a los seres humanos. Asimismo, la identificación temprana de las especies bacterianas que contengan genes de resistencia antibiótica y los compartimentos en los que se encuentren, permitirá la vigilancia dirigida de esas bacterias. El proyecto podrá probar si la virulencia se correlaciona de alguna manera con la resistencia antimicrobiana, y/o si la captación de los genes de resistencia en patógenos conocidos puede mejorar su propagación. «Aclarar los impulsores y las vías de transmisión de la resistencia antimicrobiana en las ostras es un aspecto clave de los resultados esperados de este trabajo», señala Karl Andree.

Este proyecto se encuadra dentro de la Iniciativa Científica Estratégica de Reducción de antimicrobianos en la producción animal del IRTA. SPARESEA es un nuevo proyecto europeo financiado por ERANET con un presupuesto de 975,723.00 euros para sus 3 años de duración. SPARE-SEA (Difusión ambiental y persistencia de resistencias antibióticas en sistemas acuáticos expuestos a la acuicultura de ostras, por sus siglas en inglés), está liderado por el Instituto Alfred Wegner, de Alemania, e incluye socios de Italia (Universidad de Nápoles) y Francia (CNRS y CNR) así como el apoyo de la Asociación de productores de moluscos FEPROMODEL, en el Delta del Ebro.
Más información: https://www.irta. cat/es/

La sostenibilidad en la producción de pescados y mariscos es algo que nos involucra a todos.
Por: COMEPESCA *COMEPESCA es el Consejo Mexicano de Promoción de los Productos Pesqueros y Acuícolas, el cual fue fundado como Asociación Civil en 2003, con el objetivo de promover el consumo de pescados y mariscos mexicanos para lograr una mejor calidad de vida para la sociedad mexicana, creando una dieta nacional nutritiva que coadyuve a reducir los actuales índices de desnutrición y sobrepeso, a la vez que asegurar el incremento de la cadena de valor del sector pesquero y acuícola nacional.

La integración de COMEPESCA se compone por empresarios de la cadena productiva y comercial, como son acuicultores, armadores, procesadores, distribuidores y comercializadores de pescados y mariscos de todo el país, así como de diversos organismos educativos, científicos y profesionales que aportan veracidad y credibilidad a las campañas y mensajes de promoción difundidos en sus diversas plataformas.
La sostenibilidad en la producción de pescados y mariscos es algo que nos involucra a todos. Es por eso que se creó la campaña #PescaConFuturo, un movimiento que tiene como objetivo difundir un mensaje de sostenibilidad en la producción pesquera y acuícola en México, mantener las poblaciones acuáticas en un nivel saludable y
que busca garantizar la satisfacción de la demanda mundial de alimentos marinos para futuras generaciones a través de un solo mensaje: la sostenibilidad.
Este movimiento realiza distintas acciones como: comunicar a los consumidores las distintas especies certificadas, a qué se refiere cada una de dichas certificaciones, recomendaciones de compra para productos del sector, así como información sobre los periodos de veda de las especies, con lo cual COMEPESCA contribuye a la salud de las aguas interiores y los mares del país. Además, a través de los procesos de certificación, contribuye junto al sector pesquero y acuícola a difundir información sobre mejoras prácticas de pesca y cultivo por igual, así como los vínculos entre productores, comercializadores, restaurantes, consumidores y más actores de las cadenas de valor para adoptar el compromiso colectivo; es decir, la sostenibilidad.
COMEPESCA cuenta además con un amplio directorio de más de 100 Chefs embajadores en todo el país que apoyan en la difusión de la importancia del consumo de pescados y mariscos sostenibles, así como la pesca responsable dentro de la región, a través de sus redes sociales, medios televisivos y en sus restaurantes con la preparación de platillos con pescados y mariscos producidos de manera sostenible.
Una especie sostenible es aquella que ha sido sometida a una evaluación independiente conforme a un estándar de sustentabilidad internacional que garantiza que la especie en cuestión es sostenible y no se ejerce un daño al medio ambiente durante su producción o extracción. COMEPESCA recomienda comprar productos que cuenten con alguna etiqueta de certificación emitida por Fair Trade o MSC, en el caso de la pesca; y por BAP y ASC en el caso de la acuicultura.
Actualmente el movimiento de #Pescaconfuturo cuenta con un mapa actualizado en 2021 sobre productos pesqueros y acuícolas sustentables y en procesos de sustentabilidad.
Al movimiento de #Pescaconfuturo puede sumarse todo productor, distribuidor, pero también todo consumidor, ya que no sólo se trata de vivir de los pescados y mariscos sostenibles, sino también de una preocupación creciente por la salud de nuestros mares y aguas interiores.
El camino hacia la sostenibilidad en el sector
En el año 2019 COMEPESCA organizó la primera edición del evento “Summit Latinoamericano por la sostenibilidad pesquera y acuícola”. Ese año el encuentro se realizó en Mérida, Yucatán y en él se reunieron expertos en los temas de productos del mar y acuicultura
#PescaConFuturo
sostenibles, trazabilidad, etiquetado, certificaciones, plataformas y vinculación de productores con mercados y más, para compartir experiencias, información y planes de acción futuros, compromisos y proyectos, con el fin de avanzar para crecer y consolidar el movimiento de productos del mar y pesca sostenibles, en esta región. La organización de este encuentro anual atiende a que COMEPESCA confía en que los problemas compartidos puedan llevar a crear soluciones y planes de acción entre todos los actores involucrados, que en este caso integran a productores, gobiernos, organizaciones internacionales, supermercados, distribuidores, hoteles, restaurantes y organizaciones de la sociedad civil.
Por segundo año en 2020, COMEPESCA organizó el Summit Latinoamericano de Sustentabilidad Pesquera y Acuícola que estaba programado para llevarse a cabo en Lima, Perú, pero debido a la pandemia, se realizó de manera virtual. En esta ocasión se transmitieron más de 40 sesiones, entre conferencias, eventos alternos y mesas de trabajo, cada uno con traducción simultánea para participantes de todo el mundo.

Los objetivos de este evento son impulsar y acelerar el desarrollo de la sostenibilidad pesquera y acuícola en Latinoamérica, así como intercambiar experiencias exitosas entre los países y organizaciones participantes, incentivar programas
y proyectos de colaboración entre el sector privado, social y público; promover y apoyar iniciativas de sostenibilidad de organismos reguladores, actores de la cadena de valor y consumidores.
Este año 2021, el país sede para la organización de la 3era edición de este evento será Chile y se espera que se lleve a cabo a finales del mes de Octubre.
*Les invitamos a conocer más de nosotros a través de nuestras páginas web: pescaconfuturo.com comepesca.com y sustenpescaacua.com así como a seguirnos en nuestras redes sociales; Facebook, Instagram, y Twitter: @Pescaconfuturo @COMEPESCA
A lo largo de los años de dirigir una pequeña empresa, los propietarios inevitablemente reúnen muchas lecciones sobre cómo crecer y dirigir un negocio de manera más efectiva.
Salvador Meza*Aquí hay seis consejos de negocios de pequeñas empresas exitosas a los que vale la pena prestar atención:

1. Construir una red de apoyo
Ser dueño de un negocio puede ser, a veces, una experiencia de aislamiento. Especialmente si es propietario de un negocio en solitario, se puede perder el contacto con otros dueños de negocios. La solución puede ser permanecer en una red de alguna comunidad
empresarial. Eso puede ser participando en cursos y reuniones empresariales en línea, a través de Facebook, LinkedIn o YouTube una hora cada cuatro semanas. En esas reuniones se pueden encontrar soluciones a los problemas y trabajar a través de decisiones difíciles con su negocio. Como propietario de un negocio ocupado, es difícil encontrar tiempo para establecer contactos, pero mejorar en la creación de redes y hacer contacto puede pagar dividendos en el futuro.
2. Sea
Una opción puede ser dividir las metas grandes en metas más pequeñas. Establecer metas a 10 años, a 3 años y a 1 año. La construcción de una cultura basada en el rendimiento comienza con ser muy específico sobre los objetivos a conseguir para usted y sus empleados.
3. Delegar siempre que sea posible Hay que aprender a delegar. En un
punto se puede contratar a personas que son mejores que usted para realizar algún tipo de trabajo. Hay que enfocarse en lo que mejor sabe hacer y delegar el resto.

Si usted es de los que se dio cuenta en plena pandemia de COVID-19 que estaba sentado en una oficina que le costaba al año algunos miles y que cuando tuvo que mandar a sus empleados a trabajar a su casa, nada pasó, o incluso mejoró el rendimiento de algunos, es tiempo de quedarse así, y si no lo ha hecho, es tiempo de irse a su casa. Cambie esos costos por una buena conexión a internet, un servicio confiable de servidores en la nube, y algunas plataformas de gestión que le ayuden a procesar información. Todo esto le va a ayudar a bajar costos.
La reducción de los gastos generales le va a dar tranquilidad en estos tiempos de incertidumbre. Si sus gastos generales son bajos, puede tomar decisiones de precios que de otra manera no podrá tomar.
5. Encuentre su mejor nicho y quédese con él ¿Está tratando de hacer mucho en poco tiempo?, ¿siente que necesita hacer todas las cosas para todos los clientes? Tal vez diversificar no siempre es la mejor estrategia. Algunas veces, es bueno replicar el éxito si se tiene algo que funciona muy bien.
Encontrar su nicho e innovar continuamente alrededor de ese nicho es un camino hacia el éxito.
6. Evite distracciones a toda costa
Dirigir una empresa “muy bien” no siempre es el trabajo de un emprendedor. Una empresa exitosa requiere 100 por ciento de atención, enfoque y esfuerzo. Las empresas secundarias necesitan un gerente de tiempo completo o de lo contrario, simplemente lo distraerán y descarrilarán sus esfuerzos existentes si no tiene cuidado.
Evitar las distracciones se aplica a la gestión de sí mismo para que usted realice sus tareas día a día. Lo mejor es hacer las tareas más importantes en las horas más disponibles, y realizar las tareas monótonas o repetitivas, en las horas de menor concentración. Mantenerse organizado y en la tarea indicada es la verdadera clave para el éxito de las pequeñas empresas. Si tienes algún consejo para compartir con otros dueños de negocios, comparte tus comentarios en nuestras redes sociales y plataformas digitales.
Los criaderos de Tilapias alrededor del mundo son cada vez más populares, actualmente ésta es la 2da especie acuícola de mayor producción a nivel mundial. Esto se debe principalmente a su buen rendimiento zootécnico, además de poseer características como carne blanca de excelente textura y sabor con buenas propiedades nutricionales. Como gran parte del crecimiento de la producción en Latinoamérica se desarrolla en un sistema intensivo de producción (jaulas flotantes y estanques en tierra), las cuestiones de orden sanitario pasan a ser determinantes en el éxito productivo y económico de las empresas, siendo, las enfermedades de origen bacteriano, las de mayor impacto económico entre las cuales están las ocasionadas por las bacterias: Francisella noatunensis subsp. orientalis, Flavobacterium columnare , Aeromonas, Streptococcus agalactiae y Streptococcusiniae , entre otras.
Actualmente la estreptococosis es considerada la enfermedad de mayor impacto económico a nivel mundial (Suresh,1998). En Latinoamérica no es diferente siendo ésta ocasionada principalmente por los diferentes serotipos de Streptococcus agalactiae y Streptococcus iniae que afecta principalmente peces adultos desde los 150 gramos de peso medio asociado al bajo crecimiento de animales subclínicos y positivos a la enfermedad.
Debido a que la inversión del productor hasta la fase del engorde es altamente significativa, cualquier mortalidad o caída de rendimiento en esta fase, se refleja en altísimas pérdidas económicas, impactando directamente la productividad final y la conversión alimenticia. La enfermedad se encuentra presente en
todos los países productores de tilapia de Latinoamérica.
Como control y prevención es necesaria la aplicación de buenas prácticas de producción, programas de bioseguridad, y la implementación de un programa de vacunación específico para los diferentes serotipos a los que la tilapia es susceptible.
En algunas ocasiones se utilizan antibióticos sin embargo las opciones en el mercado de antimicrobianos para uso acuícola son pocas, y hay implicaciones del uso responsable de antibióticos, se deben tomar en cuenta las limitaciones que tienen los tratamientos con antimicrobianos para enfermedades tan agresivas y de rápida replicación como la estreptococosis en peces adultos,
resultando la mayoría de las veces en acciones fallidas incapaces de solucionar el problema, implicando altos costos y poca rentabilidad para el productor.
Por otro lado, existen en el mercado vacunas comerciales las cuales confieren protección contra Streptococcus agalactiae y serotipos y contra Streptococcus iniae durante todo el ciclo de producción, reduciendo los altos costos que implican los tratamientos poco efectivos con uso de antimicrobianos promoviendo la rentabilidad de las producciones.
Referencias:
Artículo técnico “Estreptococosis en la tilapiacultura de América Latina” en Panorama Acuícola Magazine, edición nov/dic 2020.
*Más información: https://www.msd-salud-animal.mx/aqua/


Existe una variedad de mitos críticos de la acuicultura marina en Estados Unidos, que han persistido durante décadas para ser presentados como hechos al público y al Congreso. La Asociación Nacional de Acuicultura (NAA) recientemente publicó un análisis actualizado para desmitificar estos argumentos negativos contra la acuicultura marina. Los autores de este análisis consideran que los críticos no están familiarizados con este ambiente o han asumido erróneamente que los daños ambientales relacionados con la acuicultura marina reportados en otros países ocurren también en Estados Unidos, cuando la realidad es que los productores de peces y mariscos de este país cultivan animales y plantas acuáticos dentro de un entorno legal, regulatorio, de cría y científico muy complicado y costoso.
Por: NAA ( Asociación Nacional de Acuicultura) *Estados Unidos no es un líder mundial en producción acuícola sostenible por volumen o valor, pero se encuentra en el desarrollo cuidadoso y riguroso de prácticas de producción regulatorias y no regulatorias, manejo de la nutrición y salud
animal, así como el procesamiento y distribución eficiente de productos alimenticios de alta calidad y saludables. Un análisis reciente del potencial de la acuicultura marina mundial concluyó con una declaración que es muy relevante para la acuicultura de los Estados Unidos al
resaltar el amplio potencial de este país para ser un líder mundial en sostenibilidad, tecnología y producción de alimentos.
Dado el importante potencial de la acuicultura marina, quizás sea sorprendente que el desarrollo de nuevas granjas sea poco común.


regímenes regulatorios restrictivos, los altos costos, la incertidumbre económica, la falta de capital de inversión, la competencia y las limitaciones en la transferencia de conocimientos a nuevas regiones se citan a menudo como impedimentos para el desarrollo de la acuicultura marina.

Los regímenes regulatorios restrictivos, los altos costos, la incertidumbre económica, la falta de capital de inversión, la competencia y las limitaciones en la transferencia de conocimientos a nuevas regiones se citan a menudo como impedimentos para el desarrollo de la acuicultura marina (Ver tabla 1). Además, las preocupaciones en torno a la sostenibilidad de los alimentos acuícolas, la salud de los océanos y los impactos de esta actividad en la pesca silvestre han creado resistencia al desarrollo de la acuicultura marina en algunas áreas. Si bien se ha logrado un progreso continuo y significativo para abordar los problemas de sostenibilidad con la acuicultura marina, el enfoque continuo en estos problemas y la dedicación para garantizar las mejores prácticas serán un elemento crucial para dar forma al futuro del sector.
Tanto las dimensiones culturales y económicas del desarrollo, como los sistemas regulatorios y de gestión son de vital importancia para comprender las trayectorias de crecimiento realistas y las repercusiones de este crecimiento. Los resultados de este análisis desarrollado por la NAA muestran que existe potencial para que la acuicultura continúe su rápida expansión, pero será necesario un análisis más cuidadoso y el desarrollo de políticas con visión a futuro para garantizar que este crecimiento mejore el bienestar de las personas al tiempo que mantiene, y tal vez mejora, los ecosistemas oceánicos.
Mito: la pesca comercial y la acuicultura de peces marinos no pueden coexistir
La afirmación de que la pesca comercial y la acuicultura marina no pueden coexistir se ha hecho durante los últimos 39 años y se ha demostrado que es falsa en 23 estados costeros donde la producción de salmón del Atlántico, ostras, almejas y mejillones ha crecido, prosperado y en muchos casos fue liderada por pescadores comerciales. A nivel mundial, la pesca comercial ha continuado con el crecimien-


to de la producción de acuicultura marina, y en los pocos casos en que se han construido y operado jaulas marinas en los Estados Unidos, es decir, Hawái, Maine y Puerto Rico, esas granjas a menudo fueron bien recibidas por los pescadores comerciales y recreativos.
Existe un imperativo mundial para aumentar la producción sostenible de proteínas, siendo los productos del mar capturados en el medio silvestre y criados en granjas un componente importante para lograrlo. Estados Unidos tiene la capacidad de lograr este objetivo mientras lidera el mundo en protección ambiental.
Como acuicultores que producen un producto perecedero que compite con el resto del mundo por una pequeña porción del mercado de productos del mar de Estados Unidos, creemos que nuestro enfoque y el enfoque de los pescadores del país debe ser convertirnos en los mejores y más eficientes acuicultores y pescadores que podamos ser. Quejarse de que no podemos coexistir no cumple el objetivo compartido de proporcionar productos nacionales para los crecientes mercados locales y el resto del mundo. Al centrarnos en nuestra capacidad colectiva para competir en los mercados mundiales, ayudaremos a preservar los frentes de agua en funcionamiento y aseguraremos que las comunidades costeras sigan siendo resilientes. Nuestra competencia no es entre nosotros, sino con los productores extranjeros de bajo costo que no tienen que cumplir con regulaciones estrictas.
Mito: Las regulaciones federales, los permisos y los procesos de revisión ambiental son inadecuados para administrar granjas de peces en alta mar
En los Estados Unidos, desde la década de 1970, la Agencia de Protección Ambiental (EPA) tiene autoridad para regular las descargas de las granjas de peces (por ejemplo de nutrientes, productos químicos y desechos sólidos) bajo varias iteraciones de la Ley Federal de Control de la Contaminación del Agua (es decir, Ley de Aguas Limpias). Más
recientemente, grupos ambientalistas buscaron que la EPA reevaluara los estándares de la Ley de Aguas Limpias aplicados a la acuicultura.
Durante un período de cuatro años, entre 2000 y 2004, la agencia completó una revisión técnica detallada de sus estándares vigentes en ese momento y de los métodos modernos de acuicultura, incluidos los utilizados para la acuicultura marina. Se llevó a cabo una reglamentación formal para garantizar que las regulaciones de la Ley de Aguas Limpias para la acuicultura cumplieran con todos los estándares de protección ambiental exigidos por el Congreso. En ese proceso, la EPA determinó, contrariamente a la posición de los grupos ambientalistas, que las regulaciones revisadas
propuestas y adoptadas aseguraban la protección ambiental.
Mito: Las jaulas marinas de cultivo acuícola son granjas industriales que contribuyen a la contaminación marina causada por el exceso de alimento, los desechos de pescado no tratados, los antibióticos y los compuestos anitfouling

La alimentación es un costo significativo para todas las producciones acuícolas y puede oscilar entre el 50% y el 60% de los costos variables. Como consecuencia, los acuicultores invierten en la capacitación y la infraestructura de los empleados para almacenar, manipular, entregar y monitorear el ali-
mento para los peces de la manera más eficiente y con la menor pérdida posible. Los aspectos prácticos de la tecnología de monitoreo de alimentos raramente se presentan en la literatura científica; aunque se han adoptado enfoques sofisticados para incluir cámaras, radares Doppler, detección de infrarrojos, sensores de sonar y conjuntos de sensores de calidad del agua. El monitoreo actual de alimentos en los Estados Unidos recurre a los empleados de la granja que observan el consumo de alimento a través de video en cada jaula para detener la alimentación cuando los peces están cerca de la saciedad.
El índice de conversión alimenticia (FCR) (peso del alimento ofrecido / peso del pescado producido) ha tendido a la baja a medida que el manejo del alimento y la calidad del alimento han mejorado de 3: 1 (3 libras de alimento por 1 libra de pescado cosechado) a alrededor de 1: 1.
La densidad de peces es un sistema de producción, y una cuestión com-
pleja que depende del comportamiento, la fisiología y la calidad del agua en que se cultivan las especies. El éxito de toda granja que cría animales, terrestres o acuáticos, depende de la salud y el crecimiento de los animales. Los peces cultivados en jaulas marinas se benefician de la práctica estándar de un volumen bajo, 2% a 3% de pescado en el momento de la captura, en relación con el volumen de la jaula marina.
Las prácticas actuales de manejo de granjas y alimentos acuícolas refutan las afirmaciones de que la acuicultura marina en alta mar causa daños en la calidad del agua o en la ecología bentónica.
Las granjas deben cumplir con las prácticas de producción establecidas y las regulaciones federales que requieren la alimentación eficiente de formulaciones de alimento óptimas, manejo de alimento para reducir la pérdida, mantenimiento del equipo de alimentación, capacitación de empleados en prácticas
de alimentación eficientes y mantenimiento de registros e informes de eficiencia alimenticia (conversión de alimento a cantidad de pescado producido). En Estados Unidos además, las granjas deben cumplir con estrictas normas de descarga y son monitoreadas de cerca con un conjunto de métricas de impacto ambiental. Si exceden esos estándares de descarga o las métricas de impacto, sus permisos del Sistema Nacional de Eliminación de Descargas de Contaminación (NPDES) otorgados por la Agencia de Protección Ambiental pueden ser rescindidos. Sin un permiso NPDES válido, deben cesar sus operaciones.

Estados Unidos restringe severamente la disponibilidad y el uso de medicamentos para animales acuáticos a través de la Ley de Alimentos, Medicamentos y Cosméticos. Otros productos químicos (por ejemplo, desinfectantes, detergentes u otros agentes de limpieza) que pueden usarse en las instalaciones de acuicultura están regulados por la Agencia de Protección Ambiental de
A diferencia de los equipos para pesca que están diseñados para “atrapar” animales intencionalmente, los equipos de acuicultura están diseñados para contener a los animales que se cultivan, sin dañarlos ni a ningún animal salvaje que pueda encontrarse alrededor de las granjas.
los EE. UU. (EPA). La Administración de Drogas y Alimentos de Estados Unidos (FDA) revisa y aprueba los medicamentos para animales acuáticos utilizando el mismo paradigma regulador que el de la medicina humana (por ejemplo, eficacia para mitigar enfermedades, efectos en el animal, efectos directos o indirectos en el medio ambiente, riesgos para la salud humana).
No hay antibióticos aprobados para su uso en peces marinos como la cobia, el pargo, el bacalao o cualquier otro pez candidato para la acuicultura marina en alta mar. Los antibióticos solo se pueden usar de acuerdo con las instrucciones de la etiqueta o según lo prescrito por un veterinario. Las regulaciones federales requieren que las granjas informen sobre el uso de medicamentos antes de administrarlo y después del tratamiento. Una granja debe describir el uso potencial de químicos en su solicitud de permiso de la EPA y cumplir con las condiciones del permiso si se permite el uso. En la mayoría de los casos, las condiciones del permiso requieren un monitoreo ambiental para detectar posibles residuos de antibióticos. Si se detectan residuos, las granjas deben cambiar sus operaciones para reducir cualquier riesgo de impactos ambientales.
La bioincrustación (biofouling) en ambientes marinos ocurre cuando animales y plantas se adhieren a las superficies duras y blandas asociadas con los equipos de producción de peces, mariscos y algas (jaulas, redes, cestas, flotadores, cuerdas y anclas). Los animales y plantas en crecimiento agregan peso y arrastre, restringen el flujo de agua impactando la alimentación del filtro u oxigenación, reducen el valor comercial o albergan patógenos y parásitos. Los costos económicos directos de este efecto en la granja se han estimado de manera conservadora entre el 5 y el 15% de los costos de producción.
Las granjas de peces marinos en alta mar deben cumplir con las regulaciones federales aplicables

para todo uso marino de compuestos anitfouling al igual que todos los propietarios de embarcaciones comerciales o recreativas, fabricantes de boyas de navegación o entidades públicas o privadas que mantienen boyas y marcadores; y de manera similar para los compuestos anitfouling aplicados a estructuras marinas. En el caso de las granjas comerciales de jaulas con redes, la mayoría han eliminado el intercambio de redes y el uso de compuestos anitfouling en éstas y en su lugar están utilizando limpiadores de redes mecánicos robóticos o mallas metálicas de aleación de cobre.
El uso y la aplicación de compuestos anitfouling en el ambiente marino está regulado por la EPA bajo la autoridad otorgada por la Ley de Aguas Limpias y la Ley Federal de Insecticidas, Fungicidas y Rodenticidas. Los solicitantes de registro de uso de este tipo de sustancias deben obtener la aprobación de la Oficina de Programas de Plaguicidas de la EPA de Estados Unidos, que supervisa los registros y revisiones periódicos de plaguicidas y regula el uso de los mismos para prevenir efectos adversos significativos en organismos no objetivo. Los contenedores de estas sustancias incluyen instrucciones en la etiqueta, aprobadas por la EPA, que regulan el almacenamiento, manipulación, aplicación y eliminación. La Oficina del Agua de la EPA es responsable de implementar la Ley de Aguas Limpias y estatutos similares diseñados para mantener los ecosistemas acuáticos para proteger la salud humana; apo-
yar las actividades económicas y recreativas; y proporcionar un hábitat saludable para peces, plantas y la vida silvestre.
Mito: Las granjas marinas enredan a los animales marinos
El proceso federal de permisos para granjas en alta mar requiere consultas entre agencias, según lo autorizado por la Ley de Política Ambiental Nacional, para hacer cumplir las disposiciones de la Ley de Especies en Peligro de Extinción, la Ley de Protección de Mamíferos Marinos, la Ley del Tratado de Aves Migratorias y la Ley de Conservación y Manejo de Pesquerías Magnuson-Stevens para prevenir lesiones o muerte de especies incluidas en la lista, mamíferos marinos y aves; y para prohibir la captura, posesión o venta de pesquerías no autorizadas.
A diferencia de los equipos para pesca que están diseñados para “atrapar” animales intencionalmente, los equipos de acuicultura están diseñados para contener a los animales que se cultivan, sin dañarlos ni a ningún animal salvaje que pueda encontrarse alrededor de las granjas.
Mito: Los peces criados en granjas que escapan tienen un impacto adverso en las poblaciones de peces silvestres
Belle y Nash (2008) señalaron que los peces que escapan pueden presentar una variedad de riesgos ambientales, incluida la transmisión de patógenos, el cruzamiento con conespecíficos silvestres para
introducir nueva genética, la competencia por los recursos, la depredación, colonización o alteraciones a la pesca comercial o recreativa existente. En relación al tema los autores señalan: “para la mayoría de las especies acuáticas cultivadas comercialmente en los Estados Unidos, estos resultados no se han producido ni se prevé que ocurran porque:

• Los productores tienen un fuerte incentivo económico para prevenir el escape de animales cultivados y recuperar animales que escapan;
• La mayoría de los patógenos ocurren naturalmente y son ubicuos;
• La mayoría de las especies se cultivan en su área de distribución nativa;
• La introducción y propagación exitosa de una especie no nativa a menudo encuentra una fuerte resistencia biológica; y
• Las agencias federales y estatales han implementado una variedad de regulaciones sobre especies invasoras para prevenir, controlar, manejar o mitigar ilos potenciales impactos de su presencia”.
Este marco regulatorio y no regulatorio ha sido efectivo para Estados Unidos. La cría de peces en aguas estatales, a menos de tres millas de
la costa y dentro de las ensenadas y bahías costeras, se practica de forma limitada en Hawái, Maine y Washington.
Mito: La harina de pescado y el aceite de pescado en los alimentos para peces no son sostenibles
En 2018, alrededor del 88% (o más de 172 millones de toneladas) de los 197 millones de toneladas de la producción mundial total de pescado se utilizaron para el consumo humano directo, mientras que el 12% (o alrededor de 24 millones de toneladas) se utilizaron para fines no alimentarios. De estos últimos, el 80% (alrededor de 20 millones de toneladas) se redujo a harina y aceite de pescado, mientras que el resto (4 millones de toneladas) se utilizó principalmente como peces ornamentales, para cultivo (por ejemplo, alevines, o adultos pequeños para el crecimiento), como carnada, en usos farmacéuticos, como alimento para animales domésticos o como materia prima para la alimentación directa en la acuicultura y la cría de ganado y animales de granja terrestre. La harina de pescado, el aceite de pescado y los subproductos de la pesca (piel, huesos y menuden-
cias) se utilizan en la producción de alimentos para animales terrestres y acuáticos, biocombustible y biogás, productos dietéticos (quitosano), productos farmacéuticos (aceites omega-3), pigmentos naturales, cosméticos, alternativas al plástico y componentes en otros procesos industriales. Una proporción significativa, pero en disminución de la producción pesquera mundial, se procesa en harina y aceite de pescado debido al uso cada vez mayor de subproductos pesqueros para producir harina y aceite de pescado, y al uso de sustitutos como proteínas y aceites producidos por plantas, insectos, algas y microbios.
La harina y el aceite de pescado todavía se consideran los ingredientes más nutritivos y digeribles para el pescado de granjas acuícolas así como la principal fuente de ácidos grasos omega-3 (ácido eicosapentaenoico [EPA] y ácido docosahexaenoico [DHA]). Sin embargo, sus tasas de inclusión en los alimentos compuestos para la acuicultura han mostrado una clara tendencia a la baja, en gran parte como resultado de la variación de la oferta y los precios, junto con la demanda en continuo aumento de la industria de alimentos acuícolas. Estos ingre-
dientes se utilizan cada vez más de forma selectiva en etapas específicas de la producción, como para las dietas de incubación, reproductores y finalización. La incorporación de harina y aceite de pescado en las dietas de los productores está disminuyendo.
En Estados Unidos se han realizado considerables inversiones públicas y privadas en investigación con el objetivo de reducir las cantidades de cualquiera de los ingredientes en las dietas que producirán productos finales, de crecimiento y de salud animal excelentes con beneficios nutricionales deseables para el ser humano.
La comunidad acuícola de este país utiliza formulaciones de alimentos que se esfuerzan por lograr una nutrición adecuada en lugar de centrarse en la harina de pescado o el aceite de pescado como un indicador de sostenibilidad. Las granjas deben ser reconocidas por utilizar alimentos compuestos apropiados para sus animales acuáticos y su sistema de producción; y que los avances en la formulación de alimentos compuestos están avanzando a un ritmo rápido y sostenible.

Mito: Los peces criados en granjas desplazarán a las pesquerías de Estados Unidos, y son baratos y de baja calidad Fundamentalmente para los acuicultores estadounidenses, es muy difícil producir pescado “barato” en este país debido a la gran cantidad de regulaciones ambientales y de recursos naturales federales y estatales centrados en el cultivo, posesión, venta y salud de los ani-
males acuáticos, uso y calidad del agua, uso de la tierra y acceso a los mercados y el trabajo local, estatal y nacional; la seguridad, las regulaciones y permisos comerciales, así como las condiciones nacionales del salario mínimo obligatorio para los trabajadores.
Lo que también está claro, y a menudo falta en el debate sobre la competencia, es que la competencia existirá con o sin la presencia de la acuicultura nacional. El mercado es global y la demanda de productos del mar está creciendo. Estados Unidos no puede satisfacer la demanda de productos del mar por parte de los consumidores a través de las actividades de pesca únicamente. Las importaciones de productos del mar y otras formas de proteínas, como la carne de res y el pollo, ya suponen una competencia significativa. Los ejecutivos de negocios de productos del mar que hablaron en la Cumbre Nacional de Acuicultura Marina dijeron que si los productos del mar no están disponibles en las fuentes estadounidenses, sus clientes exigen que los consigan en otro lugar.
Las nuevas reglas de la Administración de Alimentos y Medicamentos de EE. UU. Autorizadas por la Ley de Modernización de la Seguridad Alimentaria han agregado regulaciones adicionales para el procesamiento, manejo y transporte de alimentos para animales y humanos. Estos controles ayudan a que los productos del mar cultivados en granjas sean alimentos seguros y saludables.
Como acuicultores estadounidenses, estamos en una desventaja
de precios muy real y reconocemos que los precios de los productos de importación son uno de nuestros mayores desafíos. En respuesta, en lugar de un enfoque proteccionista, la Asociación Nacional de Acuicultura ha estado trabajando para desarrollar mercados que aprecien los productos de pescados, mariscos y algas cultivados localmente y de alta calidad, así como las prácticas de producción sostenible de esta región, la gestión ambiental que conllevan y los beneficios nutricionales y el valor de comprar alimentos cultivados localmente.
Nota del editor: Este análisis fue revisado y actualizado el 20 de enero de 2021. El presente artículo resume la información encontrada en él, sin embargo recomendamos ampliamente a nuestros lectores que accedan a la versión original para profundizar en las referencias y fuentes consultadas por los autores.
* La Asociación Nacional de Acuicultura (NAA) representa a los acuicultores de Estados Unidos que crían animales y plantas acuáticos destinados a los mercados de alimentos, cebos, ornamentales, pesca recreativa y como huevos fértiles, larvas, alevines o semillas para criar en granjas de cultivo. Esta es una asociación sin fines de lucro impulsada por productores nacionales, incorporada en 1991 y que durante 30 años ha trabajado para garantizar que la sostenibilidad, rentabilidad y desarrollo de la industria acuícola se produzcan de una manera sostenible.
La versión original de este análisis se puede encontrar en: http://thenaa.net/pub/NAA-RefutingMarine-Aquaculture-Myths.pdf
Los estanques de cultivo forrados con geomembrana de polietileno proporcionan una fácil eliminación de la carga orgánica, permitiendo así realizar cultivos de mayor densidad y aumentando el número de cosechas por año, en comparación con los estanques de tierra.
Por: N. Manoharan, H.G. Solanki and A.K. Ray *Esta investigación compara la tendencia de los heterótrofos totales, los Vibrios totales y las bacterias del ciclo del azufre en los estanques de cultivo de Penaeus vannamei de tierra y forrados con geomembrana de polietileno y la influencia de la gestión a nivel de producción de la aplicación de probióticos exógenos.
Se puede concluir que los estanques forrados con geomembrana de polietileno proporcionan un mejor manejo y condiciones ambientales más saludables, de tal manera que las bacterias del ciclo del azufre se pueden utilizar como un indicador de las condiciones ambientales de los estanques.
La calidad del agua en los sistemas acuícolas en gran medida está controlada por la biodegradación microbiana de residuos orgánicos (Avnimelech et al., 1995; Abraham et al., 2004) a través del proceso de mineralización. Los microorganismos están involucrados no sólo en la producción y descomposición de materia orgánica, sino también en el reciclaje de nutrientes en ambientes acuáticos.
Las bacterias heterotróficas oxidan la materia orgánica, mientras que las bacterias nitrificantes y azufre autotróficas oxidan compues-

El efecto del revestimiento de estanques con geomembrana de polietileno en la dinámica de las bacterias del ciclo del azufre en estanques de cultivo intensivo de camarón Penaeus vannamei
tos problemáticos como amonio, nitrito o sulfuro, respectivamente (Moriarty, 1997).
Las bacterias que reducen el azufre (SRB) y las bacterias sulfuroxixidisantes (SOB) están principalmente implicadas en la reducción y oxidación de sulfatos y sulfuro de hidrógeno en el fondo del estanque (Syed et al., 2006) y ayudan a mantener un ambiente saludable en estanques comerciales de cultivo de camarones (Rao et al., 2000; Devaraja et al., 2002; Burford et al., 2003; Abraham et al., 2004, 2015; Fernandes et al., 2010; Patil et al., 2012).
Los estudios sobre el papel de las bacterias del ciclo de azufre en los sistemas de cultivo P. vannamei son escasos. Smith y Briggs (1998) sugirieron revestimientos completos de estanques (geotextil) contra el estanque de tierra para manejar la carga de nutrientes en los sistemas de cultivo de camarones, pero no discutieron el papel del revestimiento de estanques en la dinámica microbiana, aunque el revestimiento de estanques es un sistema de entrada altamente intensivo y alto con cero intercambios de agua.


Las investigaciones actuales comparan observaciones sobre la tendencia de heterótrofos totales, Vibrios totales y especialmente las bacterias del ciclo de azufre (SOB y SRB) que juegan un papel importante en la comprensión del ecosistema en estanques comerciales de cultivo P. vannamei
En este estudio se realizó la comparación entre tres estanques de tierra de una hectárea sembrados con postlarvas 12 días a 30 por metro cuadrado, contra tres
estanques forrados con geomembrana de polietileno, sembrados con postlarvas de 12 días a 90 por metro cuadrado.
Los estanques se prepararon para la siembra de manera similar, con protocolos adecuados para cada caso. En los dos grupos de estanques se utilizó el mismo alimento comercial, con un porcentaje de proteína de 30 – 35 %, igual en cada caso. Los dos grupos de estanques tuvieron aireación similar durante todo el periodo de la prueba.
Se recogieron muestras de agua y sedimentos de ambos grupos quincenalmente de los dos grupos de estanques, las cuales se depositaron en botellas de plástico esterilizadas y bolsas de plástico, respectivamente, y se transportaron al laboratorio en una caja aislada que contenía paquetes de hielo de gel pre enfriado. Las muestras se procesaron dentro de las 4 h de recolección y se almacenaron para su posterior análisis.
- Análisis fisicoquímico:
Se analizaron muestras de agua para pH, salinidad, calcio, magnesio, dureza total, carbonato, bicarbonato, alcalinidad total, nitrógeno nitrito y muestras totales de nitrógeno y sedimentos de amoníaco para pH, conductividad eléctrica, carbono orgánico, nitrógeno disponible y fósforo disponible, mediante procedimientos estándar [Asociación Americana de Salud Pública (APHA), 1998].
- Análisis bacteriológico:
Se analizaron muestras de agua y sedimentos en busca de bacterias
Figura 1. Diagrama de flujo que menciona la preparación del estanque antes de la siembra de postlarvas.
heterotróficas y presuntos recuentos de Vibrios en el agar marino Zobell y el agar de tiosulfato-citrato-bilis, respectivamente (Gilliland et al., 1976; Austin, 1988). Bacterias del ciclo del de azufre, SOB y SRB por la técnica MPN número más probable utilizando medios específicos (Rodina, 1972). Los medios empleados para el aislamiento de SOB incluyen ambos compuestos de 3,0 g a 0,5 g (NH4)2 SO4, rastros de FeSO4 en agua destilada de 1.000 ml con pH 8.0.
- Análisis estadístico: La importancia estadística de la diferencia entre los medios de tratamiento y el análisis de correlación se calculó utilizando el paquete estadístico, Microstat Ecosoft, Inc. 1984. Las diferencias entre los medios fueron determinadas y comparadas por la prueba de Tukey.
- Parámetros fisicoquímicos del agua:

Los niveles de parámetros fisicoquímicos como pH, salinidad, CO3 -2, HCO3 -1, alcalinidad total, NO2 -N y NH3 -N están muy dentro de los valores óptimos (MPEDA, 1992) en ambos grupos.
Los valores de pH en estanques de tierra no mostraron amplias variaciones a lo largo del período de cultivo, pero sí mostró una tendencia decreciente que puede deberse a una mayor población bacteriana heterotrófica en estos estanques de tierra (Panjaitan, 2010).


- Parámetros de calidad del suelo en estanques de tierra:
El valor del pH osciló entre 7,92 y 8,44 (8,204 ± 0,081), el porcentaje de carbono orgánico osciló entre 0,43 al 0,94% (0,72 ± 0,007), el contenido disponible de nitrógeno osciló entre 101,91 y 230,5 kg/ha (158,0 5 ± 15,18), fósforo disponible oscila entre 16,99 y 88,73 kg/ ha (56,86 ± 21,22) y el potasio disponible osciló entre 3.022,7 y 5.288
Figura 2. Recuentos bacterianos totales en muestras de suelo y agua de estanques de cultivo de L. vannamei revestidos y de tierra. Figura 3. Recuentos totales de Vibrio en muestras de suelo y agua de estanques de cultivo de L. vannamei revestidos y de tierra.kg/ha (442,38 ± 590,47) todos dentro del rango normal.
La tendencia en las poblaciones bacterianas con el progreso del cultivo se muestra en las Figuras 2–5. Como se muestra en el Tabla 2, el recuento total de bacterias (TBC), el recuento total de Vibrios (TVC), SOB y SRB en ambos sistemas fueron significativamente diferentes (P < 0,01).

Se encontró que los recuentos promedio de poblaciones bacterianas en sedimentos de estanques de tierra eran más altos en todos los estanques en comparación con las muestras de agua (Fig. 1).

El TBC superó en número a las poblaciones de TVC, SOB y SRB, lo que indica el papel principal de las abundantes bacterias heterotróficas sobre las poblaciones bacterianas beneficiosas autotróficas. Otros autores también informaron de resultados similares (Rao et al., 2000; Devaraja et al., 2002; Patil et al., 2012).
En ambos grupos, las aplicaciones de los desinfectantes en el presente estudio, aunque podrían haber funcionado en el momento de la aplicación, al final tal vez no pudieron ayudar a controlar las bacterias patógenas que son Vibrios o que la calidad del agua fue deteriorando la población bacteriana a largo plazo y el sistema
regresó a su estado original donde estaba antes de su aplicación.
- Población bacteriana total: El TBC medio de agua de estanque y sedimentos estuvo cerca o por encima de 6.0 log CFU/ml que sugiere una abundante disponibilidad de nutrientes en ambos sistemas. Durante el período de cultivo,
los valores de TBC observados estaban de acuerdo con estudios anteriores (Abraham et al., 2004, 2015; Patil et al., 2012). Rao et al. (2000) informó TBC de 3 log 1.40 a 4 log 3.40 CFU/ml en muestras de agua y 3 log 2.60 a 5 log 6.10 CFU/ ml en muestras de sedimentos.
La muestra de agua del estanque de tierra mostró el primer pico de 6 log 8.60 ± 1.15 CFU/ml en 23 DOC y posteriormente el segundo pico se observó en 104 DOC (6 log 8.37 ± 1,17 CFU/ml), mientras que el pico más alto en estanques forrados con geomembrana de polietileno se observó en 136 DOC (6 log 7,25 ± 2,05 CFU/ml). Después de aplicar cloro al agua del estanque y 5 días antes de la siembra de semillas (período de pre-siembra), el TBC fue de 6 log 0,53 ± 0,06 CFU/ ml y 6 log 3,73 ± 0,65 CFU/ml en estanques de tierra y forrados con geomembrana de polietileno, respectivamente. El uso de aireaciones altas podría ser la razón del alto crecimiento bacteriano (Fernandes et al., 2010).
Las muestras de sedimentos de estanques de tierra mostraron TBC ligeramente más alto que las muestras de agua, situación presentada también en informes anteriores (Abraham et al., 2004, 2015; Patil et al., 2012).

El recuento total de Vibrios presuntivos fue de 2 log 0,73 ± 0,05 CFU/ ml y 2 log 3,67 ± 0,98 CFU/ml en estanques de tierra y forrados con geomembrana de polietileno, respectivamente.
Al igual que con TBC, la mayor población de TVC en estanques forrados con geomembrana de polietileno también puede deberse a una mayor duración del tiempo de preparación inicial dado antes de la siembra, permitiendo la proliferación de Vibrio.
La alta carga de Vibrio en estanques forrados con geomembrana de polietileno durante todo el período de cultivo debe atribuirse a la mayor densidad de siembra
en estos estanques. Esto podría deberse al aumento constante de la acumulación de materia orgánica en el fondo del estanque (Moriarty, 1997; Sujatha, 2007) así como por la cantidad total de alimento por estanque en cada grupo (Grupo I –9,45 t y Grupo II – 10,35 t).
Es posible una alta cantidad de materia orgánica en estanques de cultivo de camarones debido a la alta densidad de siembra, sobrealimentación, alimento no consumido, acumulación de materia fecal, fertilizantes y crecimiento de la población de algas (Kautsky et al., 2000).
- Bacterias oxidantes de azufre (SOB) y bacterias que provocan sulfato (SRB):
El SOB y el SRB son importantes en la conversión de compuestos relacionados con el azufre y los compuestos relacionados con el azufre.
Las bacterias del ciclo del azufre que SOB y el SRB fueron significativamente más bajas (P < 0.01) en estanque forrado geomembrana de polietileno en comparación con estanques de tierra durante todo el período de cultivo indicando el papel del requisito de la necesidad de sustrato de tierra para la proliferación y el favorable para el crecimiento de esta bacteria (Abraham et al., 2004, 2015).

Las poblaciones de SOB y SRB fueron 4 log 1.44 ± 6.87 CFU/ml, 3 log 8.50 ± 2.17 CFU/ml y 3 log 0.58 ± 0.25 CFU/ml, 3 log 0.85 ± 0.22 CFU/ml, respectivamente, para estanques de tierra y forrados con geomembana de polietileno.
Los niveles de SOB y SRB en el presente estudio fueron de acuerdo con Patil et al. (2012), pero fueron mucho más bajos que los informes anteriores (Suplee y Cotner, 1996;
Los estanques con revestimiento de geomembrana de polietileno permiten una fácil eliminación de la carga orgánica, lo que permite mayores densidades de población y cosechas que los observados en estanques de tierra.
Rao et al., 2000). Sin embargo, Devaraja et al. (2002) y Abraham et al. (2004, 2015) reportaron conteos aún menores.
Los resultados del presente estudio reflejan la intensificación de las prácticas de cultivo y el efecto de la densidad de siembra. Los conteos de SOB en estanques de tierra disminuyeron hasta 70 DOC para después mostrar una tendencia creciente con un pico de 3 log 45.00 ± 16.46 CFU/ml en 172 DOC.
Un aumento drástico después de 70 DOC se observó que puede deberse a una mayor frecuencia de aplicación de probióticos del suelo y al efecto de la aeración.
Los recuentos de SOB en estanques forrados con geomembrana de polietileno mostraron una tendencia creciente de hasta 120 DOC con
un pico de 3 log 1.33 ± 0.21 CFU/ ml y caída al final del período de cultivo (DOC 136). Aunque los SRB se consideraban bacterias anaeróbicas, estaban presentes tanto en sedimentos del fondo del estanque como en la columna de agua. Los estudios anteriores de Rao et al. (2000), Devaraja et al. (2002) y Patil et al. (2012) también apoyaron las observaciones actuales. La posible razón de mayores recuentos de SRB en la columna de agua podría atribuirse a la creación de anaeróbicos en el centro de micro nichos debido a una mayor actividad de bacterias heterotróficas (Schramm et al., 1999).

Los recuentos de SRB en muestras de agua de estanques de tierra fueron casi estables hasta 85 DOC, aumentados drásticamente con un
pico de 172 DOC (4 log 2.53 ± 4.62 CFU/ml) indicando el deterioro del estanque en la segunda mitad del cultivo. Registró una drástica caída en 133 DOC y luego volvió a aumentar hasta el final del cultivo.
Una reducción significativa en los conteos de SRB coincide con la aplicación de probióticos del suelo. El papel de las aplicaciones de probióticos en la mejora de las condiciones del estanque es apoyado por varios investigadores (Devaraja et al., 2002; Patil et al., 2012; Abraham et al., 2015). Se observó una tendencia casi similar en los sedimentos de estanques, pero con conteos de SRB ligeramente más altos.
Una tendencia creciente de SRB en muestras de sedimentos de estanques de hasta 56 DOC tam-
bién apoya la asunción del deterioro de las condiciones del estanque y la caída en el conteo de SRB posterior, después de coincidir con la aplicación de probióticos del suelo.
El conteo de SRB en estanques forrados con geomembrana de polietileno aumentó hasta 59 DOC con un pico de 3 log 2.30 ± 0.70 CFU/ml y luego disminuyó, lo cual puede deberse por las aplicaciones de probióticos del suelo y eliminación regular de lodos. Además, las poblaciones de SRB en estanques forrados con geomembranas de polietileno se manejaron a través del intercambio regular de lodos de fondo utilizando el sistema central de drenaje, de lo contrario las poblaciones de SRB podrían haber superado en número a las poblaciones de SOB (Smith, 1998).
La acumulación de materia orgánica (lodos) conduce no sólo al aumento de la demanda de oxí-
geno del sedimento, sino también a condiciones anaeróbicas que resultan en la producción de gases indeseables como el sulfuro de hidrógeno. Para evitar estas condiciones desfavorables en el entorno del estanque, los lodos deben gestionarse removiéndolos en determinados momentos. Con la intensificación del cultivo, la acumulación de carga orgánica conduce al deterioro del medio ambiente que a su vez conducirá a un crecimiento y una sobrevivencia deficiente del animal cultivado (Prawitwilaikul et al., 2006).
Los estanques de forrados con geomembrana de polietileno proporcionan una fácil eliminación de la carga orgánica, permitiendo así realizar cultivos de mayor densidad y aumentando el número de cosechas por año, en comparación con los estanques de tierra.
Es importante estudiar la dinámica de este reciclaje de microorganismos y su comportamiento en los sistemas de cultivo en el contexto de la aplicación en producciones comerciales de gran escala. En el presente estudio, la densidad de población microbiana difiere significativamente con el tipo de sistema de cultivo a pesar de la densidad de siembra y se indica principalmente por la carga correspondiente de poblaciones bacterianas de ciclo del azufre.
También, las intervenciones a nivel de granja como la aplicación de probióticos juegan un papel significativo en el mantenimiento del ambiente de estanque más saludable. Otras investigaciones sobre el manejo de estas poblaciones a través de consorcios bacterianos adecuados y apropiados (formulaciones probióticas), su dosis y calendario de aplicación ayudarán a mejorar los requisitos de calidad del agua de los organismos cultivados en diferentes sistemas de cultivo.
*Esta es una versión divulgativa desarrollada por el equipo editorial de Panorama Acuícola Magazine del artículo “Role of pond lining in dynamics of sulfur recycling bacteria in Pacific White Shrimp, P. vannamei grow out culture ponds” publicado originalmente en el Journal Indian Comp. Microbiol. Immunol. Infect. Dis. Vol. 38 No. 2 (Julio-Diciembre), 2017: 85-91.

Las referencias utilizadas por los autores se encuentran disponibles bajo previa solicitud a nuestro departamento editorial.

El virus del lago de la tilapia (TiLV por sus siglas en inglés) causa una enfermedad viral emergente asociada con una alta mortalidad y daños económicos en el cultivo de esta especie en todo el mundo. El uso de probióticos se ha sugerido como una alternativa a los antibióticos y medicamentos para reducir el impacto negativo de las infecciones bacterianas y virales en la acuicultura. En este estudio desarrollado por investigadores de la Universidad Kasetsart y la Universidad Estatal de Michigan, se investigan los efectos de la suplementación del probiótico Bacillus spp. sobre la mortalidad, la carga viral y la expresión de genes relacionados con la inmunidad en la tilapia híbrida roja (Oreochromis spp.) tras la infección por TiLV. Esta es una versión resumida del artículo que destaca algunos de los principales resultados obtenidos.
probióticos modulan la resistencia y la respuesta inmune en la tilapia frente a la infección por el virus del lago de la Tilapia
La tilapia es la especie de producción en granja de mayor importancia económica en los sistemas de acuicultura en todo el mundo. En

2018, la producción mundial de tilapia se estimó en 6.8 millones de toneladas, lo que representa un valor económico de USD 11 mil millones. Aunque la tilapia puede
adaptarse y tolera condiciones de cultivo variables, los recientes brotes de enfermedades bacterianas y virales emergentes plantean graves amenazas para la producción

acuícola mundial de esta especie. Recientemente, el brote de una nueva enfermedad viral, causada por el virus del lago de la tilapia (TiLV), ha llamado la atención debido a la rapidez con que se propaga entre granjas y países.

El TiLV se identificó como un virus de ARN monocatenario de sentido negativo que comparte algunas características con otros virus de la familia Orthomyxoviridae. Posteriormente, el virus fue clasificado como una nueva especie (Tilapia tilapinevirus), en el género Tilapinevirus, pero en la familia Amnoonviridae. La mortalidad masiva de tilapia asociada con el TiLV se informa en muchos países en América del Norte, América del Sur, Asia y África. Todas las etapas del cultivo de tilapia, incluidos alevines, juveniles, adultos y reproductores, son susceptibles a la infección por TiLV, con una amplia gama de morbilidad y mortalidad
que va del 5 al 90%. Como no existe un tratamiento específico contra las infecciones por TiLV, prevenir o reducir el riesgo de infección es una medida de control importante para minimizar el impacto negativo
de esta enfermedad una vez que se espera que el virus ingrese al sistema de producción.
La aplicación de probióticos para reducir las infecciones bacterianas y virales en los peces se

Como no existe un tratamiento específico contra la infección por TiLV, la prevención o reducción del riesgo de infección son medidas de control importantes para minimizar el impacto negativo de esta enfermedad una vez que se espera que el virus ingrese al sistema de producción.
considera una estrategia alternativa para mejorar la salud de los organismos cultivados en granjas. Se han utilizado múltiples especies bacterianas para formular probióticos para la acuicultura, incluida una amplia gama de bacterias grampositivas, gramnegativas o levaduras, como Bacillus , Carnobacterium, Enterococcus, LactoBacillus, Vibrio, Pseudomonas y Saccharomyces cerevisiae . Entre estas, las bacterias del género Bacillus se aplican comúnmente como aditivos alimentarios debido a sus posibles beneficios para mejorar el crecimiento, promover la resistencia a las enfermedades y estimular la respuesta inmune del huésped. En la tilapia, se demostró que los probióticos de los extractos de Bacillus mejoran la resistencia contra Streptococcus agalactiae y Aeromonas hydrophila , dos bacterias comunes e importantes que plantean problemas de salud a la acuicultura mundial de tilapia.
Aunque los probióticos se han utilizado comúnmente en la acuicultura para controlar las infecciones bacterianas, estudios anteriores también indicaron los beneficios de la suplementación con probióticos en las dietas de peces de producción acuícola para mejorar el rendimiento del crecimiento y la resistencia a las infecciones víricas. Por ejemplo, el lenguado (Paralichthys olivaceus) alimentado con probióticos Lactobacil y Sporolac (Inter Care, India) mostró una mayor sobrevivencia contra el virus de la enfermedad linfocística (LCDV). De manera similar, el mero de manchas naranjas (Epinephelus coioides) alimentado con una dieta suplementada con probióticos durante 28 días tuvo una supervivencia superior al 50% durante la infección por iridovirus de mero (GIV) en comparación con los peces alimentados con la dieta de control. Actualmente, no existen medidas de control o vacunas disponibles contra la infección por TiLV en tilapia.
El objetivo de este estudio fue evaluar los efectos de la suplementación del probiótico Bacillus
spp. sobre la mortalidad, la carga viral y la expresión de genes relacionados con la inmunidad en la tilapia híbrida roja ( Oreochromis spp.) tras la infección por TiLV. Los resultados revelan que dicha suplementación dietética podría mejorar la supervivencia de los peces y fortalecer la respuesta antiviral ante la infección por TiLV. Por lo tanto, la administración de los probióticos Bacillus spp. podrían proporcionar una estrategia alternativa adecuada para mitigar las pérdidas causadas en el cultivo de tilapia por esta amenaza viral emergente.
Los probióticos Bacillus spp. mejoran la supervivencia de la tilapia contra la infección por TiLV
Durante el estudio de exposición, la infección por TiLV se obtuvo tras la cohabitación de tilapia roja inyectada con TiLV-IP con peces alimentados con dietas de control o probióticas. A los 3 días después de la exposición a la infección (dpc), los peces inyectados con IP comenzaron a desarrollar síntomas típicos de infección por TiLV, incluido letargo (en el fondo de los tanques) y hemorragias a lo largo de los costados del cuerpo y en la base de las aletas. A medida que avanzaba la patogenia, la mortalidad de los peces inyectados con IP comenzó a los 5 días, alcanzando una mortalidad acumulada del 96.57% (84.62% -100%), el experimento terminó a los 28 días.
Todas las tilapias rojas alimentadas con probióticos y dietas de control que cohabitaron con peces inyectados con IP mostraron signos clínicos de la infección por TiLV, comenzando a los 7 dpc. Además, la mortalidad en los grupos co habitados comenzó alos 9 dpc, y persisitió hasta los 20 dpc (ver Figura 1).
La mortalidad acumulada alcanzada en el grupo control fue del 32%, mientras que en los grupos alimentados de forma preventiva con dietas suplementadas con probióticos al 0.5% y al 1%, fue, respectivamente, del 25 y 24%. Ambos

Los resultados sobre la transcripción de marcadores proinflamatorios y antivirales indican que la suplementación dietética de probióticos Bacillus spp. al 1% mejoraron significativamente la defensa antiviral durante el curso de TiLV.

tratamientos con probióticos mejoraron significativamente la supervivencia de la tilapia roja sobre la infección por TiLV (p <0.05). No se observaron signos clínicos ni de mortalidad en el grupo sometido a la prueba simulada durante todo el estudio. Los parámetros de rendimiento de crecimiento evaluados, incluida la ganancia de peso, la ganancia diaria promedio, el índice de conversión alimenticia y la eficiencia alimenticia no cambiaron significativamente en todos los grupos experimentales (ver Tabla 1). Sin embargo, aunque el grupo de dieta suplementada con Bacillus spp. al 1% mostró la mayor ganancia de peso y el mejor índice de conversión alimenticia al final del experimento, no hubo significación estadística de estos valores entre los grupos de control y los de suplementación con probióticos.

Evaluación de carga viral diferencial
Aunque los signos clínicos de TiLV todavía no eran evidentes en el grupo de cohabitación cuando murió el primer pez inyectado con IP, a los 5 dpc, se detectó el ARN viral en el hígado, el bazo y la cabeza del riñon de todos los peces que cohabitaron. La carga viral alcanzó un máximo a los 9 dpc, con la carga más alta de 5.38, 5.19 y 5.09 log10 copias de TiLV / _g de ARN de TiLV total, respectivamente, en el hígado, el bazo y el riñón de los peces del grupo de dieta de control; a partir de entonces, las cargas virales disminuyeron gradualmente en todos los grupos desafiados con TiLV.
Estas cargas virales del grupo de dieta de control a 9 dpc fueron significativamente más altas que las de los grupos suplementados con probióticos, entre los cuales también se observó una diferencia significativa.
Modulación diferencial de los marcadores de respuesta antiviral durante la infección por TiLV
Durante la infección experimental con TiLV, se midió el perfil de expresión de genes que codifican
para citocinas antivirales y proinflamatorias en el hígado, el bazo y el riñón de los tres grupos de tratamiento con dietas.
En conjunto, los resultados sobre la transcripción de marcadores proinflamatorios y antivirales indican que la suplementación dietética de probióticos Bacillus spp. al 1% mejoraron significativamente la defensa antiviral durante el curso de TiLV.
Nota del equipo editorial: para ver los diferentes resultados obtenidos en la modulación de la transcripción de il-8 (CXCL8), irf-3 e ify-y, consulte el artículo original, citado y vinculado al final de este contenido.

El TiLV es un virus importante que causa morbilidad y mortalidad masivas en las poblaciones de tilapia silvestres y cultivadas en todo el mundo. Por lo tanto, existe una necesidad urgente de prevenir y controlar la enfermedad por TiLV, especialmente donde la tilapia se cultiva intensamente. Aún no se dispone de una terapia o vacuna eficaz para proteger a la tilapia de la infección por TiLV. Los probióticos se han utilizado ampliamente en humanos y animales de granja para promover la salud general y se


han aplicado con éxito como alternativas a los antibióticos. Incluso en los peces, varios informes han demostrado que la administración dietética de probióticos, incluidas bacterias vivas y extractos de bacterias, podría promover la salud. Los probióticos pueden mejorar el rendimiento de los peces, modular la actividad de las enzimas digestivas y antioxidantes y fortalecer la respuesta inmune innata mediante la modulación de citocinas, células inmunes innatas y la expresión de genes que codifican efectos de defensa naturales.
Además, los probióticos pueden tener efectos antagonistas contra microorganismos patógenos en peces, como se muestra al usar Pdp11 y 51M6 (Vibrionaceae) contra Vibrio harveyi. En el caso de Bacillus spp. éste mostró actividad antagónica contra V. vulnificus, V. campbelli, V. parahaemolyticus y V. alginolyticus promoviendo el crecimiento del camarón blanco (Litopenaeus vannamei)
Sin embargo, hasta hace poco, ninguna investigación había demostrado la aplicación de probióticos para reducir el impacto de la infección por TiLV en la tilapia. Según el conocimiento de los autores al momento de esta publicación, este estudio es el primero en evaluar el potencial de Bacillus spp. como suplemento de probióticos en la dieta de los peces y sus características beneficiosas para la salud de la tilapia durante la infección por TiLV.
Durante el estudio en tilapia híbrida roja, a pesar de que se encontró un hallazgo positivo en el aumento de peso, junto con una tasa de conversión alimenticia (FCR) más baja en el grupo suplementado con probióticos al 1%, el análisis estadístico no mostró diferencias en la administración dietética de Bacillus spp. hacia la mejora de los parámetros de crecimiento.
Hallazgos similares sugieren que la tilapia del Nilo (O. niloticus) alimentada con probióticos tuvo efectos insignificantes en la mejora del FCR y el aumento de peso durante las pruebas de alimentación. Por el contrario, se informó un efecto positivo de la suplementación con probióticos para promover el rendimiento del crecimiento en los peces. Las dietas suplementadas

con Lacto Bacillus acidophilus y Bacillus subtilis durante 8 semanas promovieron el crecimiento de la tilapia del Nilo, aumentaron su peso final y dieron como resultado un FCR más bajo. Además, la suplementación dietética con B. cereus var. toyoi durante 93 días mejoró el rendimiento de crecimiento de la trucha arcoíris de cultivo (Oncorhynchus mykiss). La aplicación de 1 × 105 y 1 × 106 UFC
/ g de B. licheniformis en la alimentación mejoró los parámetros de crecimiento en la carpa herbívora (Ctenopharyngodon idella) después de 56 días. Por lo tanto, planteamos la hipótesis de que un mejor impacto de los probióticos Bacillus spp. sobre el rendimiento de crecimiento de la tilapia roja podrían haberse demostrado si se hubieran suplementado la alimentación con los probióticos durante más tiempo.
Curiosamente, la suplementación dietética con Bacillus spp. redujo significativamente la carga viral de TiLV en los órganos internos, incluidos el hígado, el bazo y el riñón de la tilapia roja. Este hallazgo puede ser parte de la explicación de la mejor supervivencia de los peces alimentados con probióticos Bacillus spp. En estudios anteriores se encontró que Bacillus spp. tuvo la capacidad de

inhibir una variedad de patógenos, incluidos V. vulnificus, V. alginolyticus, A. hydrophila. La suplementación dietética con B. megeterium redujo la carga viral en camarones durante la infección por el virus del síndrome de la mancha blanca (WSSV). Liu et al. demostrarin que cepas de Bacillus spp. aislado de diferentes animales acuáticos tuvo fuertes efectos inhibidores contra V. parahaemolyticus
En este estudio, se encontró una menor mortalidad durante la infección por TiLV en tilapias alimentadas con dietas suplementadas con 0.5% y 1% de Bacillus spp., en comparación con el grupo de dieta de control. Hasta donde sabemos, el presente estudio es el primer informe del efecto de probiótico de Bacillus spp. contra la infección por TiLV.
En resumen, nuestro estudio demuestra que una administración oral de Bacillus spp. puede tener efectos antivirales beneficiosos contra la infección por TiLV en tilapia híbrida roja. La administración oral preventiva de una dieta probiótica aumentó la supervivencia de la tilapia tras la infección por TiLV. La respuesta inmune innata del huésped mejoró, como lo indica el aumento constante de la transcripción de una quimiocina proinflamatoria y marcadores antivirales en los grupos suplementados con probióticos, y con un efecto mayor en el grupo que fue suplementado con 1% de probióticos Bacillus spp. Este estudio piloto informará la adopción de estrategias de prevención dirigidas al control de las infecciones por TiLV, abriendo el camino a más estudios futuros sobre el manejo de la salud en el cultivo de tilapia utilizando probióticos para fortalecer la inmunidad contra la presencia del TiLV y otros agentes infecciosos relevantes.
* Esta es una versión divulgativa desarrollada por el equipo editorial de Panorama Acuícola Magazine del artículo “Probiotics Modulate Tilapia Resistance and Immune Response against Tilapia Lake Virus Infection”, escrito por: Pitchaporn Waiyamitra, Mehmet Arif Zoral, Aksorn Saengtienchai, Amorn Luengnaruemitchai, Olivier Decamp, Bartolomeo Gorgoglione y Win Surachetpong. Este artículo se publicó originalmente en noviembre de 2020 en la revista Pathogens Journal de la plataforma MDPI. La versión completa de este artículo se puede encontrar en línea através de esta referencia doi:10.3390/ pathogens9110919
Correo electrónico de correspondencia: fvetwsp@ku.ac.th
Las referencias citadas por los autores en el artículo están disponibles previa solicitud a nuestro equipo editorial.
Todos los productores se pueden beneficiar del uso de tecnología de ADN en sus programas de reproducción acuícola. El nivel de beneficio y el tipo de retorno de la inversión dependerán de la herramienta utilizada, ya sea de baja densidad (LD), media densidad (MD) o alta densidad (HD). Independientemente de la herramienta, la aplicación de la tecnología de ADN agrega precisión a la decisión en la selección de organismos reproductores de una especie. En este artículo se analizan las 3 herramientas principales (genómica y bioinformática) en las que cualquier acuicultor debería considerar invertir.
Por: Dra. Elisa Marques * Directora de Desarrollo de Negocios en el Centro de Tecnologías de la Acuicultura (CAT)La industria de la acuicultura está lista para la adopción de tecnologías basadas en el ADN, también conocidas como genómica. El sector ha sido testigo y, por lo tanto, ha aprendido lecciones del uso de estas herramientas en la industria ganadera, donde se aplican en gran medida y las ganancias genéticas ya no son simulaciones en una pantalla de computadora.
En la actualidad muchos acuicultores tienen preguntas y buscan orientación para mejorar su genética, por lo que este artículo les será de gran interés. Pero antes de seguir
adelante con mis recomendaciones, quiero enfatizar que el uso de la genómica no hará desaparecer la necesidad de recolectar fenotipos o la necesidad de mejorar un sistema de manejo.
En términos económicos los rasgos más importantes en los organismos son de naturaleza compleja, lo que significa que parte de su resultado se origina en las mejoras genéticas, a través de la observación de rasgos medibles y otros registros de reproducción; y parte de las mejoras se da a través del manejo (es decir, salud, nutrición), por lo que invertir en uno mientras que se hace caso
omiso del otro definitivamente no resolverá todos sus problemas.
La genómica es solo una herramienta en la caja y no reemplaza las buenas prácticas de manejo y el compromiso en todos los niveles de una organización para apoyar el programa de mejoramiento genético.
La diferencia entre genética y genómica
Permítanme primero hacer la distinción entre los términos “genética” y “genómica”. Son términos diferentes, pero que se complementan cuando hablamos de un programa


Una herramienta genómica solo será tan buena como su eslabón más débil. Por lo tanto, si aún no lo ha hecho, llegará el momento en que necesite actualizar su programa de gestión (es decir, invertir en una mejor alimentación, controlar los patógenos, comprar tanques más grandes o una mayor cantidad de ellos, modificar su diseño del sistema de producción).
de cría. Un vendedor de reproductores dirá: “Vendo genética”. Un genetista hablará de la genética en términos de mérito genético (valores genéticos). Diferentes roles, diferentes definiciones pero todas correctas, a su manera.
La genómica, por otro lado, es un término asociado con la estructura del ADN (es decir, las bases: As, Ts, Cs y Gs), y las herramientas que nos permiten perfilar el ADN se definen como herramientas genómicas. Todos los productores se pueden beneficiar del uso de tecnología de ADN en su programa de reproducción. El nivel de beneficio y el tipo de retorno de la inversión dependerán de la herramienta que utilicen, ya sea de baja densidad (LD), media densidad (MD) o alta densidad (HD). Independientemente de la herramienta, la aplicación de la tecnología de ADN agrega precisión a la decisión de selección.
El tipo de herramienta a utilizar es una función de cómo los productores han estructurado sus programas de mejoramiento, por ejemplo, si han estado recolectando fenotipos y manteniendo registros
de reproducción. A continuación se muestran las 3 herramientas principales (de las áreas de genómica y bioinformática) en las que cualquier productor de acuicultura debería considerar invertir.
Top 3 de herramientas de genómica AquaArray:
1. Baja densidad (LD): para aquellos que se sumergen en la genómica sin saber qué poblaciones tienen (es decir, especies o cepas), recomendamos un panel con menos de 200 SNP. Este proporciona información sobre la arquitectura genética de la población y una base para la relación y la endogamia. Este tipo de panel también permite realizar pruebas de paternidad, un paso importante en el cálculo de los EBV (valores genéticos estimados), que es otra forma de decir mérito genético. Cada especie tiene su propio panel LD.
2. Densidad media (MD): si ha estado invirtiendo en genotipado de alta densidad (HD) (ver más abajo) durante un tiempo y tiene un conocimiento sólido de cómo está
estructurada su población, entonces debe comenzar a pensar en un panel de densidad media que pueda imputarse a su conjunto de datos HD para ahorrar costos y mantener la precisión.
3. Alta densidad (HD): la herramienta más poderosa para un programa de mejora genética de alta velocidad y aceleración. Estos paneles tienen alrededor de 50,000 marcadores y se pueden utilizar para pruebas de parentesco, selección genómica, selección asistida por marcadores, etc. Los productores que han estado y están comprometidos con la recopilación de datos fenotípicos están en el punto óptimo para el uso de esta herramienta HD.
bioinformática:
Las herramientas de bioinformática brindan información procesable necesaria para avanzar y, sin ellas, las herramientas que enumeré anteriormente son sólo un montón de A, T, C y G. A continuación se muestra una lista de análisis y aplicaciones provenientes de estas herramientas genómicas.

1. Un análisis general genético (GO): un análisis poderoso que proporciona información sobre la diversidad y el nivel de endogamia entre los animales de una población. Cuando se combina con un análisis de identificación de cepas, permite la diferenciación entre los animales utilizados en diferentes sistemas de producción y mercados. Por ejemplo, tilapia (del Nilo contra Mozambique).
2. Análisis de parentesco: este análisis define el pedigrí de sus animales y es, después de haber recopilado datos fenotípicos, el primer paso para el cálculo de los EBV (méritos genéticos). Requiere muestras de los reproductores y su progenie.
3. Selección genómica: en esta etapa, la información del pedigrí y los datos fenotípicos se han recopilado durante muchas generaciones. Aquí asignamos un valor (+ o -) para cada uno de los miles de marcadores obtenidos del panel HD SNP, y esa información luego se agrega a la evaluación genética. Es posible que haya oído hablar del término GE-EBV (valores estimados de reproducción genómicos-mejo-
rados). Esta es una estimación más precisa del mérito genético debido al poder agregado por la información del ADN.
Una vez que haya decidido qué herramienta de genómica se adapta mejor a sus necesidades (o también puede enviarnos un correo electrónico a info@aquatechcenter. com para discutir más a detalle esta decisión) es hora de recolectar una muestra biológica. Este paso no se puede ignorar, y un paso en falso aquí a menudo puede significar un rendimiento de ADN de baja calidad y, por lo tanto, ningún resultado. Los clips de aleta (para peces de aleta) o pleópodos (para camarones) son una gran fuente de ADN. Nosotros nos encargamos de guiar a nuestros clientes durante la recolección y envío de muestras para asegurarnos de generar resultados que puedan utilizar.
¿Cuál es el eslabón más débil? Una herramienta genómica solo será tan buena como su eslabón más débil. Por lo tanto, si aún no lo ha hecho, llegará el momento en que necesite actualizar su programa
de gestión (es decir, invertir en una mejor alimentación, controlar los patógenos, comprar tanques más grandes o una mayor cantidad de ellos, modificar su diseño del sistema de producción). Para decirlo en términos sencillos, no espere llegar a la meta colocando neumáticos Porsche (herramienta HD) en su Volkswagen Beetle.
Si su eslabón más débil en este momento es la detección y el monitoreo de patógenos, la mejor manera es acoplar una de las herramientas genómicas anteriores (LD, MD o HD) con un panel para la detección de patógenos donde puede elegir qué patógeno probar. Es posible que no los necesite todos, por lo que es importante que tenga una opción a la carta en lugar de un buffet de “todo lo que pueda comer”.

Y, si nota que necesita ayuda en varios niveles de su negocio (salud, nutrición, genética, genómica), un contrato de cría anual que incluya recomendaciones personalizadas probablemente le sirva mejor, y hay profesionales calificados para ayudar a los nuevos participantes. ¡Revise bien todas sus opciones para elegir correctamente!
*La Dra. Elisa Marques ha pasado los últimos 15 años aplicando vigorosamente herramientas genómicas en programas de mejora genética en América del Norte y del Sur. Actualmente ocupa el puesto de Directora de Desarrollo de Negocios en el Centro de Tecnologías de la Acuicultura (CAT), la organización de I + D por contrato que proporciona soluciones innovadoras en salud, nutrición y mejora genética de especies acuáticas.
Para obtener más información, visite: https://aquatechcenter.com/

La cadena de producción del langostino malayo (M.rosenbergii) en el sureste de México se encuentra en marcha, existen los eslabones necesarios y la red de valor disponible para tener logros como los que se exponen en este artículo. Es necesaria la mayor participación de la sociedad de acuicultores para involucrarse en la actividad de manera que el mercado pueda tener una oferta del producto que permita responder a la demanda existente.
Se ha concretado el ciclo del langostino malayo en el sureste de México, gracias a la participación de todos los actores de la cadena productiva y la red de valor. A la fecha contamos con la participación de los eslabones de producción de postlarva, engordadores y comercializadores. El jueves 21 de enero 2021 en el ciclo de conferencias denominada “La mesa de eviscerado” de Todo acuícola (Urselay, et al., 2021), participaron tres ponentes referente al tema, el Dr. Juan Lorenzo Reta Mendiola detallando la información técnica y biológica para lograr la producción de postlarva (PL), ubicado en el estado de Veracruz, la participación del C. Jorge Ignacio Peláez Pier exponiendo la experiencia de engorda y comercialización del langostino malayo y el Oceanólogo Juan Ramiro Martínez Rangel una remembranza del cultivo en el estado de Sinaloa. Se pudo observar los detalles que a continuación se describen como importantes en cada uno de los eslabones.

El primer eslabón de la cadena de producción es el manejo de reproductores, es importante tener reproductores jóvenes de ser posible de no más de un año de vida, las hembras deben ser de segundo
ciclo, es decir verificar que no sea el primer huevo que producen en su vida útil como reproductores, de preferencia de más de 30 g. En caso de que el productor de postlarva no cuente con estanques de engorda del cual pueda extraer reproductores, debe hacer una alianza estratégica con sus compradores de PL, y obtener de sus estanques de engorda, adultos maduros con las carteristas descritas. De esta manera se puede tener conocimiento de la edad y proveniencia de los langostinos adultos seleccionados. Con esta
metodología se podrá en un futuro próximo diseñar un sistema de control de la herencia genética deseable (Reta-Mendiola, et al., 2019). Los langostinos reproductores son seleccionado y colocados en piletas circulares, en una proporción de 5 hembras por macho. Los machos deben ser machos jóvenes de quelas azules. No se deben colocar machos de quelas naranja, ni de quelas blancas, si bien estos langostinos son capaces de fecundar los huevos de las hembras disponibles, no es deseable que las fecunden pues se
M.rosenbergii en la región sureste de
Una experiencia que concreta la cadena productiva y estimula la red de valorFigura 1. Unidad de producción de postlarvas de langostino, Santafé Veracruz México.

La cadena de producción del langostino malayo (M.rosenbergii) en el sureste de México se encuentra en marcha, existen los eslabones necesarios y la red de valor disponible para tener logros como el aquí expuesto.
pierde el control de progenitores. En el estanque de reproducción se deben colocar refugios para permitir que los langostinos que muden tengan oportunidad de protegerse de las agresiones en su estado vulnerable. También es recomendable usar sustratos para reproducción, se ha observado que en mallas tipo arpilla colocadas en el estanque, el macho dominante mantiene a sus hebras cercanas y llegan al depósito del esperamatoforo en las hembras.
Los ciclos son periódicos aproximadamente cada 15 días, y coinciden con la presencia de luna llena y también con la influencia de la lluvia, y se han observado hembras con huevo fértil durante todos los meses del año.
Las hembras ovígeras se colocan en maternidades que en este caso son tinas de 70 litros de agua salobre a 9ppm con un sistema de aireación. Se alimentan diariamente de peces pequeños (Poecilia spp). Las hembras permanecen ahí hasta la eclosión del huevo, y es cuando son removidas y regresan al estanque de reproductores. Las larvas son trasladadas a estanques circulares de 1m3 (Figura 1). Estos sistemas constan de un filtro biológico, sistema de aireación, y control de temperatura, con la finalidad de mantener la óptima calidad del agua. Los estadios larvales son 11 y suceden en un periodo de 30 días. Durante este periodo se alimentan de Artemia salina y se complementa con un flan elaborado a base de pescado, huevo de gallina, harina de trigo, aceite de hígado de bacalao y complementos minerales y vitamínicos; todos estos ingredientes son conseguidos en el mercado local.

Si se logran sincronizar las hembras, en un estanque de larvas se pueden juntar el producto de tres hembras, es decir 90 000 larvas aproximadamente, bajo esta circunstancia se han llegado a producir 16 000 postlarvas por estanque.
Las postlarvas de 30 días (PL30) fueron transportadas al estado de Quintana Roo a la empresa
Acuacultura el Caribe sur SPR de RL, en donde tuvieron una etapa de pre-engorda, en estanque circulares de concreto y refugios, ahí se mantuvieron durante 74 días, hasta logar 5.6 g en promedio, siendo alimentados con alimento elaborado in situ con FCA de 1.1, la ganancia de peso fue de 0.5 g por semana y una sobrevivencia fue del 70.3%.
La calidad del agua se mantuvo en óptimas condiciones con sistemas de aireación y suministro de agua para compensar evaporación.
La engorda se llevó a cabo en estanques rústicos rectangulares de 1,400 m2 durante 131 días del 5 de septiembre de 2020 al 13 de enero 2021, en el cual las condiciones de temperatura fluctuaron entre las temporadas de otoño e invierno, en la primera se mantuvo arriba de 30oC, y en la segunda a 25oC. en promedio, llegando en ocasiones a bajar hasta los 22oC. Se utilizó un
alimento comercial para engorda de camarón complementado con vísceras de pescado con un FCA de 1.78, suministrado en una dosis diaria por la tarde. El crecimiento de los langostinos en estas condiciones resulto en una velocidad de crecimiento de 2.69 g a la semana y tuvieron una sobrevivencia de 60.3%. La calidad del agua se mantuvo en rangos permisibles para la especie con la eventualidad de la disminución del oxígeno disuelto en una ocasión a 1 ppm debido a problemas técnicos.
El crecimiento promedio fue de 60 g., los machos presentaron una mayor talla llegando a un promedio de 75 g y las hembras de 32 g., la proporción machos:hembras final fue de 53% machos 46% hembras.
El costo de producción fue de $160.00 kg., considerando en los costos de operación alimento, energía eléctrica, mano de obra, agua, y postlarvas. El producto se vendió al menudeo por kg., en la plaza de Cancún Quintana Roo, consiguiendo un precio de $500.00 Kg., obteniendo una utilidad de $340.00 kg.
En conclusión, la cadena de producción del langostino malayo (M. rosenbergii) en el sureste de México se encuentra en marcha, existen los eslabones necesarios y la red de valor disponible para tener logros como el aquí expuesto. Es necesaria la mayor participación de la sociedad de acuicultores para involucrarse en la actividad de manera que el mercado pueda tener una oferta del producto que permita responder a la demanda existente. También de la participación de instituciones de investigación y desarrollo que esclarezcan las limitantes que se perciben en términos de hacer más eficiente el cultivo. Existe una vasta cantidad de literatura a nivel internacional especializada sobre cómo llevar acabo el cultivo (New, 2020), no obstante, la práctica regional, es la experiencia que hace crecer los negocios.


*Juan Lorenzo Reta Mendiola1, Jorge Ignacio Peláez Pier2, Alberto Asiain Hoyos1, Benigno Fernández. 1 Colegio de Postgraduados, 2 Acuacultura el Caribe Sur SPR de RL, 3 Acuacultores Veracruzanos A.C.
Referencias utilizadas por los autores en la elaboración del artículo, disponibles bajo previa solicitud.
Email de contacto: jretam@colpos.mx
La Tilapia es una de las especies más importantes de peces cultivados de acuicultura de agua dulce en el mundo, y en los últimos años, enfermedades ocasionadas por Streptococcus agalactiae y Franscisella noatuniensis se tornaron un reto muy importante para los productores que tuvieron pérdidas masivas en su producción.

Debido a que es ampliamente producida, los avances del conocimiento científico con esta especie son claros. Así, se han realizado varios estudios para establecer las necesidades nutricionales de los más variados nutrientes para la especie. Los requisitos nutricionales de la tilapia varían según diferentes factores como linaje, sexo, entorno de cría, condiciones experimentales, salud, nivel de energía y nutrientes de alimentación.

Dicho eso, la inmunidad intestinal en animales acuáticos está menos desarrollada que en los mamíferos, sin embargo, dicha inmunidad se atribuye a la salud de las barreras intestinales, que contienen células epiteliales esenciales para la inmunidad de la mucosa intestinal que, a su vez, es vital durante los brotes de enfermedades.
Un adecuado manejo nutricional es imprescindible para asegurar la rentabilidad de la producción acuícola, y hacer frente a enfermedades, superar las condiciones de estrés, y disminuir la dependencia del uso de antibióticos. Estas prácticas acuícolas responsables deben ser adap-
tadas como estrategia siempre que se desee producir de manera sostenible. Es recomendado el uso de dietas funcionales en programas de alimentación de peces y camarones para garantizar el mejor crecimiento y sobrevivencias de los animales que resulten en la rentabilidad de los negocios.
El uso de “nutrientes/aditivos” funcionales creció mucho en los últimos años, y esto se debe no sólo a la necesidad de reemplazar los antibióticos que promueven el crecimiento, sino a que cada vez más se estudian, entienden y aceptan nuevos conceptos relacionados.
En la última década diversos aditivos nutricionales han sido investigados como herramientas que pueden aportar al sistema inmunológico, entre ellos nucleótidos exógenos de origen de levaduras. Los nucleótidos y nucleótidos libres pueden
ser absorbidos inmediatamente por enterocitos en el intestino y son especialmente importantes en tejidos de rápida multiplicación celular y capacidad limitada de síntesis a través de novo (vía principal de producción de nucleótidos), como células sanguíneas, hepatocitos y células del sistema inmunitario.
Los nucleótidos son compuestos intracelulares de bajo peso molecular, que desempeñan un papel clave en varios procesos bioquímicos y cumplen numerosas funciones fisiológicas y bioquímicas esenciales, incluyendo la codificación de información genética, la mediación del metabolismo energético y la señalización celular; también son componentes de coenzimas, agentes alostéricos y agonistas celulares, y por eso, hoy ya se puede decir que son nutrientes esenciales en dietas de peces y camarones.
Los efectos moduladores de los nucleótidos, añadidos en las dietas, se han notificado en diversas espe-
los nucleótidos
desarrollo
tracto
¿Podemos mejorar el desarrollo del tracto intestinal y la función inmune de juveniles de tilapias nilóticas a través de la utilización de aditivos?
La respuesta es sí.
cies de organismos acuáticos además de los terrestres y están implicados en los procesos de maduración, activación y proliferación de linfocitos, fagocitosis por macrófagos, aumento de inmunoglobulinas, modulación de la microbiota intestinal y expresión genética de citoquinas. Cada vez hay más evidencias de que los nucleótidos suministrados por vía alimentaria son capaces de modificar la respuesta inmune, crecimiento, salud intestinal y hacer encontrar el mejor balance microbiano intestinal.
La proliferación celular, imperativa para la vida de todos los organismos y fundamental para sus funciones biológicas, depende totalmente de los nucleótidos. Para que una sola célula se divida, se requieren aproximadamente tres mil millones
de nucleótidos. Además, los nucleótidos tienen varias tareas moleculares en la señalización celular, metabolismo y manejo de energía en cada organismo.
Un estudio realizado en la Universidad Federal de Santa Catarina ha evaluado la respuesta de juveniles de tilapias Oreochromis niloticus alimentadas con una dieta funcional conteniendo diferentes niveles de inclusión con Premix de Salud (β-glucanos, nucleótidos, ácido ascórbico y α-tocoferol) en el rendimiento zootécnico, parámetros hematoimmunológicos, histomorfometria y microbiota intestinal.

En el estudio, 360 juveniles de tilapia con tamaño inicial de 1,88g (± 0,25g) fueran estocadas en 24 estanques de 100 L. Las dietas experimentales fueron con presencia o no del Premio de Salud en la concentración de 4% en las dietas por 50 días.

Los resultados fueron contundentes sobre la utilización del complejo inmunoestimulante. La suplementación con complejo inmunoestimulante mejoro los parámetros zootécnicos, la morfología intestinal (ver Figura 1), parámetros inmunológicos y hasta los microbiológicos.
Un ejemplo es el aumento de las células caliciformes que también desempeñan un papel fun-
damental en la protección de las barreras intestinales a través de la producción del moco, así como la secreción de proteínas antimicrobianas, quinonas y citoquinas que estimulan la inmunidad local intestinal y protegen las barreras contra patógenos.


Es importante notar que estas alteraciones muestran una naturaleza beneficiosa a las características morfológicas del tracto intestinal, promoviendo un aumento en la superficie para la absorción en la mucosa del tracto intestinal de las tilapias alimentadas con el Premix de Salud. Estos datos, fueron al encuentro de los resultados zootécnicos (ver Figura 2).
La presencia del complejo inmunoestimulante afectó el peso final, el aumento de peso diario y hasta la eficiencia alimentar de los peces que recibieron el complejo con nucleótidos. El rendimiento obtenido por los peces alimentados con el complejo de nucleótidos e inmunoestimulantes confirmó como componente activo y súper importante para las mejoras observadas. Este patrón fue consistente con el del rendimiento del crecimiento y la utilización de los alimentos, lo que implica que la mejora del crecimiento del intestino puede contribuir a la digestión y absorción de nutrientes y, por lo tanto, al crecimiento de los peces.
Combinado con el rendimiento del crecimiento, la eficiencia alimentar y el crecimiento intestinal, la inmunidad también ha sido afectada por su la inclusión de un Premix de Salud (ver Tabla 1). La adición de la Premix de Salud en las dietas promovió a un nivel óptimo los parámetros de salud inmunológicos de los peces. Por lo tanto, la suplementación con nucleótidos dietéticos tiene el potencial de conducir a
una mayor respuesta de anticuerpos de la tilapia.

Otro dato contundente es que la suplementación con la Premix de Salud ejerció una influencia moderada en el microbiota intestinal de las tilapias, con aumento significativo en la diversidad microbiana en comparación al grupo control (ver Figura 3).


Con todo lo encontrado, se empieza hoy a trazar un ideal de utilización de estos aditivos, casi que obligatorios en la alimentación de peces y camarones. Existe una interacción entre la inmunidad local del intestino y su microbiota, que se llama mutualismo y que puede sí interferir en cómo estos animales van a enfrentar los patógenos y sus efectos secundarios en la disbiosis de la comunidad del tracto intestinal. Existe una relacion direta entre nutricón y salud intestinal. Existe una relación directa entre nutrición y salud intestinal que debe ser explorada a través del uso de
aditivos y dietas funcionales para asegurar la sostenibilidad de la acuicultura.
La inmunidad intestinal es un factor significativo en el mantenimiento de la salud general de los animales acuáticos. Las modernas técnicas moleculares han ayudado a revelar las interacciones microbianas y sus cambios en relación con lo ingerido, y sumado a eso, con la interpretación de los datos histomorfométricos del tracto intestinal se ve claramente la activación de células epiteliales que reflejan cambios de crecimiento zootécnicos. Además, la determinación de los factores nutricionales que pueden activar o suprimir el microbiota del tracto intestinal ayuda en la disposición de los planes nutricionales a través de las diferentes etapas de vida y desafíos que los animales acuáticos van a enfrentar durante el ciclo de producción.
Referencias consultadas en la elaboración del artículo, disponibles bajo previa solicitud a nuestro departamento editorial.


En IOSA nos damos a la tarea contar con equipos para los procesos productivos en las granjas camaroneras, y así ofrecer más que sólo máquinas, sino la garantía de que el productor pueda aumentar sus ganancias, y que sus ciclos de cultivos sean más rentables.
Por: IOSA de los Mochis *
El término tecnificación referencia al uso de máqui nas en la producción, con objeto de emplear menos tiempo y esfuerzo, proveer de recur sos técnicos a una actividad determi nada para mejorarla o modernizarla. Los beneficios directos de la tecni ficación son mayor productividad y mayores ingresos.
Este incremento de los ingresos se deriva del aumento de la produc ción, el esperado descenso de los costos, mejoramiento de la compe titividad, apertura de nuevos mer cados, y en consecuencia un mayor prestigio del productor.
En las granjas acuícolas se llevan a cabo varios procesos productivos para los cuales IOSA cuenta con equipos que permiten cumplir con dichos procesos de manera eficiente, tales como: mezclado de alimento, alimentación, aireación, transferencia y cosecha. A continuación, se descri be cada uno de estos procesos y la tecnificación que aplica a cada uno de ellos.

vado
¿Por qué se aditiva el alimen to? En algunas granjas acuícolas se aditiva el alimento para el fortaleci miento del crustáceo con; vitaminas, antibiótico, probióticos, entre otros. Con el fin de fortalecer el organismo
marino, detener enfermedades y básicamente continuar el ciclo con la mayor sobrevivencia posible y así lograr un cultivo más rentable.
IOSA cuenta con una mezcladora de alimento que hace más eficiente este proceso y es un equipo único en el mercado que genera una mezcla totalmente homogénea en 90 segundos en cargas de 650 kg a 1000 kg. Para este proceso se necesitan dos personas y es de muy fácil operación.
El proceso de alimentación es uno de los más importantes, si no es que el más importante de la producción acuícola, ya que representa entre el 60% y el 70% del gasto dentro de una granja. IOSA cuenta con dos equipos de alimentación para este proceso que se describen a continuación:
El primero es la alimentadora de bordo, equipo fabricado en aluminio grado marino que tiene una capacidad en su tolva de 450 kg, la distancia de lanzamiento de alimento es de hasta 30 metros Cuenta con un codo giratorio de 180 grados para poder alimentar a los dos lados de su ubicación. Su beneficio principal es la reducción en el tiempo de alimentación ya que la alimentadora de bordo puede alimentar hasta 250 hectáreas en 2 horas.
Otro de los equipos de IOSA para el proceso de alimentación es la alimentadora flotante, un equipo desarrollado especialmente para estanques o piscinas de dimensiones muy grandes o de formas irregulares. Es de fácil instalación y se adapta sobre la panga o bote que se usan para alimentar regularmente en las producciones.

Para el proceso de aireación en las granjas acuícolas IOSA maneja cuenta con el equipo de aireación PAS PALAS que se compone de paletas en forma de helicoide. Este equipo hace el proceso de aireación más seguro y lo lleva a cabo de manera más eficiente ya que un solo equipo entrega 2.5 kg 02/h, comparado con otros del mismo caballaje que entregan al estanque 1.9 kg 02/h. Es decir su rendimiento es hasta 24% más eficiente que los demás.
Uno solo de estos equipos de aireación de 2HP, puede oxigenar hasta 1250 kg de biomasa de camarón. ¿Qué distingue a esta máquina de otros aireadores? Sus palas triangulares de nylon, los flotadores en polietileno con protección UV, el ensamble libre de tornillería y motor eléctrico WEG eficiencia Premium.


¿Porque manejar fases de cría y transferir organismos marinos? En el caso del cultivo de camarón este proceso ayuda a reducir la mortandad final de la cosecha al sembrar animales más grandes en la fase de engorde. Así mismo, ayuda a mejorar la tasa de crecimiento por efecto compensatorio de mayor a menor densidad por m2. También incide en mejores características físico-químicas del agua (alcalinidad, PH, 02, turbidez, etcétera). Fomenta una mejor conversión alimenticia (sobrevivencia y crecimiento lineal) así como una mayor rentabilidad hectárea/ año.
Para este proceso, IOSA cuenta con un equipo integrado por un impulsor de 8 pulgadas especial para transferir organismos desde 250 mg en adelante.
Dicho equipo está diseñado para poder hacer transferencias hasta de 3 km de distancia, sin dañar al organismo marino y sin que éste sea estresado. Cabe resaltar que este equipo de IOSA es DUPLEX o multipropósito ya que es de cosecha y transferencia.
Todos los procesos anteriores son necesarios en la producción del camarón para tener un cultivo rentable y satisfactorio, pero todas estas actividades desembocan en el proceso de cosecha. Todo el esfuerzo y la inversión económica llegan hasta este punto del cultivo que es de gran relevancia y en el que los métodos artesanales presentan varias deficiencias, ya que en el proceso el organismo marino es pisado, golpeado, estresado, descabezado, lo que provoca un alto porcentaje de merma en la cosecha, así como un gran costo en mano de obra e incluso complicaciones al trabajar con personal. Para atender esta situación en el sector, IOSA cuenta con un equipo de cosecha que como ya se mencionó anteriormente es multipropósito ya que también cuenta con la función de transferencia
El beneficio principal de la cosechadora es extraer todo el camarón que se encuentra en el estanque sin producir merma alguna, aumentando las ganancias, así como los puntos de calidad del producto. Su impulsor totalmente liso es el corazón de la máquina y la vuelve un equipo 100% confiable como ninguno otro.
Está fabricado en aluminio grado marino, tiene una capacidad de 36,000 libras por hora, cuenta con un doble sistema de enfriamiento para el sistema hidráulico para evitar calentamientos, lo que aumenta la vida de sus componentes de manera significativa.


En IOSA nos damos a la tarea contar con equipos para los procesos productivos en las granjas camaroneras, y así ofrecer más que sólo máquinas, sino la garantía de que el productor pueda aumentar sus ganancias, y que sus ciclos de cultivos sean más rentables.
En IOSA estamos comprometidos con seguir innovando, seguir investigando y aplicando nuestros conocimientos para poder aportar nuestro grano de arena en el sector acuícola latinoamericano.
Para más información, visite: https:// www.iosa.lat/

La sostenibilidad de la acuicultura se ha debatido intensamente desde el año 2000, cuando se publicó en Nature una revisión sobre la contribución neta de la acuicultura al suministro mundial de pescados y mariscos. Este artículo resume las revisiones desarrolladas por los autores sobre los avances y el crecimiento de la acuicultura global de 1997 a 2017, incorporando todos los subsectores de la industria y destacando la integración de la acuicultura en el sistema alimentario global. La presión sobre la industria de la acuicultura para que adopte medidas integrales de sostenibilidad durante este período de 20 años ha mejorado la gobernanza, la tecnología, el posicionamiento y la gestión del sector en muchos casos.
En 2017, la acuicultura suministró más de 80 Mt de pescados y mariscos; y 32 Mt de algas marinas, que abarcan alrededor de 425 especies cultivadas. Hay tres patrones principales de desarrollo que han caracterizado al sector a medida que ha ido madurando: crecimiento continuo en el volumen y las cadenas de valor de la acuicultura de agua dulce; avances en nutrición, genética y tipos alternativos de alimentos que reducen el uso de peces de forraje en formulaciones de alimentos acuícolas; y cultivo ampliado de bivalvos y algas marinas extractivas con el potencial
de proporcionar una amplia gama de servicios alimentarios, industriales y eco sistémicos.
Estas tendencias revelan conexiones cada vez más estrechas entre la tierra y el mar. Dando continuidad a una larga historia de producción continental, la proporción de peces de agua dulce criados con alimentos compuestos, que se elaboran principalmente a partir de ingredientes terrestres y algunos marinos, ha aumentado en las últimas dos décadas. Mientras tanto, ha aumentado también la inclusión de ingredientes de origen vegetal en los alimentos acuícolas y ha crecido la producción

de especies extractivas (moluscos y algas) que filtran los nutrientes de los sistemas alimentarios terrestres y marinos. Por tanto, la acuicultura se ha integrado más en el sistema alimentario mundial, con un rápido crecimiento de la producción y grandes transformaciones en los ingredientes de los alimentos formulados, las tecnologías de producción, la gestión de las producciones y las cadenas de valor.
A través del crecimiento de la acuicultura, los consumidores de países de ingresos desde bajos hasta altos se han beneficiado de la disponibilidad y el acceso durante todo

el año a alimentos acuáticos, que son ricos en proteínas y micronutrientes. El sector acuícola produce mucho más que pescado, mariscos y algas para consumo humano directo. También genera productos utilizados en el procesamiento de alimentos, formulaciones de nutrición, combustibles, cosméticos, nutracéuticos, farmacéuticos y una variedad de otros productos industriales, y contribuye a una variedad de servicios del ecosistema.
A pesar de los impresionantes avances que ha habido, la acuicultura aún enfrenta serios desafíos que, en algunos casos, socavan su capacidad para lograr resultados sostenibles. Ante ello, en general, el sector ha adoptado una expectativa empresarial y social de prácticas ambiental y socialmente sólidas.
Los sistemas de comercialización de pescados y mariscos a nivel mundial están mejorando progresivamente su desempeño ambiental, ya sea de forma independiente o en respuesta a la regulación gubernamental, las normas del sector público y privado, y los incentivos del mercado. Sin embargo, muchos sistemas de acuicultura aún carecen de la motivación para cumplir con los criterios de sostenibilidad porque sus mercados objetivo no recompensan a los productores mediante mejores precios o acceso a oportunidades de venta. Al mismo tiempo, los moluscos, los peces de aleta que se alimentan por filtración y las algas marinas tienen características sostenibles, particularmente porque no dependen de los alimentos acuícolas, sino que eliminan los nutrientes de la columna de agua. En resumen, a medida que la industria global continúa expandiéndose, su contribución al desempeño económico, social y ambiental varía en una amplia diversidad de sistemas de acuicultura.
La producción acuícola mundial se triplicó con creces en volumen de peso vivo de 34 Mt en 1997 a 112 Mt en 2017 (ver Figura 1). Los principales grupos de especies que contribuyeron al 75% superior de la producción acuícola en 2017 incluyeron algas, carpas, bivalvos, tilapia y bagre. Aunque la producción de especies de peces y crustáceos marinos y diádromos también ha crecido rápidamente durante este período, ha sido eclipsada por el volumen de

peso vivo de los bivalvos marinos, las algas marinas y por la producción de la acuicultura de agua dulce. Los peces de agua dulce representan el 75% del volumen de acuicultura comestible mundial, lo que refleja su conversión favorable de peso vivo a comestible en comparación con los moluscos y crustáceos, que tienen altos pesos de concha o caparazón.
El papel de los sistemas de producción en agua dulce ha ganado atención en parte porque los avances en la tecnología de alimentos formulados y la cría, en particular para el salmón y el camarón, están abordando preocupaciones previas sobre los efectos de la acuicultura en las pesquerías de captura silvestre.
La acuicultura es más diversa hoy en día, con un 40% más de especies de peces, mariscos, plantas acuáticas y algas cultivadas en una amplia variedad de sistemas marinos, salobres y de agua dulce a nivel mundial. Sin embargo, la producción mundial sigue concentrada, con solo 22 de los 425 grupos de especies cultivados en 2017 (5%) que representan más del 75% de la producción mundial de peso vivo. Una pequeña fracción de la categoría “plantas acuáticas y algas” (~ 32 Mt) consistía en plantas acuáticas (1,639 toneladas) en 2017.
Asia sigue siendo el mayor productor de acuicultura, representando
el 92% del volumen de peso vivo de animales y algas marinas en 2017.
La acuicultura en Asia también es más diversa que otras regiones en términos de sistemas de producción y especies cultivadas. Nueve de los diez primeros países clasificados en cuanto a diversidad de especies acuícolas se encuentran en Asia, con China a la cabeza por un amplio margen. Desde el año 2000, el país ha mantenido su papel como el mayor productor, procesador y comerciante mundial de pescado, crustáceos y moluscos, y se ha convertido en un consumidor líder debido al rápido crecimiento de los ingresos y la demanda nacional de productos del mar.
Dejando de lado el importante papel de China, el sector de la acuicultura se ha vuelto cada vez más global, con tasas de crecimiento en América del Sur y África superiores a las de Asia durante las últimas dos décadas (aunque a partir de una base de producción mucho más pequeña), y con una expansión relativamente rápida en el sur y el sudeste de Asia en comparación al este del continente. Los mayores productores de acuicultura fuera de Asia —cada uno con el 1-2% de la producción mundial— incluyen a Noruega y Chile, que producen principalmente salmón del Atlántico (Salmo salar), y

Egipto, que produce tilapia del Nilo (Oreochromis niloticus). La acuicultura en el hemisferio occidental se ha desarrollado principalmente en torno a sistemas de una o dos especies y de producción única (por ejemplo, salmón del Atlántico en jaulas, tilapia del Nilo y bagre de canal -Ictalurus punctatus- en estanques). Estos sistemas y especies se han beneficiado de avances genéticos y nutricionales específicos, pero siguen siendo vulnerables a los impactos relacionados con la volatilidad del mercado, los eventos climáticos extremos y las pandemias como la ocasionada por el COVID-19.
El crecimiento de la acuicultura se ha visto impulsado por la expansión del comercio mundial, la disminución de la disponibilidad de peces silvestres, los precios competitivos de los productos, el aumento de los ingresos y la urbanización, todo lo cual contribuye al aumento del consumo per cápita de productos del mar en todo el mundo. Sin embargo, el comercio mundial de pescado sigue limitado a un número relativamente pequeño de especies y países: el salmón, el camarón, el bagre y la tilapia representan en conjunto aproximadamente un tercio de los productos del mar comercializados internacionalmente por valor, pero solo el 8% de la producción mundial de pescados y mariscos. El proceso de globalización en sí ha sido dinámico, con ingresos y mercados en el Sur global expandiéndose más rápidamente que en el Norte global en las últimas décadas. La creciente importancia de los mercados nacionales, particularmente en Asia, significa que más del 89% de la producción acuícola no ingresa a los mercados internacionales.
Durante los últimos 20 años, las tendencias en la producción y el desempeño ambiental de la acuicultura han sido positivas. La conversión destructiva del hábitat, particularmente por el cultivo de camarón en ecosistemas de manglares planteados en la revisión anterior realizada por Nature, ha disminuido notablemente desde el 2000.
Sin embargo, persisten los desafíos para la industria, incluidos los efectos de los patógenos, parásitos y plagas (PPP), la contaminación, la proliferación de algas nocivas y el cambio climático. La industria de la acuicultura se ha vuelto cada vez más vulnerable a estos factores estresantes dada su rápida expansión, su dependencia del medio ambiente y el mundo cambiante en el que operan todos los sistemas alimentarios.
Patógenos, parásitos y plagas Los patógenos, parásitos y plagas (PPP también por sus siglas en inglés) son un riesgo crónico para el sector acuícola, y la intensificación de la producción y el aumento de la integración del comercio y la cadena de suministro desde el año 2000 han amplificado estos riesgos. Las especies acuícolas difieren en sus defensas y, aunque los invertebrados carecen de la inmunidad adaptativa de los peces, su sistema inmunológico innato, que ciertamente no es simple ni homogéneo, no se comprende completamente aún. El intestino es un componente importante del sistema inmunológico de los peces, que permite que la dieta y las alteraciones en el microbioma influyan en la susceptibilidad y la resistencia potencial de los peces a las enfermedades, mientras que las
comunidades microbianas externas son de vital importancia para el estado de salud de los invertebrados.
Para la mayoría de las especies de alto valor y ampliamente comercializadas, ha habido avances sustanciales en la identificación, el diagnóstico y el tratamiento de los PPP en los últimos 20 años, derivados en parte de las innovaciones en la agricultura y la medicina humana. Estas opciones de gestión de enfermedades basadas en la ciencia siguen sin estar disponibles en gran medida para muchas especies de acuicultura de bajo valor, y en regiones de bajos ingresos debido a la falta de desarrollo de productos y costos prohibitivos. Han surgido redes mundiales, como la Organización Mundial de Sanidad Animal, para facilitar la transferencia de conocimientos científicos.
La industria de la acuicultura ha respondido a las presiones de los PPP en las últimas décadas utilizando una variedad de enfoques. La adopción de las mejores prácticas de manejo (por ejemplo, para la selección de sitios y sistemas de cultivo, densidades de siembra, rotaciones de especies, reproductores y calidad del alimento, filtración, limpieza de estanques y jaulas, monitoreo y remoción de parásitos, descarte, zonificación y vigilancia) ha sido los medios más importantes para minimizar los riesgos de los PPP en todos los tipos de sistemas de producción. Una vez que un patógeno, parásito o plaga se reconoce ampliamente en un sistema dado, la prevención mediante bioseguridad es la principal acción de manejo disponible para la mayoría de los acuicultores. En algunos sistemas en los que la dispersión de enfermedades han

provocado ciclos de auge y caída, se han introducido especies resistentes, siempre que existan mercados viables para comercializarlas. Por ejemplo, la industria de la acuicultura en Tailandia pasó del camarón tigre negro al camarón patiblanco, en gran parte debido a problemas con enfermedades infecciosas, específicamente la enfermedad de la mancha blanca y el síndrome de crecimiento lento del Monodon.
El uso de compuestos terapéuticos (sustancias químicas que se utilizan para prevenir y tratar patógenos) incluidos los antimicrobianos, se ha convertido en una práctica común en muchos sistemas de acuicultura. No hay suficientes sobre la naturaleza y el alcance del uso de compuestos terapéuticos en la mayoría de los sectores de la acuicultura, y se encuentran buenas y malas prácticas en todo el mundo. Si bien el uso inadecuado de este tipo de alternativas puede representar riesgos para la salud de los consumidores, trabajadores, organismos cultivados y ecosistemas circundantes (particularmente en sistemas de producción abiertos), el uso indebido de antimicrobianos en la acuicultura es especialmente problemático ya que puede conducir a la aparición y transferencia de genes antimicrobianos y bacterias resistentes.
Como alternativa, se han realizado grandes inversiones en la cría selectiva para la resistencia a enfermedades en ciertas especies de acuicultura, pero esta vía es costosa y no se puede replicar fácilmente entre especies. También se han introducido vacunas multivalentes eficaces para algunas especies de alto valor como el salmón y la trucha que se muestran prometedoras para ser replicadas en la acuicultura de especies marinas si se pueden desarrollar sistemas de administración eficientes y rentables. La gestión avanzada del agua mediante sistemas de recirculación, como se analiza en la siguiente sección, representa otra tecnología importante, pero relativamente costosa, para controlar los PPP. Además, la suplementación del alimento con nutracéuticos, extractos de plantas, prebióticos y probióticos se utiliza para estimular el crecimiento y la inmunidad de los peces y sirve como una alternativa prometedora a los antibióticos, principalmente en sistemas de producción de alto valor, pero también cada vez más en siste-
mas de agua dulce de menor valor, como por ejemplo en el sudeste asiático.
Los estudios también proyectan mayores riesgos de incidencia de enfermedades de la acuicultura y resistencia a los antimicrobianos asociados con el manejo de enfermedades debido al calentamiento global. Sin embargo, la cuantificación de las tendencias en PPP se complica por la variación entre las regulaciones nacionales e internacionales de monitoreo y tratamiento de enfermedades, así como por la falta de datos para la mayoría de las especies de acuicultura y regiones de producción. En ausencia de datos fiables, la incidencia y la gestión de los PPP en toda la industria acuícola mundial es y seguirá siendo muy impredecible.
Proliferación de algas nocivas y cambio climático
La proliferación de algas nocivas está aumentando a nivel mundial con respecto a la frecuencia, magnitud, duración, distribución geográfica y composición de especies, y estos episodios son impulsados en gran medida por procesos antropogénicos. Ocurren en áreas de producción acuícola en todo el mundo y sus efectos en la producción varían ampliamente según la especie. Los sistemas intensivos y mal gestionados de peces y crustáceos pueden contribuir a la aparición de floraciones de algas nocivas, y los mariscos, erizos de mar y pepinos de mar son vectores habituales de microalgas tóxicas. Las floraciones tóxicas representan un gran costo económico para partes de la industria para las que el control y la gestión son ineficaces.
Las pérdidas provocadas por el clima en la productividad de la acuicultura se derivan principalmente de temperaturas de crecimiento subóptimas, aumentos del nivel del mar (intrusión de agua salada), daños a la infraestructura, sequías y escasez de agua dulce, y el aumento de los costos de alimentos asociados con menor rendimiento del cultivo. Los riesgos existentes para la infraestructura de la acuicultura a menudo impulsan las inversiones hacia geografías y sistemas más protegidos. Además, la acidificación de los océanos afecta la producción de mariscos, principalmente en la etapa de vida larvaria, y se maneja mediante ajustes en el pH dentro de los criaderos.
La literatura hasta ahora no apoya las generalizaciones de los daños de la acidificación de los océanos a la acuicultura de mariscos dadas las respuestas específicas de las especies documentadas, los datos escasos, la experimentación desigual y cuestionable y la complejidad de las vías a través de las cuales las especies se ven afectadas. El cambio climático también amplifica las incertidumbres que rodean a los PPP y la proliferación de algas nocivas en la acuicultura y las predicciones siguen siendo inciertas en estos frentes. En general, los estudios científicos sobre las interacciones entre el clima y la acuicultura se basan en datos de tolerancia de laboratorio y están modelados, pero no validados para la acuicultura comercial y, por lo tanto, siguen siendo especulativos. No hay datos completos sobre la producción impulsada por el clima y las pérdidas económicas en la acuicultura a escala regional o mundial,

y los resultados dependen de las respuestas de adaptación en cada área afectada.
Se ha prestado mayor atención a la gestión basada en los ecosistemas, el diseño de sistemas y las nuevas formas de gobernanza del sector público y privado para gestionar los riesgos biológicos y climáticos y fomentar la producción acuícola sostenible.
Los sistemas de recirculación de la acuicultura están diseñados para controlar todas las facetas ambientales de la producción al filtrar, tratar y reutilizar continuamente el agua y, por lo tanto, aumentar la eficiencia operativa y reducir los riesgos de los PPP y el cambio climático. Los sistemas de recirculación de la acuicultura tienen requisitos directos de agua y tierra más bajos que la acuicultura convencional y permiten mayores densidades de población, pero están limitados por los grandes requisitos de energía, los altos costos de producción, los desafíos de eliminación de desechos y el riesgo de fallas por enfermedades catastróficas.
La maricultura en aguas oceánicas profundas y abiertas está diseñada para producir grandes volúmenes de pescado y, al mismo tiempo, minimizar las limitaciones para la producción en ecosistemas terrestres y de los cuerpos de agua dulce, y reducir los impactos ambientales costeros como la contaminación por nutrientes, La maricultura se puede implementar para evitar conflictos

con otros usos marinos y garantizar la dilución efectiva de los desechos, en particular para sistemas de producción a gran escala. Las regulaciones gubernamentales han restringido el desarrollo comercial de la maricultura, particularmente en Estados Unidos y la Unión Europea, debido a la controversia pública sobre sus interacciones con el medio marino, el daño ecológico potencial y los usos competitivos de los recursos naturales y oceánicos.
Las aspiraciones para mejorar el desempeño ambiental y social de las prácticas y tecnologías de la acuicultura han llevado al surgimiento de nuevas combinaciones de regulaciones, códigos y estándares públicos y privados; sin embargo, la aplicación de estos instrumentos de gobernanza ha tenido dificultades para coincidir con la expansión geográfica, los volúmenes y la diversidad de los sistemas de acuicultura. La implementación desigual de la regulación gubernamental ha dado lugar a disparidades regionales en la producción, el crecimiento y el diseño de sistemas. Los gobiernos han facilitado la expansión de la acuicultura en muchos países asiáticos, Noruega y Chile, mientras que en otras regiones, incluidos la Unión Europea y Estados Unidos, los gobiernos han restringido el crecimiento. La regulación desigual también ha dado lugar a disparidades en la inversión y el comercio, y solo unas pocas naciones exportadoras venden en los principales mercados importadores netos de productos del mar, como Estados Unidos y la Unión Europea.
En respuesta a la regulación pública excesiva o insuficiente, han
surgido varios tipos de acuerdos de gobernanza privada con la intención de dar forma a la demanda de una producción acuícola sostenible, justa y orgánica. Por ejemplo, algunas organizaciones no gubernamentales y empresas privadas han introducido entre 30 y 50 sistemas voluntarios de etiquetado, certificación y clasificación.
La certificación a nivel de granja está estableciendo nuevas normas para la acuicultura sostenible alrededor del mundo, sin embargo, su papel sigue estando limitado por los bajos (aún crecientes) niveles de cumplimiento por parte de los productores. Los dos grupos de certificación más grandes que existen, el Aquaculture Stewardship Council (ASC) y los estándares de Mejores Prácticas de Acuicultura de la Global Aquaculture Alliance (GAA-BAP), representan sólo el 3% de la producción acuícola mundial. Los bajos niveles de cumplimiento se han atribuido a finanzas insuficientes, baja demanda de productos certificados, bajos niveles de alfabetización y habilidades administrativas inadecuadas requeridas para el monitoreo y la presentación de informes, así como riesgos ambientales de producción que escapan al control del acuicultor. Las guías para el consumidor, como US Seafood Watch, han valorado un 53% más del total de la producción mundial. Estas calificaciones son involuntarias y se basan en evaluaciones a gran escala a nivel sectorial o regional.
La producción certificada y clasificada está sesgada hacia las principales especies de exportación. En general, el 57% del salmón y la trucha, el 17% de los camarones y mariscos, el 17% del pangasius y el
11% de la tilapia están certificados, con niveles más altos de cumplimiento observados en países con una mayor proporción de cadenas de suministro integradas verticalmente. La demanda interna de productos sostenibles en los mercados de productos del mar de Asia parece estar aumentando, impulsada por preocupaciones sobre la seguridad alimentaria, pero se necesita un crecimiento considerable de la demanda nacional de productos sostenibles para que los sistemas de clasificación y certificación de la acuicultura sean efectivos a nivel mundial.
Los países pueden mejorar el éxito de los acuerdos de gobernanza privada proporcionando capacidades, recursos y una regulación mínima para apoyar las mejoras en las prácticas acuícolas. Tanto la certificación como las guías para el consumidor han comenzado a migrar hacia formas de gobernanza “híbridas”, que integran herramientas de evaluación privadas en unidades de gestión espacial que se desarrollan en colaboración entre compradores y gobiernos.
La documentación de la acuicultura de los últimos 20 años refleja una mayor atención a los resultados del sistema alimentario, con los consumidores, las cadenas de valor y los criterios de sostenibilidad que configuran progresivamente la dirección de la industria. El crecimiento continuo del sector tiene importantes implicaciones para el alcance de los Objetivos de Desarrollo Sostenible de las Naciones Unidas.
En esta revisión surgen tres patrones clave durante las últimas dos décadas que vale la pena destacar. Primero, los peces de agua dulce tienen un papel central en la producción mundial, contribuyendo más que cualquier otro subsector de la acuicultura al volumen total (vivo y comestible), los medios de vida rurales y la seguridad alimentaria. Sin embargo, debido a que la mayoría de los peces de agua dulce cultivados no ingresan al mercado global, actualmente hay poco ímpetu el sector para que los productores se involucren en prácticas sostenibles con clasificaciones o certificaciones reconocidas.
Segundo, se han realizado mejoras notables en la eficiencia del uso
de los recursos marinos en todas las especies alimentadas y en el campo de la nutrición de los peces. Mayores avances en estas áreas pueden ser más difíciles y costosos de alcanzar para las especies carnívoras, pero los costos crecientes de la harina y el aceite de pescado que están asociados con los límites de los recursos marinos proporcionarán incentivos continuos para la innovación en este frente.
Tercero, la ubicación cuidadosa de los sistemas de acuicultura sustenta el éxito comercial y ambiental de la industria. Casi todos los sistemas de acuicultura marina y de agua dulce interactúan con el medio ambiente acuático y, como resultado, se benefician de y proporcionan servicios ambientales a los ecosistemas. Por lo que la ubicación y escalamiento prudentes son esenciales para maximizar los servicios ecosistémicos proporcionados por las especies extractivas cultivadas y para mitigar los desafíos críticos para la industria asociados con los PPP, la contaminación costera y el cambio climático.
La amplia diversidad de sistemas de acuicultura entre especies, geografías, productores y consumidores impide el desarrollo de una estrategia única para lograr productos sostenibles y saludables. Los sistemas de gobernanza deben diseñarse con metas claramente articuladas y fundamentadas en la ciencia, pero sin normas y regulaciones excesivamente restrictivas para poder realmente alcanzar esas metas. Dicha flexibilidad es necesaria para respaldar las capacidades de las industrias, los gobiernos y las organizaciones no gubernamentales para innovar y, al mismo tiempo, proporcionar puntos finales y requisitos claros para el monitoreo, la presentación de informes, la transparencia y la responsabilidad en las actividades del sector. La acuicultura seguirá enfrentando grandes incertidumbres en el futuro, incluidos los efectos del cambio climático, la evolución de las presiones de los PPP, las pandemias y las alteraciones del mercado y los cambios en los sistemas alimentarios en general.
De cara al futuro, la planificación espacial y la regulación efectivas de los sitios de acuicultura serán fundamentales para lograr resultados ambientales positivos, especialmente a medida que los sistemas
de acuicultura aumentan en escala e intensifican su producción. La industria está investigando tecnologías de recirculación y producción mar adentro para reducir su exposición e impacto a los ambientes acuáticos; sin embargo, estos sistemas requerirán una gestión financiera y ambiental innovadora para tener alguna posibilidad de éxito generalizado. Además, se necesitan inversiones en una serie de estrategias de prevención de los PPP en diferentes subsectores de la acuicultura, reconociendo que los tratamientos después de que surgen los problemas son en gran medida inútiles. Por último, las políticas y programas futuros para promover la acuicultura requerirán un enfoque de sistemas alimentarios que examine los resultados y compensaciones de la nutrición, la equidad, la justicia y el medio ambiente en la tierra y en el mar. Será necesario perfeccionar y utilizar herramientas como el análisis del ciclo de vida para garantizar la correcta comparación entre la producción ganadera terrestre y la acuicultura sobre la base del valor nutricional y los resultados ambientales mundiales.
Comentario del equipo editorial sobre el contenido en línea
La versión completa de esta revisión, así como los métodos utilizados, referencias adicionales, resúmenes de informes de Nature Research, datos de origen, datos ampliados, información complementaria, agradecimientos, información de revisión por pares; detalles de las contribuciones de los autores e intereses en competencia; y las declaraciones de disponibilidad de códigos y datos están disponibles en https://doi.org/10.1038/s41586021-03308-6
* Esta es una versión divulgativa desarrollada por el equipo editorial de Panorama Acuícola Magazine del artículo “A 20-year retrospective review of global aquaculture”, escrito por: Rosamond L. Naylor, Ronald W. Hardy, Alejandro H. Buschmann, Simon R. Bush, Ling Cao, Dane H. Klinger, David C. Little, Jane Lubchenco, Sandra E. Shumway y Max Troell que fue recientemente publicado por la revista Nature en el volumen 591 de su journal digital.
La versión original completa se encuentra disponible para su consulta en: https://doi.org/10.1038/s41586-02103308-6
En charlas dadas durante los congresos Aqua Expo Guayaquil en 2018 y 2019, describimos cómo el KeraStim®50, una mezcla de aminoácidos libres y naturales (MALN), puede generar beneficios económicos en el cultivo de camarón.
Esta MALN añadida al alimento con una concentración de 5 kilogramos por tonelada genera mejoramientos del consumo alimenticio, del crecimiento y de la conversión alimenticia con un efecto positivo sobre la atractabilidad del alimento para el camarón.
Además de los efectos sobre el desempeño zootécnico y el comportamiento de los camarones, nos parecía interesante investigar la sobrevivencia más a detalle. Queríamos ver si la mejora de éste parámetro en el camarón alimentado con MALN también puede verse en condiciones de desafíos con los patógenos responsables de la enfermedad de necrosis hepatopancreática aguda (AHPND por su siglas en inglés) y del virus de la mancha blanca (WSSV también por sus siglas en inglés).
Con el objetivo de explorar esta temática, hicimos dos ensayos (Prueba I en 2018 y Prueba II en 2020) en colaboración con el Centro de Investigación Incabiotec/ Concepto Azul ubicado en Tumbes, Perú.
El Kera-Start®90 fue producido por la empresa BCF Life Sciences

(Boisel, Francia). Esta mezcla de 17 AA obtenida a partir de la queratina de aves viene con una altísima concentración en aminoácidos (88.7%) cuya mayoría es de forma libre (94.5%) como se puede ver en la Tabla 1.
Se utilizaron como base dos referencias de alimentos para post larvas (PL) hechos localmente (Nicovita Origin 0.5 por PL11-20 y Nicovita Origin 0.8 por PL21 -1g, 45, ver composición detallada en la Tabla 2). Además, tres concentraciones de MALN fueron pulverizadas sobre los pellets: 10g/Kg de alimento, 50g/kg de alimento y 100g/ kg de alimento (MALN 10, MALN 50 y MALN 100, respectivamente).

Antes de la aplicación las MALN fueron mezcladas con una cantidad fija de agua (3/5 de MALN y 2/5 de agua). La mezcla fue homogeneizada y aplicada sobre el alimento durante 3 minutos en un mezclador. Los alimentos control siguieron el mismo tratamiento pero sólo con agua. Después de doce horas de secado, cada lote fue recubierto con una mezcla de
aceite de pescado y de aceite de soya (2:1) pulverizada en una concentración de 30g/kg de alimento. Después de un nuevo secamiento a temperatura ambiente, los alimentos fueron almacenados en bolsas individuales en un lugar limpio y refrigerado (4°C).
Cria de camarones, protocolo experimental del periodo de crecimiento y desafíos sanitarios
Las post larvas de camarones blancos, PL14 y PL21 (por las pruebas I y II respectivamente) fueron obtenidas a partir de reproductores certificados. Los animales fueron analizados por PCR para confirmar la ausencia de WSSV, IHHNV (virus de la necrosis hipodérmica y hematopoyética), NHP (hepatopancreatitis necrotizante) y AHPND.
Cada ensayo empezó con un periodo de engorde de 28 a 21 días respectivamente. Durante este periodo, los camarones fueron mantenidos en 36 tanques de 20 litros de capacidad, llenados con 15 litros de agua salgada (32 ppm). Cada tanque fue poblado con 90 post larvas de camarón. Los tan-

Una mezcla de aminoácidos sustentable influye en la sobrevivencia de post larvas de camarón blanco ante la presencia de la Enfermedad de Necrosis Hepatopancreática Aguda y del Virus de la Mancha Blanca
Los desafíos bacteriológicos y virológicos ayudan a entender cómo los aminoácidos libres naturales obtenidos a partir de la hidrolisis de queratina de aves mejoran la sobrevivencia del camarón blanco.

ques fueron divididos en 4 grupos de nueve tanques según el plano experimental descrito en la figura 1. Cada grupo fue alimentado con uno de los alimentos arriba descrito.
Al final del periodo de engorde 324 PL de cada tratamiento fueron recolocados en acuarios de 15 litros llenados con la misma agua. Los animales fueron divididos en 3 grupos: el Grupo control (sin infección), el grupo AHPND y el grupo WSSV. La figura 2 describe el plano experimental de esta segunda fase. Los pesos corporales iniciales medios de la fase de desafíos fueron de 0.26g y 0.09g para los ensayos 1 y 2 respectivamente.
Las infecciones con AHPND y WSSV fueron hechas por inmersión de los animales en soluciones contaminadas por los patógenos, segun protocolos de infección estándares. La solución del grupo AHPND contenía 106 UFC/ml de Vibrio parahaemolyticus y la solución del grupo WSSV fue obtenida por la adición de tejidos infectados con una concentración de 20% de la biomasa inicial.


Cada grupo fue alimentado con uno de los alimentos arriba descrito por un periodo de 28 días.
Las tasas de sobrevivencia y la biomasa fueron analizadas semanalmente durante cada fase de las pruebas (engorde y desafíos sanitarios) para identificar los efectos potenciales del MALN sobre estos parámetros productivos.
de la fase de engorde
La sobrevivencia y ganancia de peso fueron normal durante la fase de engorde con tasas de sobrevivencia de 81% y de 87% para grupos controles de las pruebas I y II respectivamente.

Al final de las cuatro semanas de la fase de desafíos sanitarios, los grupos AHPND y WSSV presentaron una sobrevivencia y un aumento de biomasa significativamente más bajos en comparación con el grupo non infectado (Tablas 3, 4 y 5). En los grupos WSSV de las pruebas I y II y en el grupo AHPND de la prueba II, los animales alimentados con MALN obtuvieron niveles de sobrevivencia significativamente mayor a partir de la segunda semana hasta al final de la fase de desafío sanitario en comparación con los animales alimentados sin MALN (gráficos 1, 2 y 3 y tablas 4 & 5).
Los grupos infectados enfrentaron una mortalidad alta en comparación con los grupos no infectados en cada prueba. En estas condiciones altamente desafiantes, es notable que los camarones alimentados con diferentes niveles de MALN obtienen un mejor nivel de sobrevivencia y un aumento de biomasa en comparación con los grupos de control en caso de infección con AHPND y con WSSV.
Las actividades de investigación se enfocan generalmente en un amino ácido esencial particular y su efecto individual sobre el potencial del alimento enriquecido. A nuestro conocimiento hasta ahora no había trabajos científicos disponibles demostrando la eficiencia de MALN en caso de desafío sanitario con camarón. El producto evaluado en este estudio viene con 17 AA solubles entre los cuales algunos ya han sido identificados por sus acciones positivas sobre el sistema inmunitario de las especies acuáticas (Li et al., 2009).
Los mecanismos de acción son probablemente múltiples ya que cada aminoácido actúa a diferentes niveles de vías metabólicas. Podemos plantear que es mejor utilizar mezclas complejas con varios aminoácidos para influir sobre la respuesta inmune de los camarones.
La mezcla de aminoácidos evaluada en esos estudios es el producto de un hidrolisis extensiva. Así el producto viene con una solubilidad y una digestibilidad altísima (100% y 96.8% en gallo joven, respectivamente) que permiten una asimilación rápida. Tales características son




particularmente importantes en la nutrición de animales juveniles que tienen un tracto digestivo inmaduro y aprovechan nutrientes fáciles de digerir para alimentar eficientemente sus vías metabólicas (Rønnestad et al., 2003).



Hoy en día, los nutricionistas apenas ven a los aminoácidos como nutrientes que permiten equilibrar el perfil de la proteína de los alimentos. Nuestros resultados demuestran que los mismos pueden también ser considerados por otras aplicaciones en alimentos balanceados para camarones.
Algunas investigaciones previas han demostrado el efecto positivo de las mezclas de aminoácidos libres y naturales obtenidos a partir de la hidrolisis de queratina de aves sobre el desempeño zootécnico de los camarones (Le Reste et al., 2019). Ahora estas mezclas aparecen como una potencial solución eficaz para mejorar la respuesta inmune del camarón confrontado a un desafío sanitario causado por bacterias o virus. Este nuevo campo de aplicación confirma su potencial como fuente de proteína sostenible con una funcionalidad interesante en la nutrición del camarón.
*Pierrick Kersanté es Manager de I&D en acuicultura en BCF Life Sciences. Está involucrado en programas de investigación, desarrollo de productos, aplicaciones y soporte técnico. Contacto: pkersante@bcf-lifesciences.com
Guillaume Le Reste es consultor independiente especializado en nutrición y alimentación acuícola basado en Francia. Contacto: g.lereste@halieutica.net
Romain Le Hen es gerente comercial por América Latina en BCF Life Sciences y trabaja en contacto directo con los distribuidores, fábricas de alimentos y camaroneros. Contacto: rlehen@bcf-lifesciences.com
Referencias citadas por los autores en el artículo disponibles bajo previa solicitud.
Una mezcla de aminoácidos libres y naturales (MALN), puede generar beneficios económicos en el cultivo de camarón con mejoramientos del consumo alimenticio, del crecimiento y de la conversión alimenticia con un efecto positivo sobre la atractabilidad del alimento para los animales.
Por su parte, los subproductos terrestres tienen un gran potencial como sustituto de la harina de pescado porque son fuentes de proteína fácilmente disponibles y económicas y tienen perfiles de aminoácidos más completos que las proteínas vegetales.
Por:
Al producir pescado con un impacto medioambiental mínimo y un beneficio máximo para la sociedad, se prevé que la acuicultura contribuya más eficazmente al desarrollo económico, la seguridad alimentaria internacional, el bienestar nutricional y la reducción de la pobreza. El aumento de la
producción acuícola hace que más de la mitad del pescado que consumen los seres humanos en todo el mundo sea producido por la acuicultura. La demanda de recursos alimenticios, en particular de harina de pescado con proteínas de primera calidad, ha aumentado debido a la oferta mundial de pescado a medida que se incrementa la producción.
Un precio competitivo, plena disponibilidad, facilidad de manipulación, envío, almacenamiento y uso en la producción de alimentos balanceados son características que debe poseer el candidato ideal para ser un alimento alternativo viable a la harina de pescado en los alimentos acuícolas. Además, debe tener un alto contenido en proteínas, un

Fuentes de proteína animal como sustituto de la harina de pescado en dietas de acuicultura: una revisión sistemática y un meta-análisis
perfil de aminoácidos favorable, una alta digestibilidad de los nutrientes, bajos niveles de fibra, almidón y carbohidratos no solubles, que son características nutricionales.

Debido a su mayor contenido en proteínas y lípidos, alto contenido en aminoácidos esenciales y a su excelente palatabilidad, las fuentes de proteína animal se han considerado normalmente fuentes de proteína sustitutivas ideales para reemplazar la harina de pescado en la formulación de dietas para peces.
Para proporcionar las cantidades obligatorias de proteína de alta calidad para satisfacer la creciente demanda, se necesitan nuevas iniciativas. En este sentido, el propósito de este estudio fue realizar una revisión sistemática de los artículos publicados sobre las fuentes de proteína animal utilizadas en la acuicultura, y evaluar los resultados de las dietas recomendadas frente a la dieta de control.
Se realizó una búsqueda sistemática de la literatura publicada utilizando como criterio de selección artículos publicados entre 1999 y 2019, en los que se informó sobre la tasa de crecimiento específico, peso final, índice de conversión alimenticia y tasa de supervivencia. El metaanálisis se realizó para el peso final, la tasa de crecimiento específica, el índice de conversión alimenticia y la tasa de supervivencia, por separado. En total, se evaluó la elegibilidad de 217 artículos y se incluyeron 18 en la revisión sistemática y el metaanálisis.
Los resultados de los artículos de revisión mostraron que las fuentes de proteína animal que sustituyen a la harina de pescado, van desde los insectos (gusanos de Mopane (Imbrasia belina), saltamontes (Zonocerus variegatus), grillos de campo (Gryllus bimaculatus), gusanos de mosca (Chrysomya megacephala) la mosca soldado negra (Hermetia illucens) y el supergusano (Zophobas morio) , subproductos de animales terrestres (harina de plumas fermentada, harina de plumas, subproductos avícolas, harina de carne y huesos y harina de sangre) y subproductos de la pesca. Además, diversas especies de peces, como


Oreochromis mossambicus, Clarias gariepinus, Oreochromis niloticus, Sparus aurata, Dicentrarchus labrax, Scophthamus maeotinus, Lutjanus guttatus, Ophiocephalus argus, tilapia roja (O. mossambicus, O. niloticus, Oreochromis aureus) y Acipenser glueldenstaedtii, también han sido utilizadas.
Los niveles recomendados de fuentes de proteína animal en los alimentos fueron el 20% de harina de plumas y de cabeza de camarón para C. gariepinus , el 20% de harina de carne y huesos para Op. argus , el 25% de harina de supergusano, subproductos avíco-

las y saltamontes para L. guttatus y C. gariepinus respectivamente, el 30% de harina de krill para A. glueldenstaedtii , el 20-50% de harina de plumas fermentada para O. Nilo de plumas fermentadas para O. niloticus , 50% de subproductos avícolas y ensilado de pescado para O. niloticus y tilapia roja, respectivamente, 60% de harina de lombriz mopana para O. ossambicus y 100% de harina de grillo de campo para C. gariepinus

Valores de peso final, índice de crecimiento específico, índice de conversión alimenticia y ratio de supervivencia
La evaluación de los pesos inicial y final para todos los niveles recomendados de fuentes de proteína animal alimentadas, mostró un aumento de peso para todas las especies de peces que participaron en los experimentos. La tasa de crecimiento específico osciló entre el 0.56% y el 7.89%. Se registraron índices de conversión alimenticia de 1.25, 1.51 y 2.20 para O. mossambicus, C. gariepinus y C. gariepinus, que fueron alimentados con harina de insectos, respectivamente. Para los subproductos terrestres, se obtuvieron ratios de conversión alimenticia de 1.73, 1.34, 1.20, 1.40 y 1.24
para O. niloticus, C. gariepinus, L. guttatus, O. niloticus y Op. argus, respectivamente.
Se obtuvieron ratios de conversión alimenticia de 1,35, 2,50 y 1,10 en tilapia roja, C. gariepinus y A. glueldenstaedtii alimentados con productos de la pesca (ensilado de pescado, harina de cabeza de camarón y harina de krill), respectivamente. La tasa de supervivencia osciló entre el 83% y el 100%, excepto en el caso de la tilapia roja y el C. gariepinus, que fueron alimentados con ensilado de pescado y harina de cabeza de camarón, respectivamente, donde no se informó de la tasa de supervivencia.


Discusión de observaciones Distintas especies de peces tienen diferentes necesidades de nutrien-
tes, lo que afecta al nivel de inclusión de fuentes de proteínas en las dietas probadas. Los beneficios para la salud humana, el precio competitivo, la seguridad del pescado, la eficiencia, la aceptación de los clientes, la contaminación mínima y el estrés del ecosistema, son factores que influyen en la selección de los alimentos.
El rendimiento del crecimiento, medido por el peso final y la tasa de crecimiento específica, demostró que el exceso de proteínas no podía utilizarse eficazmente para el crecimiento debido a la energía de crecimiento utilizada para la desaminación y excreción de los aminoácidos absorbidos en exceso. Cuando los niveles de proteína en la dieta aumentan, el índice de conversión alimenticia disminuye. Tanto
las especies de peces de agua dulce como las marinas utilizan insectos como parte de su dieta natural. Los insectos son más naturales de reproducir, tienen una mayor tasa de crecimiento y transforman muy eficazmente la materia orgánica o de baja calidad en proteínas de alto valor.
Los niveles recomendados para la harina de insectos en esta revisión muestran que la sustitución total de la harina de pescado no ha tenido éxito. Los resultados apoyan los hallazgos que sugieren que el desequilibrio o las deficiencias en la dieta son la razón principal de las limitaciones del uso de insectos, entre las que se incluyen: (i) el valor nutricional variable, que depende de la especie, la etapa de desarrollo y el sustrato utilizado
El rendimiento del crecimiento, medido por el peso final y la tasa de crecimiento específica, demostró que el exceso de proteínas no podía utilizarse eficazmente para el crecimiento debido a la energía de crecimiento utilizada para la desaminación y excreción de los aminoácidos absorbidos en exceso.
para alimentar al insecto, (ii) la baja concentración de aminoácidos que contienen azufre, y (iii) la ausencia de eicosapentaenoico y docosahexaenoico.
Oreochromis niloticus, C. gariepinus, L. guttatus, O. niloticus y Op. argus también convierten eficazmente los subproductos terrestres. Al igual que otras fuentes de proteína animal, los subproductos de la pesca suministrados a las tilapias rojas, C. gariepinus y A. glueldenstaedtii, dieron lugar a ratios de conversión alimenticia aceptables.
Por su parte, los subproductos terrestres tienen un gran potencial como sustituto de la harina de pescado porque son fuentes de proteína fácilmente disponibles y económicas y tienen perfiles de aminoácidos más completos que las proteínas vegetales. El uso de la harina de plumas en los alimentos de acuicultura está limitado por el hecho de que los peces son incapaces de digerirla. Se ha informado de que la lisina, la metionina y la isoleucina son aminoácidos esenciales limitantes en los subproductos avícolas, la harina de carne y huesos y la harina de sangre, respectivamente.
La piel y las aletas, las escamas, las cabezas y las espinas, las vísceras y los recortes musculares son los principales subproductos producidos en las industrias pesqueras. Los factores que limitan el uso de
los subproductos de la pesca son el coste de la recogida de los residuos de pescado, el procesamiento oportuno y el control de calidad. Además, los residuos de pescado varían mucho en su naturaleza física y composición próxima; y algunos residuos de pescado, como los procedentes de los mariscos, sólo están disponibles durante la temporada de pesca.
El tamaño de la muestra varía en función del número de estudios incluidos en el meta-análisis. Los resultados para el peso final, la tasa de crecimiento específico, el índice de conversión alimenticia y la tasa de supervivencia, muestran que hay una diferencia estadísticamente significativa entre los estudios.
El nivel de heterogeneidad fue muy alto tanto para el peso final como para la tasa de supervivencia. No hubo heterogeneidad para el índice de crecimiento específico y el índice de conversión alimenticia. El peso final, la tasa de crecimiento específica, el índice de conversión alimenticia y la tasa de supervivencia de los peces en el experimento o en la cría en general, se ven afectados por muchos factores, como la edad de los peces, la especie, la densidad de población, el nivel y la frecuencia de alimentación, la fuente de proteínas y los parámetros de calidad del agua, como la temperatura del agua, el oxígeno disuelto y el pH.
A pesar de toda la heterogeneidad observada, estas fuentes de proteína animal han mostrado efectos positivos sobre el índice de conversión alimenticia, la tasa de crecimiento específico, el peso final y la supervivencia de diferentes especies de peces de distintos grupos de tamaño.
A pesar también de las limitaciones en el uso de insectos, subproductos terrestres y subproductos de la pesca como reemplazo de la harina de pescado, estas fuentes de proteína animal han mostrado efectos positivos en el índice de conversión alimenticia, la tasa de crecimiento específico, el peso final y la supervivencia de diferentes especies de peces de distintos grupos de tamaño.

Esta es una versión divulgativa desarrollada por el equipo editorial de Panorama Acuícola Magazine del artículo “Animal Protein Sources as a Substitute for Fishmeal in Aquaculture Diets: A Systematic Review and MetaAnalysis” autoría de: Rendani LuthadaRaswiswi, Samson Mukaratirwa, y Gordon O’Brien que fue publicado originalemente en abril de 2021 a través del journal de Applied Sciences de MDPI bajo una licencia de uso de Creative Commons 4.0.
La versión original se puede consultar en línea a través de este enlace: https:// dx.doi.org/10.3390/app11093854
A pesar de las limitaciones en el uso de insectos, subproductos terrestres y subproductos de la pesca como reemplazo de la harina de pescado, estas fuentes de proteína animal han mostrado efectos positivos en el índice de conversión alimenticia, la tasa de crecimiento específico, el peso final y la supervivencia de diferentes especies de peces de distintos grupos de tamaño.

El doble tamizado es conceptualmente fácil y sólo requiere dos mallas finas superpuestas que funcionan como un filtro de dos capas para separar los quistes de los nauplios de Artemia. Pero este proceso de filtración requiere mucho tiempo, es laborioso, y determina la calidad final del alimento vivo.
Por: INVE Aquaculture *Los laboratorios de larvas de camarón y cría de peces de todo el mundo dependen de los nauplios de Artemia como el alimento preferido de larvas vivas para obtener una producción constante y predecible. La Artemia desencadena el comportamiento de alimentación de las larvas de peces y camarones, tiene el tamaño adecuado para estos organismos y es muy nutritiva.

El método tradicional para cosechar nauplios Durante el proceso de eclosión, los embriones de Artemia dentro de los quistes se convierten en nauplios vivos que nadan libremente y que se pueden encontrar en el tanque de eclosión junto con las cápsulas rígidas y los quistes no eclosionados. Estos quistes no eclosionados y las cápsulas restantes no son comestibles y deben separarse de los nauplios, antes de que puedan usarse como alimento. La eliminación de quistes es un desafío, incluso para la acuicultura moderna, ya que los métodos actuales no siempre son eficientes y sostenibles.
Por lo general, los nauplios de Artemia se separan de los quistes y las cápsulas mediante el método de doble tamizado (ver Figura 1). El doble tamizado es conceptualmente fácil y sólo requiere dos
mallas finas superpuestas que funcionan como un filtro de dos capas para separar los quistes de los nauplios de Artemia, lo que obliga a los nauplios a pasar a través de la malla. Pero este proceso de filtración requiere mucho tiempo, es laborioso, y determina la calidad final del alimento vivo.
Además, la eficacia del método de doble tamizado se ve influida por varios factores que se exponen a continuación:
• Los quistes con un tamaño más pequeño que la malla pasarán a través del tamiz, contaminando la suspensión de nauplios vivos con material no digerible.
• El doble tamizado solo se puede hacer cuando los nauplios vivos aún son pequeños (primer estadio larvario, es decir estadio I), lo que restringe el método a un tiempo de recolección óptimo y hace que los nauplios tengan un alto riesgo de dañarse durante el proceso de separación. Los nauplios dañados y muertos son un alimento menos atractivo y liberan nutrientes al medio acuoso. Junto con la presencia de cápsulas y quistes no eclosionados, estos nutrientes pueden inducir condiciones sub-
óptimas en los tanques de larvas, favoreciendo el desarrollo de bacterias no deseadas y aumentando los riesgos de bioseguridad en el criadero.
• Debido a la obstrucción del tamiz, el método de doble tamizado no permite recuperar todos los nauplios durante el proceso sino que sólo se puede recuperar una fracción de la biomasa de Artemia obtenible, lo que resulta en pérdidas económicas directas en la planta de incubación así como mayores costos de producción.
Todos estos factores contribuyen al hecho de que método de tamizado doble sea ineficiente, laborioso y menos adecuado para el crecimiento económico de la producción acuícola.
Un método más eficiente SEP-Art aborda las deficiencias del doble tamizado, en particular la recuperación sub-óptima de biomasa y la pérdida de calidad del alimento vivo a través del magnetismo como herramienta para separar los nauplios de Artemia de sus quistes (ver Figura 1).

A diferencia del método de doble tamizado, SEP-Art no emplea redes
de malla, lo que elimina por completo la posibilidad de daño físico a los nauplios. Además, todos los nauplios presentes en el tanque de incubación se pueden recuperar de manera eficiente. El resultado de su uso es una suspensión de nauplios muy atractivos, intactos y muy activos, listos para alimentar a las larvas.
Con el uso de este método se cosechan más nauplios de Artemia, de mejor calidad, en menos tiempo y con menos esfuerzo. Además se aumenta la eficiencia del proceso y la calidad de la Artemia, lo que permite que la producción de nauplios de alto nivel respalde el crecimiento sostenible de la industria acuícola.
*Más información: https://www.inveaquaculture.com/product/specialityartemia/

Cargill empodera a mujeres empresarias del sector camaronero
Cargill y la Escuela de Negocios Edes de la Universidad Técnica Particular de Loja (UTPL) en Ecuador firmaron una alianza para llevar a cabo un programa de capacitación para 100 mujeres productoras de camarón en México, Centroamérica y Ecuador. El programa ayudará a las beneficiarias a acceder a tecnología y conocimientos técnicos, eliminando así obstáculos para mejorar sus fuentes de ingresos y enriquecer a la industria y a sus comunidades. Esta asociación se alinea con el compromiso de Cargill de promover la paridad de género y el empoderamiento de las mujeres a lo largo de sus cadenas de suministro.
Cargill y la UTPL trabajarán juntos para desarrollar las habilidades empresariales de las mujeres camaroneras en la costa de los estados de Sonora y Sinaloa, México; en las regiones de Choluteca y Valle del sur de Honduras; Chinandega en Nicaragua; y las provincias de Oro, Guayas y Santa Elena en Ecuador, a través de la educación, para que puedan ampliar sus conocimientos y aplicarlos en sus respectivos negocios. Cada comunidad participante tiene la vocación productiva y la dedicación para enfocar sus esfuerzos en el desarrollo de este sector.
“Nos sentimos honrados y entusiasmados de asociarnos con la UTPL para abrir las puertas a las mujeres primero, en sus comunidades y luego a mercados de exportación más amplios”, comentó Pilar Cruz, Chief Sustainability Officer de Cargill. “Invertimos en el desarrollo de las comunidades y en educación para impulsar la resiliencia económica y social. Programas como este dan vida al propósito de Cargill de nutrir al mundo de una manera segura, responsable y sostenible”.
El programa de formación que, académicamente está liderado por la Universidad Técnica Particular de Loja, a través de la Fundación para el Desarrollo Empresarial y Social (FEDES) como aliada estratégico de la Universidad para el impulso y desarrollo sostenible de las comunidades y, su Escuela de Negocios EDES como ejecutor de la formación académica, está conformado por seis módulos académicos que serán impartidos en la modalidad de estudios online, abarcando contenidos como: liderazgo, motivación, finanzas, cultura digital, entre otros. Estos módulos permitirán fortalecer las capacidades y competencias de las participantes.

Para Camilo Pinzón, Director General de EDES Business School, Escuela de Negocios de la UTPL “el aportar al desarrollo social y económico de los territorios es una prioridad para la Academia. Reconocemos que a través de la alianza con el Programa de Educación Continua de Mujeres Empresarias podremos aportar desde la UTPL a fortalecer las capacidades territoriales del sector camaronero y el liderazgo personal y profesional de las mujeres que se dedican a esta actividad”.
Más información en: https://www. cargill.com/
Ecuador y Perú buscan alcanzar la sostenibilidad del pescado dorado

Ecuador y Perú solicitaron el apoyo de la Comisión Interamericana del Atún Tropical (CIAT) en la ejecución de proyectos científicos enfocados en la mejora del conocimiento del recurso dorado en el Océano Pacífico Oriental (OPO).
Esta solicitud se realizó a través de una propuesta de plan científico regional de dorado/perico elaborada por el Instituto Público de
Acuacultura y Pesca de Ecuador (IPIAP) y el Instituto del Mar del Perú (Imarpe), que fue presentada durante la última reunión del Comité Científico Asesor (CCA). Ecuador y Perú producen y exportan esta especie a nivel mundial, siendo Estados Unidos el país principal importador de este producto.
Este proceso regional fue explicado por la delegada de Perú, Ana Alegre, funcionaria del Imarpe, quien durante la presentación de los tres proyectos que incluye este plan resaltó el involucramiento del sector privado en la promoción de investigación científica sobre este recurso.
Alegre indicó que el plan recoge las necesidades de investigación identificadas por productores y procesadores de dorado/perico de Ecuador, Perú y Costa Rica, asociados en el Comité Regional del Mahi-mahi (COREMAHI).
En tanto, los proyectos que buscan el apoyo de la CIAT son el establecimiento de un programa de colecta, almacenamiento y difusión de datos biológicos y pesqueros de dorado/perico; el desarrollo de evaluaciones de stock para conocer el estado del stock de dorado/perico; y la realización de un estudio de marcaje para reducir las incertidumbres sobre la estructura del stock.
Este último proyecto de marcaje es complementario a un estudio genómico del recurso dorado que actualmente están llevando a cabo el IPIAP, el Imarpe y la autoridad pesquera de Costa Rica (Incopesca), con apoyo del Centro Interdisciplinario de Ciencias Marinas (Cicimar) de la Universidad Autónoma de México (UNAM).

Varios estudios han reportado los beneficios del uso de ácidos orgánicos, aceites esenciales e inmunomoduladores para mejorar el crecimiento, la eficiencia alimenticia y el estado de salud de los camarones. Estos productos pueden ser de mayor relevancia en sistemas de cultivo intensivo y más aún en condiciones de cero salinidad donde el camarón tiene un desafío adicional para mantener la capacidad osmoregulatoria. El objetivo de este estudio fue evaluar en cultivo de agua dulce a alta densidad, el efecto de incluir aditivos antimicrobianos en alimentos balanceados iónicamente sobre el rendimiento de juveniles Litopenaeusvannamei
Con más de 678,000 TM de camarón exportado en 2020, Ecuador está a punto de convertirse en el mayor exportador mundial de camarón de cultivo. Con ingresos anuales de U$D 3’611,871 el camarón también ocupa el primer lugar entre las exportaciones no petroleras.
Los cultivos tierra adentro son una práctica creciente en diferentes países como Ecuador, Tailandia y China. Como resultado, se han utilizado una gran cantidad de estrategias en función de la ubicación geográfica, el clima, la disponibilidad de agua, etc. (Boyd y Trucker, 2014).
En Ecuador, el cultivo de camarón a bajas salinidades se ha expandido considerablemente y con ello la necesidad de poner en práctica estrategias que permitan a los organismos disponer de los iones para su normal desarrollo.
Los métodos tradicionales de cultivo de camarón han dado paso a sistemas extensivos e intensivos, categorizados según la densidad de la población y el uso de insumos. Debido a la gran capacidad para mantener la regulación osmótica e iónica en varios ambientes salinos, L. vannamei puede habitar agua con salinidades que van desde 0.5 a 60 ppt (Bray et al. 1994; Saoud et al., 2003; Nunes y Lopez 2001). No obstante, es bien aceptado que L. vannamei puede crecer también
en condiciones de agua dulce. Hay varias granjas, cubriendo un área de aproximadamente 20,000 ha en la provincia del Guayas, donde las salinidades varian de 0 a 16 ppt.

El cultivo a baja salinidad y agua dulce conlleva una serie de desafíos como el manejo del medio, debido a las deficiencias de ciertos minerales especialmente potasio K+ y magnesio Mg+2 (Boyd 2002). Ambos K+ y Mg+2 son cationes esenciales para el normal crecimiento, supervivencia y osmoregulacion de los crustáceos (Mantel y Farmer, 1983; Pequeux, 1995). El magnesio también juega un papel en el metabolismo normal de lípidos, proteínas y carbohidratos y actúa como cofactor en un gran número de reacciones enzimáticas y metabólicas (Davis and Lawrence, 1997). En tanto que el potasio también es importante por
la activación de la Na+- K+ -ATPasa (Mantel y Farmer, 1983), el cual es un componente clave en la regulación del volumen intracelular. Se ha demostrado que la falta de una mezcla necesaria de iones esenciales, incluidos K+ y Mg+2 limita el crecimiento y la supervivencia de las postlarvas de camarones en la aclimatación (Saoud et al. 2003) así como durante el engorde (Davis et al. 2005). Tales imbalances iónicos en el medio externo puede conducir a deficiencia iónica en el camarón, lo cual podría ser una de las razones para el síndrome del músculo acalambrado (Johnson 1995) y mortalidad asociada a la muda (Gong et al. 2004).
En general, los productores han empleado dos estrategias para mejorar el crecimiento y la supervivencia de L. vannamei criado en aguas desbalanceadas iónicamente especialmente K+ y Mg+2. Estas estrategias
incluyen enfoques de suplementación de las sales de estos minerales al agua para hacerlo más aceptable para la producción de camarones (McGraw y Scarpa 2003; Roy et al. 2007a) y de adición de minerales a las dietas ofrecidas a los camarones para mejorar la capacidad osmorreguladora. La suplementación dietética puede ser más eficiente y económica que la adición de los minerales al agua.
Todo esto ha generado que los cultivos se desarrollen a una mayor densidad que los tradicionalmente producidos en Ecuador en agua salada y en algunos casos bajo recirculación lo que ha llevado a la necesidad de diseñar alimentos que cubran las necesidades del camarón para estas condiciones de agua dulce o iónicamente imbalanceadas con densidades de siembra mayores a 30/m2
Varios estudios han reportado los beneficios del uso de ácidos orgánicos, aceites esenciales e inmunomoduladores para mejorar el crecimiento, la eficiencia alimenticia y el estado de salud de los camarones, que puede ser de mayor relevancia en sistemas de cultivo intensivo y más aún en condiciones de cero salinidad donde el camarón tiene un desafío adicional para mantener la capacidad osmoregulatoria.
El objetivo de este estudio fue evaluar en cultivo de agua dulce a alta densidad, el efecto de incluir aditivos antimicrobianos en alimentos balanceados iónicamente sobre el rendimiento de juveniles Litopenaeus vannamei.
El estudio se realizó en la Estación de Validación Skretting (SVS) para agua dulce, ubicada en la finca camaronera Seagate, en el sector cercano a Yaguachi, provincia de Guayas, Ecuador.


La fase de pre cría/vivero se realizó en estanques de 1.5-1.8 ha, donde se sembraron 7 millones de camarones. El muestreo de peso para determinar la tasa de crecimiento fue realizado cada 48 horas mientras que el muestreo poblacional fue de revisión constante (similar a raceways), en busca de evidencias de signos
pre-evento, baja alimentación, entre otros.
En la fase de engorde, los estanques con las dimensiones indicadas en la tabla 2 tenían una profundidad de 150 cm. Para este ciclo de producción, el agua se bombeó desde un recirculador a un canal de depósito y luego se pasó a través de un regulador ajustable hasta el estanque. La densidad de siembra fue de alrededor de 630,000 camarones/ha para cada uno cuatro de los estanques (E1 a E4).


Para soportar la demanda de oxígeno debido a la mayor biomasa se utilizaron aireadores de ocho paletas de 3 HP (Diva®) a razón de 12 HP/ ha en los estanques E1 - E4. En la fase de pre cría/vivero los aireadores se encendieron alrededor de 13 horas al día, desde las 18h00 hasta las 07h00 del día siguiente mientras que en la fase de engorde según
el nivel de oxígeno presente en el estanque los aireadores se encendieron inicialmente de 18h00 a 07h00 del día siguiente y finalmente de 16h00 a 10h00 del día siguiente.
Para contrarrestar las bajas proporciones de Na+: K+ y Mg+2: Ca+2 en el agua, la suplementación de las sales de estos iones se realizó al inicio en la fase de pre cría que se complementó con la adición de estos minerales a todos los alimentos suministrados en esta evaluación; permitiendo así que los camarones continuamente absorban estos iones en el tracto digestivo contribuyendo al balance iónico a nivel fisiológico.
A fin de demostrar la factibilidad técnica y económica, se llevó a cabo una producción a alta densidad, en un sistema de recirculación cerrado de agua dulce. La viabilidad
del cultivo intensivo (63 camarones/ m2) de Litopenaeus vannamei en un ambiente de cero salinidad, se investigó comparando dos programas de alimentación. Cuatro estanques fueron utilizados en esta prueba, E1 y E3 se suministraron los alimentos LOR desde 0.5 hasta los 5g y OPT desde 5g hasta cosecha mientras que en los estanques E2 y E4 se les asignó el alimento LOR desde 0.5 hasta la cosecha. Todos los alimentos suministrados fueron formulados para baja salinidad con la misma composición nutricional con la diferencia que el alimento LOR contenía una combinación de aditivos funcionales con propiedades antibacteriales. En este ciclo, mediante un modelo basado en algoritmos, se calculó diariamente la cantidad de alimento a suministrar a los estanques en función de las condiciones ambientales del día (oxígeno, temperatura, salinidad, pH) hasta que los camarones alcanzaran los 5 g. Mediante un modelo basado en algoritmos se calculó diariamente la cantidad de alimento a suministrar a los estanques en función de las condiciones ambientales del día (oxígeno, temperatura, salinidad, pH) hasta que los camarones alcanzaran los 5 g. La alimentación fue manual hasta los 2g, para pasar a ser suministrada mediante alimentadores automáticos (EruvakaTM) temporizados hasta los 5g, a partir de ese peso los alimentadores pasaron a modo sónico donde la cantidad de alimento liberada desde la tolva dependía de la intensidad del sonido de masticación del camarón capturado por el hidrófono. Dependiendo del estanque, se colocaron diferentes cantidades de alimentadores automáticos en cada estanque (Tabla 2).
Así como se cambió de forma de alimentar, también se modificó
el tamaño del alimento para camarones que estaban en el rango de peso de 0.5 – 2g; 2.1 – 5g y de 5.1g a cosecha a los que se les suministró alimento extruido con los siguientes diámetros 1.2mm, 1.6mm y 1.9mm, respectivamente.


El oxígeno y la temperatura se midieron con un oxímetro YSI® Pro 20, dos veces al día y también se hizo un registro continuo mediante el uso de sensores remotos. Para efectos de esta publicación se presenta los promedios de las 05h00 y 17h00 como se muestra en la tabla 1.
Este ciclo de producción se llevó a cabo entre octubre de 2020 y febrero de 2021. Dependiendo de la fecha de siembra de los estanques, el ciclo de producción estuvo entre 127 y 130 días. Aunque no se encontraron diferencias estadísticas (p>0.05), en todos los parámetros zootécnicos
medidos como peso final, tasa de crecimiento, supervivencia, factor de conversión alimenticia (FCA) y producción, se observó una ligera diferencia entre los tratamientos dietéticos. Al final del ciclo de producción, los resultados de la alimentación muestran un aumento promedio de alrededor del 8% y 10% en la supervivencia y el rendimiento, respectivamente, en los estanques alimentados con LOR (Tabla 2). Además, una reducción de alrededor del 8% en FCA en comparación con OPT.
En cuanto a la demanda de alimento calculada como porcentaje de biomasa cosechada, se observó un consumo levemente mayor para el grupo de camarones abastecidos con alimento OPT, aunque esto podría ser consecuencia de la pérdida de población.
Independientemente del alimento evaluado, los estanques E3 y E4 presentaron una mayor producción

y rendimiento en comparación con sus respectivos estanques réplica (E1 y E2); lo que podría deberse principalmente a que contaban con un alimentador automático más (Tabla 2). Aunque no se descarta que habiendo cosechado 1-2 días antes los estanques E3 y E4, pudieron haber perdido menos población en un momento en que el oxígeno se vuelve más crítico porque está en el límite de la capacidad de carga de los estanques.
El peso determinado en cada cosecha parcial, así como en la cosecha final, no fue diferente entre ambos alimentos como se muestra en la figura 1. El suministro de cualquiera de los dos alimentos OPT o LOR produjo una tasa de crecimiento similar (g/semana), cuyo incremento ocurrió a medida que los camarones aumentaron de peso, siendo una
tasa de 1,8g/semana hasta 18g y 2g/ semana, en camarones de 30g en adelante (Fig. 2).


El análisis económico mostró que el costo total de producción en este ciclo con LOR fue de aproximadamente $1.500/ha más que los alimentados con OPT; por lo que el punto de equilibrio para evitar perder dinero es más alto de alcanzar en comparación con LOR. Bajo este escenario se encontró un mayor retorno en aproximadamente $72/ ha-día para LOR versus $65/ha-día para OPT (Tabla 3). El margen de ventas también favoreció al alimento LOR.
Los datos generados en esta validación muestran que la inclusión de aditivos funcionales con propiedades antibacteriales en el alimento LOR

mejora el rendimiento del camarón, logrando un mayor beneficio económico. Los hallazgos reportados muestran que la determinación de la cantidad diaria de alimento desde que se sembró hasta los 5 g, usando modelos de algoritmos y en adelante la alimentación con el alimentador acústico fueron adecuados para sostener el crecimiento del camarón. Esta estrategia de alimentación, junto con el monitoreo continuo de parámetros ambientales como el oxígeno y con una adecuada práctica de manejo, pueden superar las utilidades obtenidas con una forma tradicional de producción de camarón bajo alta densidad de población en agua dulce. Un programa de alimentación que involucre el alimento LOR junto con adecuado manejo tiene mucho potencial para definir nuevas estrategias de alimentación; lo que significaría un ahorro sustentable que, a su vez, permitiría maximizar los resultados productivos a un costo mínimo, en tiempos que es necesario reducir los costos de la libra de camarón producido.
Los resultados también demuestran que el uso de alimentos fabricados con K+ y Mg+2 puede sostener producciones en sistemas de re-circulación de agua dulce que minimizan las variaciones en calidad de agua, reduce la contaminación del agua, al tiempo que disminuye la degradación ambiental.
El grado de control que se tiene de las operaciones en una finca camaronera es consistente con la reducción de costos, por lo que la inversión en tecnología y mejoramiento nutricional son clave para enfrentar los escenarios desafiantes.
*Más información: https://www.skretting.com/es-EC/ Referencias utilizadas por los autores en el artículo disponibles bajo previa solicitud a nuestro equipo editorial.
[ Esta investigación desarrollada por catedráticos de la Universidad de Guayaquil, la Universidad Agraria del Ecuador y la Pontificia Universidad Católica Argentina busca contribuir al conocimiento de nuevos métodos de alimentación del camarón para fortalecer la competitividad de las empresas del sector acuícola. A través de un análisis de resultados en dos estanques con diferentes métodos de alimentación se estudian los efectos del empleo de tecnología en la camaronicultura en la mano de obra dedicada a la alimentación, el aumento del crecimiento del camarón y la disminución de la tasa de conversión del alimento (FCR).

El negocio medular del sector camaronero se fundamenta en el proceso de engorde o generación de biomasa del camarón. En el proceso de cultivo de camarón mientras “a mayor velocidad coman los organismos” se produce mayor biomasa por hectárea de cultivo, lo que conlleva a mayores ganancias económicas en menor tiempo y un aumento considerable de la sobrevivencia de los animales en el estanque.
La tecnificación ha generado un mayor dinamismo que se observa claramente en las exportaciones de camarón, lo que atrae más inversión al sector. Alimentadores automáticos y sistemas de energía más eficientes forman parte del desarrollo para mejorar la producción. Los modernos equipos trabajan a través de un hidrófono, que se refiere a un sensor que capta la actividad del camarón y determina en qué momento esparcir el producto balanceado para su alimentación. Este mecanismo, permite que el ciclo de producción del camarón disminuya de 120 días a 90 días.

Las condiciones de cultivo influyen directamente sobre la tasa de crecimiento que, junto con el sistema de cultivo empleado, determinan los rendimientos, por lo que constantemente en la camaronicultura se trata de buscar sistemas económicos que garanticen una buena calidad del producto final. En este sentido, el objetivo general de esta investigación es contribuir al conocimiento de nuevos métodos de alimentación para el cultivo de camarón, logrando competitividad de las empresas del sector acuícola.

El apetito de los camarones varía mucho dependiendo de los niveles de oxígeno que provea el estanque donde se cultivan. Factores como el ciclo lunar, la fluctuación de la temperatura, la columna de agua y los tipos de dieta, influyen mucho en la alimentación de esta especie. Es precisamente el hecho de que,
en el método de “voleo” los horarios de ingesta de los crustáceos no coinciden con los del personal encargado de realizar la alimentación tradicional, la razón por la cual los alimentadores automáticos juegan un rol muy importante.
El aporte de las nuevas tecnologías en la alimentación eficiente de camarones
El conocimiento de la biomasa es un elemento esencial en el sistema productivo ya que permite determinar la cantidad de alimento, la tasa de intercambio de agua y evaluar la situación de los estanques y de la camaronera en general. Estos datos permiten además decidir si un estanque puede o no ser cosechado.
Con esto en mente, la variedad de soluciones para el control alimenticio, incluyen detectores infrarrojos de pellet, sistemas de cámaras submarinas, sistemas de detección de hidrófonos (utilizando el sonido de los peces / crustáceos “comiendo” como un indicador de la ingesta de alimento) y sensores de oxígeno disuelto, que pueden ser utilizados para regular el consumo de alimento.
Los alimentadores automáticos son exitosos en factores como la reducción del tiempo y la energía necesaria para la alimentación de los camarones, incluyen actividades como el monitoreo y recolección de datos, la retroalimentación acústica, entre otros. En particular, la gama de soluciones de AQ1 Systems, permite que las raciones queden ajustadas de inmediato a las variaciones del apetito de la biomasa de camarones en cada estanque, cada día, cada minuto. Mientras que el SF200, es una caja de control electrónica donde un software analiza la información en directo procedente de hidrófonos, que permite que el cien por ciento de la calidad alimenticia de los alimentos balanceados, sea aprovechado por los organismos cultivados.
En países donde los estanques de producción presentan vibriosis, el uso de esta tecnología puede mejorar significativamente la sobrevivencia, al no dejar alimento balanceado en el fondo durante varias horas. Esto se debe a que fondos con menos materia orgánica, representan un aporte adicional importante al manejo eco sostenible del cultivo del camarón.
El conocimiento de la biomasa es un elemento esencial en el sistema productivo ya que permite determinar la cantidad de alimento, la tasa de intercambio de agua y evaluar la situación de los estanques y de la camaronera en general para decidir si un estanque puede o no ser cosechado.
Resultados obtenidos de investigación y observación directa Los resultados de las pruebas de un ciclo de producción del 2017 en dos estanques con diferentes métodos de alimentación en una camaronera local privada, la revisión de las infraestructuras tecnológicas y las pruebas de los métodos de alimentación estudiados, permiten confirmar que el empleo de tecnología digital en la producción de camarón permite la reducción de la mano de obra dedicada a la alimentación, aumento del crecimiento del camarón y la disminución de la tasa de conversión del alimento (FCR).
El estanque que posee alimentadores automatizados contempla un proceso de alimentación mucho más eficiente, generando mayor biomasa en el crustáceo en menor tiempo. Se evidencia que en el rango de horas de media mañana hasta parte de la noche, es el horario en el cual los animales prefieren alimentarse, donde factores como el nivel de oxígeno de los estanques es un elemento muy importante a considerar. En horas de la tarde y noche los niveles de oxígeno son mayores, lo que implica que en ese período se presenta la mayor actividad alimenticia de los camarones, en especial hacia las horas de la noche.
Esto también se verá influenciado por la profundidad a la que se encuentra el alimentador, lo que juega un papel importante al momento en el que los crustáceos deciden alimentarse. Dependiendo del nivel de profundidad, encontrarán un mayor nivel de oxígeno en el área y esto determinará su preferencia para a agruparse en uno u otro alimentador.
Al comparar los días que se emplean para realizar el proceso de cultivo de los camarones, con métodos tradicionales y sistematizados, se evidencia que las libras cosechadas en las camaroneras que cuentan con el sistema de alimentación sistematizado son conside-
rablemente más productivas que aquellas donde se aplican métodos tradicionales de alimentación. En este sentido, aplicando el método AQ1, se favorece el incremento de la biomasa de los crustáceos para ser cosechados en un menor tiempo. Todo esto, favorece de forma positiva al sector camaronero que ha incluido la sistematización de la alimentación.
Es así, como la sistematización y tecnificación en el proceso de alimentación de los camarones ha conseguido incrementar y mejorar significativamente los niveles de producción en el sector, logrando tener camarones con mayor tamaño y peso en menor tiempo y un marcado decrecimiento en el índice de mortandad por contaminación de los estanques. De esta forma, es posible recuperar la inversión realizada de forma muy rápida con la inclusión de la tecnología.
Influencia de control automatizado en la cosecha Se comprobó que existe un aumento de la producción en relación con el tamaño del estanque, mostrando un incremento en ese indicador.
La ración o dosis de alimento balanceado, así como la calidad de la alimentación en un sistema tradicional, se encuentra muy por debajo de la obtenida en estanques que poseen sistemas de alimentación tecnificados. Con la ventaja de que, en estos últimos, los camarones se alimentan cada vez que tengan hambre, o cuando los niveles de oxígeno, temperatura o
condiciones climáticas lo requieran. Sumado a esto, en los alimentadores que tienen una mejor oxigenación se concentra la mayor cantidad de camarones a alimentarse. Mientras que con los procesos tradicionales de alimentación se obtiene un poco más de una libra de camarón, con los tecnificados se llega a las dos libras por cada libra de alimento usado.
Los alimentadores automáticos incrementan notablemente las tres condiciones más importantes del cultivo de camarón que son: crecimiento, conversión alimenticia y sobrevivencia. Los comportamientos indicados alrededor de estas variables, en estanques donde ya se han empleado estos equipos, alcanzan mejoras del 20% al 30% y hasta del 40% en relación con otros estaques no tecnificados. De acuerdo con estas observaciones, la inversión inicial de implementación puede retornar en un lapso de 4 a 8 meses dependiendo de las características de cultivo y geografía de la finca camaronera que implementa los equipos. En cualquier caso, los sistemas automatizados proveen mayor control de parámetros, lo que redunda en la alternativa de aprovechar totalmente los recursos alimenticios en el cultivo de camarón.
Soluciones como el AQ1 Systems, resultan muy adecuadas para grandes estanques, ya que están diseñados para distribuir alimento en un radio de aproximadamente 10

La variedad de soluciones para el control alimenticio incluye detectores infrarrojos de pellet, sistemas de cámaras submarinas, sistemas de detección de hidrófonos y sensores de oxígeno disuelto, que pueden ser utilizados para regular el consumo de alimento.
m. La eficiencia de una máquina de alimentación se relaciona con el tamaño y la forma del estanque. Al lograr una mejor operatividad de estos equipos, resultan ser más útiles para la fase de engorde, con alguna sencilla adaptación, también puedan ser usados para alimentar camarones de menos de 3 gramos con buena eficiencia.

Un alimentador automático para camarón puede ayudar a resolver los problemas de la alimentación manual o “voleo”. Con estos equipos se puede aumentar el número de alimentaciones en un día y dar las mayores raciones de balanceado ya que es importante destacar que los camarones comen cuando lo desean y no cuando su alimentador lo quiere, aprovechando el ritmo circadiano involucrado en el proceso digestivo del camarón.
Es importante considerar que los ingresos y la productividad mejoran en la medida que se incrementa la inversión en tecnología y en genética. En tal sentido, además
de los alimentadores automáticos, es importante contemplar otros aspectos importantes que influyen en el crecimiento del sector. Un ejemplo claro está representado por los laboratorios de maduración de los “nauplios” que son los organismos previos a las larvas, necesarios para producir para realizar la siembra de las larvas en los estanques. Aumentando la disponibilidad de este tipo de locaciones e implementando recursos tecnológicos que mejoren esta etapa del proceso, es posible generar larvas más fuertes y resistentes a las enfermedades.
Se ha evidenciado que con el uso de tecnología digital en la producción de camarón existe un incremento aproximado del 62.22% de la producción camaronera y una disminución de 45% del tiempo de cosecha y un 25% de disminución del índice de mortandad, lo cual genera mayores utilidades.
Finalmente, una amplia y detallada revisión de los sistemas existentes demuestra que la implementación de nuevos recursos es un mecanismo para poder ingresar a mercados antes inaccesibles. De esta forma, especies como el “Penaeus Vannamei” han alcanzado y pueden ampliar su cobertura en mercados de países europeos y asiáticos.
*Esta es una versión divulgativa desarrollada por el equipo editorial de Panorama Acuícola Magazine del artículo “Nuevas soluciones para el control alimenticio del camarón” autoría de: MSc. Michelle Agustina Varas Chiquito, Mgs. Marcos Espinoza Mina y MSc. Leslie León Bassantes publicado en Septiembre de 2018 a través de Research Gate.
Email de correspondencia de los autores: michelle.varasch@ug.edu.ec, mespinoza@uagraria.edu.ec, leslie.leonb@ug.edu.ec
El objetivo de este estudio fue evaluar la capacidad inhibitoria de ME-PRO® a diferentes concentraciones (0,5%, 1% y 2%) frente a Vibrios spp. extraídos del intestino medio del camarón blanco del Pacífico Litopenaeusvannamei . Este estudio se realizó en el Laboratorio de Microbiología y Biología Molecular, QSBIOTECH, ubicado en La Libertad, provincia de Santa Elena, Ecuador.
Por: Sergio F. Nates, Ph.D. Prairie Aquatech y Darwin Zambrano, QSBIOTECH *La enfermedad de necrosis hepatopancreática aguda (AHPND) o el síndrome de mortalidad temprana (EMS) se han asociado con Vibrio parahaemolyticus. AHPND se ha extendido al hemisferio occidental y surgió en México a principios de 2013. Desde el primer caso reportado en el sur de China en 2009, AHPND también se ha observado en granjas camaroneras en otras partes de Asia y América. Los brotes de AHPND han causado graves daños a la industria mundial del cultivo de camarón con pérdidas anuales de más de mil millones de dólares.
En el 2017 se reportaron los primeros casos de AHPND en Ecuador con niveles de V. parahaemolyticus y V. vulnificus de 3x104 UFC/g y mortalidades de hasta el 100% en tanques de cultivo larvario. La enfermedad afecta a las larvas en etapas tempranas con mortalidades de hasta el 100%, mientras que en los camarones juveniles se han reportado mortalidades del 30-40% durante los primeros 20-30 días después de la siembra.

Para compensar la alta mortalidad de AHPND, se han incorporado suplementos a las dietas. Estos incluyen una amplia variedad de probióticos y productos como ácidos orgánicos, aceites esenciales, biomoléculas y en algunos casos, antibióticos. Por otro lado, los diagnósticos moleculares desarrollados en los últimos años han permitido determinar la presencia y cuantificación de cargas de Vibrio mediante PCR, utilizando primers específicos para detectar la toxina AP4. Además, también se desarrolló un medio más específico (ChromAgar) para diferenciar el crecimiento de varias cepas de Vibrio.
Un ingrediente funcional prometedor
Estudios recientes sobre el desarrollo de dietas prácticas para sistemas de producción de camarón que utilizan una proteína mejorada microbiana, ME-PRO® (Prairie Aquatech, Dakota del Sur, EE. UU.), han demostrado ser una solución prometedora para producir alimentos acuícolas sustentables. La proteína se procesa en una planta de última generación utilizando harina de soya no transgénica (no modificada genéticamente) y un hongo natural, no toxigénico, Aureobasidium pullulans. El co-producto fermentado también ofrece cantidades significativas de péptidos de cadena corta y aminoácidos libres que confieren excelentes propiedades de atractabilidad y palatabilidad. Los resultados de numerosos ensayos de alimentación han demostrado que este producto ME-PRO® puede mantener la salud del camarón, el crecimiento de alto rendimiento y la eficiencia alimenticia con niveles de inclusión de hasta el 50% de la cantidad total de ingredientes en la dieta.
El objetivo de este estudio fue evaluar la capacidad inhibitoria de ME-PRO® a diferentes concentraciones (0,5%, 1% y 2%) frente a Vibrios spp. extraídos del intestino medio del camarón blanco del Pacífico Litopenaeus vannamei . Este estudio se realizó en el Laboratorio de Microbiología y Biología Molecular, QSBIOTECH, ubicado en La Libertad, provincia de Santa Elena, Ecuador.
Muestras de ME-PRO® se obtuvieron de Prairie Aquatech. Las sub-muestras se re-suspendieron en agua destilada a las dosis de prueba. Para la obtención de los aislamientos bacterianos se prepararon macerados de larvas completas de camarón L. vannamei con síntomas de la enfermedad.
Para la obtención de los aislados bacterianos, siembra de macerados de larvas de camarón con síntomas de enfermedad y pruebas con

las cepas probióticas, se tuvo que preparar varios medios de cultivos TCBS, ChromAgar Vibrio, TSA y TSB.
Para el análisis de Vibrios totales se preparó TCBS marca Difco, suplementado con 2% de cloruro de sodio e incubado a 35ºC por 24hrs. Se pesó 89 gr. del medio deshidratado hasta completar 1 lt. con agua destilada, regulado a un pH 8,6 de la solución. Se calentó hasta punto de ebullición a 100ºC con agitación frecuente por 2 minutos. Luego se colocó la solución en placas estériles hasta que se solidifique el agar y se guardaron a 2-8ºC hasta su uso.
Por otra parte, para los aislados de Vibrio parahaemolyticus y V. vulnificus, se usó el medio ChromAgar Vibrio. Se pesó 74,7 gr. del agar en polvo hasta completar 1 lt. con agua destilada, se homogenizó y llevó a calentamiento hasta ebullición a 100ºC.

Para el aislamiento, purificación y pruebas de crecimiento con cepas probióticas, se usó el medio TSA marca Difco. Se pesó 40 gr. del agar en polvo hasta completar 1 lt. con agua destilada. Se homogenizó por calentamiento durante 2 minutos. Posteriormente, se colocó la solución en placas y se llevó a esterilizar al autoclave a 121ºC durante 15 minutos.
Para el aislamiento, purificación y pruebas de crecimiento con cepas de Vibrio parahaemolyticus, V. vulnificus y probióticas se usó el medio TSB marca Difco. Se pesó 30 gr. del agar en polvo hasta completar 1 lt. con agua destilada, se homogenizó por calentamiento durante 2 minutos. Posteriormente, se colocó la solución en placas y se llevó a esterilizar al autoclave a 121ºC durante 15 minutos.
A todos los agares y medios líquidos utilizados, se les incorporó ME-PRO® a concentraciones de
0,5%, 1% y 2%. Además se realizaron pruebas con ME-PRO® y se incorporaron a concentraciones del 5%, 10% y 15%. Todas estas incorporaciones en los medios de cultivo a las concentraciones indicadas, se utilizaron para las evaluaciones de crecimiento per ce en muestras de larvas y para medir el efecto frente a Vibrio parahaemolyticus y cuatro probióticos comerciales.

Se pesó y se maceró 0,1 gr. de muestra de post larva viva en una resuspensión de 200 ul de agua destilada estéril y se depositó 50ul de la muestra en agar TCBS y ChromAgar. Todas las bacterias Vibrio y los probióticos se resuspendieron en medio TSB. Se sembró 50 ul de la solución en las placas de agar TSA para el caso de probióticos y en ChromAgar
co-producto fermentado también ofrece cantidades significativas de péptidos de cadena corta y aminoácidos libres que confieren excelentes propiedades de atractabilidad y palatabilidad.
En Ecuador, se ha determinado que la asociación de V.parahaemolyticus y V. vulnificus a niveles de 104 UFC / g es causa de alta mortalidad.
para el caso de los vibrios. Los resultados de conteos del crecimiento de bacterias en agares, se expresaron en unidades formadoras de colonia UFC por gr. para macerados de larvas y ml. para las resuspensiones. Mientras que, se realizó una curva de crecimiento de Vibrios y probióticos por lecturas de su DO a 600nm en un Fotómetro 9300 (Serial 71005190032) estos se expresaron en cell/ml.
La técnica de Reacción de la Cadena de la Polimerasa o PCR, utilizó un protocolo de extracción de ADN lysis buffer. Los primers utilizados fueron con el metodo AP4 (Flegel; 2015), la secuencia F1: ATGAGTAACAATATAAAACATGAAAC; R1: ACGATTTCGACGTTCCCCAA; F2 TTGAGAATACGGGACGTGGG.

Las condiciones de amplificación en el termociclador MiniAmp Plus: Desnaturalización 94oC x 0:30 seg; Hibridación 55oC x 0:30 seg ; Polimerización 72oC x 1:45 min. 25 Ciclos tanto para la primera y segunda PCR.
Los resultados de muestras de larvas con síntomas, recibidas en el laboratorio de análisis QSBiotech, se procesaron para el diagnóstico de la presencia y determinación de vibrios totales y específicos como vibrio parahaemolyticus y vulnificus, que es un protocolo para la compra de larvas según el estado de salud que presenten. Durante una semana se procesaron 5 muestras de larvas vivas procedentes de laboratorios comerciales con síntomas de enfermedad, se incorporó ME-PRO® por inclusión en los medios de cultivo TCBS y ChromAgar. Los resultados obtenidos de esta evaluación demostraron, que el MEPRO B desde 0,5% tiene actividad de inhibición del 100% de vibrios tipo1 (amarillas), tipo2 (verdes) y de V. parahaemolyticus. Por otra parte, el MEPRO A en las dosis de 0,5%, 1% y 2% presenta actividad de inhibición de los vibrios tipo1 (amarillas) entre 38%, 48% y 57% respectivamente. Para los vibrios tipo 2, la tasa de inhibición fue del 78% y del 100% para las dosis del 1 y 2%. Mientras que, para V. parahaemolyticus, en 38%, 45% y 62% respectivamente (Ver Figuras 1, 2 & 3).
Se aislaron tres cepas asociadas a EMS de muestras de larvas, se cultivaron en ChromAgar y TCBS y se analizaron mediante PCR. Además, se cultivó una cepa de V. parahaemolyticus (VP AHPND) en medio TSB líquido con la inclusión de ME-PRO® al 1 y 2%. Cada seis horas se inocularon placas de Petri para verificar la dinámica de las bacterias y el efecto de la proteína microbiana mejorada ME-PRO® sobre el crecimiento de las bacterias. Los
resultados mostraron que ME-PRO® al 1 y 2% en el tiempo cero tuvo un efecto de inhibición del 27%. El crecimiento de V. parahaemolyticus se ve comprometido después de las primeras seis horas de cultivo para ambas dosis con una reducción del 40% en el crecimiento. A las 12 horas hay una ligera recuperación y a las 18 horas, el crecimiento de las bacterias de reactivación vuelve a la normalidad (Figura 4).

Inhibición de V. vulnificus Se aislaron cepas de V. vulnificus

La evaluación en este estudio indicó que un nivel de inclusión tan bajo como 1% de ME-PRO® mejora la resistencia a V.parahaemolyticus y V. vulnificus asociadas con una alta mortalidad en la acuicultura de camarón.
de muestras de larvas con signos de enfermedad y se utilizaron en esta prueba. En Ecuador, se ha determinado que la asociación de V. parahaemolyticus y V. vulnificus a niveles de 104 UFC / g es causa de alta mortalidad. Las cepas de V. parahaemolyticus y V. vulnificus se resuspendieron y se incubaron para reactivar durante 1 hora a 32oC en medio de cultivo TSB con la inclusión de ME-PRO® al 5%, 10% y 15%. Las incubaciones se llevaron a cabo inmediatamente en ChromAgar Vibrio para determinar el efecto sobre el crecimiento de bacterias. Los resultados mostraron que ME-PRO® al 10% puede afectar fuertemente la tasa de crecimiento de V. vulnificus con una reducción del 72% en las poblaciones de bacterias a las 18 horas. Al nivel de inclusión del 15%, la tasa de crecimiento de V. parahaemolyticus se reduce significativamente hasta un 63% (Figura 5).

Para esta prueba se utilizó la cepa VPQB020 (V. parahaemolyticus) previamente identificada por PCR. Las bacterias se cultivaron en ChromAgar Vibrio con niveles de inclusión ME-PRO® de 1% y 2%. Se contaron las UFC en placas y se realizó PCR de cada una de las bacterias que crecieron en el medio de cultivo a los diferentes niveles de inclusión.
Los resultados de la amplificación por PCR utilizando los primers de la toxina VP4 indicaron la detección de AHNPD en las muestras 1 y 2. Mientras que las muestras 3-5 fueron negativas. Los controles de extracción, PCR y control de PCR positivo fueron excelentes (Figura 6).
Los resultados de los recuentos de UFC bacterianas determinaron que un nivel de inclusión del 2% de ME-PRO® inhibe el crecimiento de la carga de V. parahaemolyticus hasta en un 50%, lo que también resulta en una PCR negativa para la toxina AP4 (ver Tabla 1).
Se llevó a cabo una evaluación de la actividad inhibidora de ME-PRO®
a niveles de inclusión de 1% y 2% frente a tres cepas de probióticos comerciales. Las cepas se reactivaron en medio de cultivo TSB a dos dosis y se incubaron a 30oC durante 24 horas. Posteriormente, las muestras se incubaron cada 6 horas en medio TSA sin sal. Los resultados fueron las lecturas de UFC y los niveles de bacterias contados en las placas de agar frente a los recuentos de UFC obtenidos en los controles. Los probióticos comerciales muestran una inhibición del 71%, 38% y 6% con ME-PRO® al 1%, mientras que al 2% fue del 72%, 44% y 8%.
La actividad antimicrobiana contra varios patógenos bacterianos del camarón, incluidos V. vulnificus y V. parahaemolyticus (cepa AHPND), se determinó utilizando diferentes niveles de inclusión de ME-PRO®. La evaluación en este estudio indicó que un nivel de inclusión tan bajo como 1% de ME-PRO® mejora la resistencia a V. vulnificus y V. parahaemolyticus asociadas con una alta mortalidad en la acuicultura de camarón. Al igual que en estudios anteriores llevados a
cabo en Vietnam, los resultados confirmaron que la suplementación con la adición de ME-PRO® en la dieta del camarón blanco, L. vannamei, confiere un efecto protector contra las especies de Vibrio asociadas con EMS.
*Más información: https://prairieaquatech.com/

Este experimento desarrollado por investigadores de Vietnam se llevó a cabo para comprobar la hipótesis de que la adición de carbono, nitrógeno y fósforo (CNP) a un medio acuático influye en el crecimiento de la bacteria V.parahaemolyticus , y si las tres cepas de BL seleccionadas para ser añadidas al alimento pueden mejorar el crecimiento, la tasa de supervivencia, la composición y el número de células hemocitarias, así como prevenir la AHPND en el camarón blanco (P.vannamei)

La enfermedad de la necrosis hepatopancreática aguda (AHPND) causada por la bacteria Vibrio parahaemolyticus , ha costado a la cría de camarón en aguas salobres más
de mil millones de dólares al año. Esta enfermedad suele aparecer después de 14 días de administrar productos que contienen trehalosa, ácido glutámico y sales de fosfato. La hipótesis es que la adición de
estas sustancias puede estimular el crecimiento de la bacteria V. parahaemolyticus
Para frenar la AHPND, se utilizan bacterias del ácido láctico (BL) mezcladas con bacterias V. para-
Efectos del alimento mezclado con bacterias del ácido láctico y del carbono, nitrógeno y fósforo suministrados al agua, sobre la tasa de crecimiento y supervivencia del camarón de pata blanca (Penaeusvannamei) infectado con la enfermedad de la necrosis hepatopancreática aguda causada por Vibrioparahaemolyticus
V.parahaemolyticus suele aparecer después de 14 días de administrar productos que contienen trehalosa, ácido glutámico y sales de fosfato, la hipótesis es que la adición de estas sustancias puede estimular el crecimiento de la bacteria.
haemolyticus en el alimento que, además, es uno de los métodos utilizados para mejorar el crecimiento de los camarones, mejorar su sistema inmunológico y prevenir enfermedades. En el presente estudio, la bacteria heterotrófica objetivo V. parahaemolyticus es el patógeno de emergencia en los camarones, y la fuente de carbono utilizada, la trehalosa, es el nutriente adecuado para el crecimiento de Vibrio parahaemolytius.
Este experimento se llevó a cabo para comprobar la hipótesis de que la adición de carbono, nitrógeno y fósforo (CNP) a un medio acuático influye en el crecimiento de la bacteria V. parahaemolyticus , y si las tres cepas de BL seleccionadas para ser añadidas al alimento pueden mejorar el crecimiento, la tasa de supervivencia, la composición y el número de células hemocitarias, y también prevenir la AHPND en el camarón de patas blancas (P. vannamei)
Antes de poner en marcha el experimento, se examinaron postlarvas de 15 días de edad, para seleccionar lotes de camarones negativos a los patógenos WSSV, microsporidia y AHPND. Se aisló una cepa de V. parahaemolyticus portadora de un gen virulento causante de AHPND. Esta cepa bacteriana se recuperó en medio de caldo nutritivo.
El experimento fue un diseño completamente aleatorizado e incluía cuatro tratamientos, con tres réplicas para cada uno. En el tratamiento de control, los camarones fueron alimentados con una dieta normal, sin contener LAB; para los tratamientos LAB1, LAB2 y LAB3, los camarones fueron alimentados con piensos que contenían L. plantarum, L. fermentum y Pediococcus pentosaceus
El segundo experimento se llevó a cabo para determinar los efectos de las dietas que contenían BL y el CNP suministrado al agua sobre la tasa de supervivencia y los recuentos de hemocitos dife-
renciales y hemocitos totales de los camarones P. vannamei bajo la condición de desafío con la bacteria V. parahaemolyticus
Efectos de las dietas que contienen LAB
Los resultados experimentales mostraron que el crecimiento del camarón en longitud y peso fue significativamente diferente entre el tratamiento control y los otros tratamientos. Después de 30 días del experimento, la tasa de supervivencia de los camarones alcanzó más del 90% en todos los tratamientos. El tratamiento con la tasa de supervivencia más alta fue el LAB1 (99.4%), mientras que la más baja fue la del tratamiento de control (97.2%).
Por otra parte, el THC, GC y HC de los camarones en los tratamientos LAB1, LAB2 y LAB3 fueron bastante altos y significativamente diferentes en comparación con los del tratamiento de control. Se podría concluir que el uso de L. plantarum, L. fermentum y P. pentosaceus tiene el potencial de mejorar la inmunidad innata del camarón de patas blancas (P. vannamei) , especialmente L. plantarum . Además, el THC, el GC y el HC de los camarones al inicio del experimento fueron significativamente diferentes entre los tratamientos de control y los tratamientos alimentados con dietas que contenían LAB.
Dado que los camarones derivados del primer experimento se utilizaron para el segundo, los tratamientos en los que los camarones fueron alimentados con dietas que contenían BL, estimularon la inmunidad de los camarones; por lo tanto, el THC, GC y HC fueron
más altos que los de los tratamientos en los que los camarones fueron alimentados con alimntos normales. Después de tres días de desafío con la bacteria V. parahaemolyticus , el THC, GC y HC de los camarones desafiados en todos los tratamientos se redujeron significativamente en comparación con el tratamiento NC.
Al igual que en el primer experimento, el THC, el GC y el HC de los camarones en los tratamientos en los que se alimentó a los organismos con dietas que contenían LAB, fueron significativamente más altos. La inmunidad de los camarones mejoró con las dietas LAB, dado que la bacteria L. plantarum tiene la mejor eficacia para incrementar la inmunidad de los camarones.
Al comparar los tratamientos con y sin CNP suministrado al agua, bajo la condición de ser desafiado con la bacteria V. parahaemolyticus , THC, GC, y HC de los camarones en los tratamientos con CNP suministrado, fueron menores que los de los tratamientos sin CNP suministrado, y la diferencia fue significativa. Los resultados mostraron que el CNP podría intensificar los efectos de V. parahaemolyticus en el hemocito del camarón.
Adicionalmente, la tasa de supervivencia de los camarones en CN fue muy alta (98.3%), lo que demostró que los ejemplares utilizados en el experimento estaban completamente sanos. Mientras tanto, las tasas de supervivencia de los camarones en todos los tratamientos desafiados con la bacteria V. parahaemolyticus fueron inferiores a las del tratamiento NC, y la diferencia fue estadísticamente

significativa, excepto para el tratamiento LAB1.
La diferencia en la tasa de supervivencia de los camarones entre los tratamientos alimentados con dietas que contienen LAB y el tratamiento PC fue estadísticamente significativa. Las dietas que contienen LAB fueron capaces de mejorar la supervivencia de los camarones en condiciones de desafío con la bacteria V. parahaemolyticus . Por su parte, el tejido hepatopancreático de los camarones tres días después de ser desafiados con la bacteria V. parahaemolyticus mostró una estructura anormal con síntomas histológicos típicos de AHPND.
En general, es posible que el agua suministrada con CNP haya intensificado los efectos de la bacteria V. parahaemolyticus . Los camarones que fueron alimentados con dietas que contenían BL, fueron capaces de reducir la morbilidad y mortalidad bajo la condición de ser desafiados con V. parahae-

molyticus , especialmente la dieta que contenía L. plantarum
Análisis de resultados experimentales

Los productos de las LAB, especialmente L. plantarum , incluyendo las bacterias vivas, las bacterias muertas, los extractos libres de células y los alimentos enriqueci-
dos, tienen el efecto de mejorar el crecimiento, la tasa de supervivencia y el FCR de los camarones. Se ha planteado la hipótesis de que el contenido dietético de los probióticos mejora el apetito o estimula la digestibilidad de los organismos. Además, se ha revelado la posible implicación de los probióticos en la mejora del equilibrio de la
La inmunidad de los camarones mejoró con las dietas LAB, dado que la bacteria L.plantarum tiene la mejor eficacia para incrementar la inmunidad de los camarones.
Los productos de las LAB, especialmente L.plantarum, incluyendo las bacterias vivas, las bacterias muertas, los extractos libres de células y los alimentos enriquecidos, tienen el efecto de mejorar el crecimiento, la tasa de supervivencia y el FCR de los camarones.

microbiota intestinal, así como en la producción de enzimas extracelulares, que a su vez mejoran la utilización del alimento y el crecimiento de las especies cultivadas, ya que actúan como promotores del crecimiento.
Además de los efectos positivos en la estimulación del aumento de peso, el uso de L. plantarum, L. fermentum y P. pentosaceus también tiene efectos positivos en la estimulación del sistema inmunitario no específico del camarón de pata blanca. Curiosamente, en presencia de L. plantarum , L. fermen-
tum y P. pentosaceus , el recuento de células sanguíneas y los tipos de glóbulos blancos de los camarones aumentaron. Las células sanguíneas desempeñan un papel importante en el sistema inmunitario no específico de los camarones, con una función específica para cada tipo de células, como las hialinas y los granulocitos, así como con un papel participante en el proceso de coagulación y fagocitosis.
El aumento del recuento total de hemocitos, así como de hialinos y granulocitos, contribuirá a la mejora de algunas respuestas
inmunitarias celulares y humorales en los camarones contra las bacterias patógenas.
La aplicación de métodos biológicos es eficaz para limitar la resistencia de los patógenos a los medicamentos, y su uso en la prevención de las enfermedades es cada vez más popular. Es bien sabido que el efecto antipatógeno de las LAB se debe a la actividad antagonista de las bacterias lácticas utilizadas contra las cepas de bacterias dañinas a través de mecanis-
células sanguíneas
de los camarones, con
mos competitivos. Los probióticos producen una amplia gama de moléculas bioactivas, que poseen actividad bactericida, como antibióticos, bacteriocinas, sideróforos, enzimas (lisozimas, proteasas) y/o peróxido de hidrógeno, así como ácidos orgánicos. Inhiben las bacterias patógenas en el tracto intestinal del huésped y proporcionan una barrera contra la proliferación de patógenos.
El carbono, el nitrógeno y el fósforo son elementos nutritivos importantes de los organismos vivos con funciones constituyentes del material celular, aminoácidos, ácidos nucleicos nucleótidos, coenzimas nucleótidas, fosfolípidos, lipopolisacáridos y ácidos teicoicos, especialmente las bacterias heterótrofas. El suministro de CNP estimula el crecimiento de bacterias heterótrofas y otros microorganismos en el agua del estanque.
En cambio, las aplicaciones de probióticos a los tratamientos de
en el sistema inmunitario no
cada
de células,
CNP y V. parahaemolyticus en el presente estudio mostraron que todos los L. plantarum, L. fermentum y P. pentosaceus aliviaron los impactos de V. parahaemolyticus en los camarones. Especialmente, el suministro de L. plantarum en el alimento, que tuvo el mejor efecto sobre la resistencia a la AHPND de los camarones en comparación con los otros dos probióticos potenciales.
El suministro de trehalosa, ácido glutámico, KH2 PO4 y K2 HPO4 en el agua experimental provocó un aumento de la mortalidad de los camarones y de la probabilidad de que se produjera un brote de AHPND en el camarón (P. vannamei). Sin embargo, la adición de L. plantarum al alimento redujo significativamente la mortalidad, así como la tasa de infección de AHPND en presencia de CNP. Por lo tanto, L. plantarum puede ser un candidato para reducir la AHPND en la cría intensiva de camarones.
Esta es una versión divulgativa desarrollada por el equipo editorial de Panorama Acuícola Magazine del artículo “Effects of Feed Mixed with Lactic Acid Bacteria and Carbon, Nitrogen, Phosphorus Supplied to theWater on the Growth and Survival Rate of White Leg Shrimp (Penaeusvannamei) Infected with Acute Hepatopancreatic Necrosis Disease Caused by Vibrioparahaemolyticus” escrito por: Linh Nguyen Thi Truc, Tuu Nguyen Thanh, To Tran Thi Hong, Day Pham Van, Minh Vo Thi Tuyet, Nghia Nguyen Trong, Minh Phan Cong, Diep Cao Ngoc y Phu Truong Quoc. La versión original fue publicada a través del journal Biology de MDPI en marzo de 2021 bajo un uso de licencia Creative Commons 4.0.
La versión completa en idioma original se puede encontrar a través de https:// doi.org/10.3390/biology10040280

En el sector acuícola y, en especial en la cría de camarones, la alimentación es un aspecto clave que impacta directamente los niveles de productividad. La selección del producto adecuado para este propósito debe considerar todos los aspectos sanitarios y de bioseguridad, que reduzcan la posibilidad de desarrollo de enfermedades en los crustáceos. Este aspecto forma parte de la lucha diaria de los productores, quienes deben satisfacer la creciente demanda del mercado.

Los poliquetos marinos se han convertido en una excelente alternativa que proporciona proteínas y lípidos altamente digeribles y con un significativo valor nutritivo. Por mucho tiempo se habían descartado como opción, dado el alto costo que implicaba a los productores, pero se han retomado gracias al avance de los poliquetos FrozenOcean en el mercado. De esta forma, con entre el 4 y el 14% de la biomasa de reproductores de camarón, se puede suplir el alimento de un día de los crustáceos.
Proceso de producción y ensayos de bioseguridad Cosechados, entre el Noreste de U.S.A. y el Círculo Polar Ártico, en áreas libres de contaminación y alejadas de camaroneras, FrozenOcean propone un alimento natural basado en un poliqueto para maduración esterilizado (Nereis sp.).
Si bien la estrategia de empacado y congelado a bordo de los poliquetos, es una forma de evitar una posible contaminación, un análisis de detección de enfermedades virales y bacterias comu-
nes en camarones desarrollado en Aquaculture Pathology Laboratory de la Universidad de Arizona, y un posterior proceso de esterilización con rayos gamma; elevan el nivel de bioseguridad en el caso de FrozenOcean. Este último método, también es utilizado para la esterilización de tejidos para trasplante humano, insumos médicos y otras
aplicaciones, donde se requiere garantizar la seguridad e integridad del producto.
Se ha demostrado que los niveles de fertilidad de camarones y peces se ven positivamente influenciados por altos niveles de PUFA y HUFA. Esto,
sumado al alto nivel proteico de los FO, un 15% de lípidos, un nivel de colesterol apropiado y vitaminas E y C; ofrece una alimentación balanceada que considera todos los elementos necesarios para favorecer un buen resultado con un bajo riesgo de transmisión de enfermedades. Sumado a esto, un tamaño apropiado de los poliquetos facilita el proceso de alimentación de los camarones, reduciendo la cantidad de desperdicios en los estanques; lo que se traduce en una disminución del riesgo de enfermedades.
Aunque la cantidad de alimento puede variar dependiendo de aspectos ya conocidos, que también afectan los hábitos del camarón; en el caso del poliqueto FrozenOcean, su alto rendimiento y calidad nutricional lo mantienen como una alternativa rentable para la maduración de reproductores P. Vannamei

El proceso de congelado rápido permite conservar su valor nutricional, garantizando la integridad del producto por hasta 3 años desde su elaboración, siempre que se conserve en condiciones de refrigeración con temperaturas mínimas de -18°C; en caso contrario, no se recomienda su uso pasados 3 días de descongelado.
La posibilidad de utilizar el producto congelado también aporta a la rapidez y simplificación del proceso de suministro de alimento. Este, es empacado de forma separada para el uso de la canti-


dad necesaria, asegurando la protección del resto del producto que no estará en contacto con el ambiente hasta el momento de ser utilizado.
Más información disponible a través del sitio: https://www.megasupply.net/productos/ poliquetos-frozen-ocean/

Manejar el estrés y el comportamiento alimenticio es esencial para tener una buena productividad y para mantener a los animales en un estado óptimo de salud y crecimiento.
El camarón forma parte de las especies más importantes de la acuicultura mundial en términos de volumen y de valor. La industria de camarones marinos, en particular del camarón blanco Litopeneaus vannamei, ha conocido un desarrollo tecnológico exponencial, con diferentes sistemas de producción a nivel mundial (FAO, 2020). Siendo carnívoro, el camarón tiene un alto requerimiento nutricional en proteína, y el alimento puede representar hasta un 60% de los costos de producción (Tantikitti, 2014).
Al mismo tiempo, el cultivo de camarón se compone de varias etapas y transiciones que representan eventos estresantes para los animales, así como una exposición a diversas enfermedades para las cuales se emplean tratamientos y sustancias inapetentes. Sumando a eso, el comportamiento alimenticio del camarón dispone de un sistema sensorial altamente desarrollado y sensible, por lo que vemos que existen muchos factores que pueden impactar el consumo y la rentabilidad de la costosa estrategia alimentaria de esta especie (Derby & Sorensen, 2008). En estas condiciones, asegurar un buen consumo de alimento es esencial para mantener una buena productividad, y optimizar los costos de producción de la camaronicultura.
El estrés también es un factor que tiene un fuerte impacto sobre el consumo y varios otros aspectos de la fisiología del camarón. Al no tener un sistema inmunológico desarrollado como el de los vertebrados (Dugassa 2018), el estrés puede ser una de las principales causas de infección del camarón por patóge-
nos o parásitos. El estrés también provoca un cese temporal de consumo que puede ser fatal para los camarones que no asimilan entonces la energía y los nutrientes esenciales para su supervivencia. Es por lo tanto importante mitigar estas consecuencias del estrés para mantener a los animales en un estado óptimo de salud y crecimiento.
Los Laboratoires Phodé (Albi, Francia), expertos en olfacción funcional, disponen de una vasta experiencia y conocimiento del efecto de moléculas sensoriales y sus combinaciones, para diseñar formulaciones adaptadas a cada especie, que procuren al animal un estado de “MejorEstar”, y le permitan de esta manera expresar su pleno potencial. Es así como Phodé desarrolló una solución específica para camarones, Optifeed Life Shrimp, formulación neurosensorial compuesta de un complejo aromático adaptado al camarón, y de extractos vegetales seleccionados para mantener el apetito en etapas críticas y de estrés. Esta solución ha demostrado sus beneficios producti-
vos a través de varias experimentaciones tanto en camaroneras como en laboratorios de larvas.
Los efectos de esta solución fueron probados en la Universidad de Prince of Songkla en Tailandia.
El objetivo de este estudio fue de medir el efecto de Optifeed Life Shrimp (OLS) sobre el comportamiento y el desempeño del camarón. Durante 8 semanas, 900 camarones blancos del Pacífico (Litopeneaus vannamei) con peso inicial promedio de 0.5g fueron divididos en 18 estanques de 220L, con una densidad de 50 camarones/estanque, en agua salobre con 15 ppt de salinidad (ver Figura 1). Materias fecales fueron sifonadas a diario, y un 60% del agua fue cambiado cada tercer día, previa desinfección (cloro, 20 ppm). El alimento balanceado utilizado tenía un contenido proteico del 35% y un 7% de lípidos. Se incluyó OLS a 3.0 kg/tonelada de alimento, frente a un control negativo sin OLS, sustituido por 3,.0 kg/tonelada de celulosa.

OLS fue aplicado por coating de 125 ml/kg de una solución salina (NaCl al 1,5 % m/v). El alimento fue distribuido a los camarones 4 veces/día.

Para observar el efecto de OLS sobre el consumo, se midieron la velocidad de consumo, el peso vivo, el índice de supervivencia, y la biomasa total al final del experimento (semana 8).
Para evaluar el efecto de OLS sobre el estrés, un protocolo de inducción de estrés agudo fue iniciado en semana 4: durante 5 segundos se removió el agua en los estanques (primer factor de estrés), 12 camarones fueron recogidos y pesados (segundo factor de estrés), e identificados por eye-tagging (tercer factor de estrés). Los efectos de este estrés fueron medidos por dos indicadores: color de las antenas (antenas rojas demuestran el nivel de estrés
de los camarones) y el tiempo de inmovilidad tras el estrés, recordando que animales con un sistema nervioso central primitivo como el camarón blanco suelen permanecer inmóviles después de una situación estresante.
Todos los datos obtenidos se compararon estadísticamente por prueba Khi² o Anova unidireccional.
Efecto de OLS sobre velocidad de consumo y supervivencia total Se pudo observar que OLS mejoró el comportamiento alimenticio, aumentando la velocidad promedia de consumo de alimento en los primeros 30 min después de la distribución ( ver Figura 2).
Los resultados también demostraron una mejora significativa de la supervivencia final con el uso de
OLS pasando de 48,7% a 64,7% de supervivencia al final de las 8 semanas de experimento (ver Figura 3).
Los resultados de ambos parámetros fueron muy interesantes. Los diferentes manejos (dos eventos estresantes: agua removida y camarones removidos y pesados) fueron al origen de un estrés agudo, como se puede observar en el control (ver Figura 4), donde todos los camarones control mostraron antenas rojas. El uso de OLS redujo muy significativamente este nivel de estrés.
En el segundo parámetro la inclusión de OLS redujo el tiempo de inmovilidad de manera significativa, este tiempo pasó de 30 a solamente 5 segundos tras el estrés, mostrando una capacidad mayor de resiliencia (Figura 5).


La consecuencia directa de estas mejoras fue una mayor biomasa total al final del experimento con el uso de OLS a 3.0 kg/tonelada (ver Figura 6). El peso vivo promedia al final de la prueba (todos tratamientos confundidos) era de 11.6 g.
De manera general, se observó que el nivel de supervivencia y la velocidad de consumo aumentaron con OLS, resultando en una biomasa total más importante al final del experimento. Por otro lado, la diferencia de biomasas entre el grupo Control y el grupo OLS, comparada a las diferencias de supervivencia y de consumo, sugiere un resultado de peso individual medio más importante en el grupo Control. Esta observación se puede explicar por el hecho de que une mayor supervivencia implicó una menor cantidad de alimento distribuida por individuo, y entonces un nivel individual de crecimiento menor en general.
También es importante considerar que las densidades de cultivo elegidas en este trabajo corresponden a un estándar tailandés, donde los cultivos son más intensivos, limitando el crecimiento individual, al contrario de países como Ecuador donde OLS ha demostrado en diferentes pruebas una mejora del crecimiento general y una reducción del ciclo de producción. Este resultado muestra que la inclusión de OLS puede adaptarse a las diferentes estrategias de producción en el mundo.
Las mediciones de estrés realizadas inicialmente mostraron el efecto estresante de manipulaciones mecánicas (pesaje, eye-tagging, cambio y agitación de agua). Estos efectos fueron mitigados por el uso de Optifeed Life Shrimp que permitió una mejor reacción y una adaptación más rápida al estrés.
Si bien el efecto de OLS sobre estrés y consumo fue demostrado en este experimento, así como en trabajos previos, la cuestión de su modo de acción cerebral, como solución neurosensorial, permanece. Los camarones de la familia de Decápodos tienen un sistema olfativo y gustativo muy desarrollado permitiendo la detección de pequeños compuestos en un ambiente complejo con un umbral de percepción muy bajo (Derby & Sorensen 2008, Derby 2020). El olfato está involucrado en comportamientos esenciales como orientación hacia un olor distante a comida, selección de refugio en respuesta a señales químicos conspecíficos y determinación del estatus social conspecífico (Horner, 2007). Este sistema sensorial complejo se compone de varios quimiorreceptores con funciones diferentes, desde la atracción hacia el alimento, su detección, hasta la evaluación de su palatabilidad.

Con su mezcla compleja de diferentes moléculas neurosensoriales, OLS tiene un efecto sobre los diferentes quimiorreceptores del camarón lo cual resulta en un mensaje cerebral supresor del estrés y estimulador del apetito. Este modo de acción se podría verificar en experimentos enfocados en observaciones comportamentales, o en fases de estrés agudo más críticas.
La incorporación de Optifeed Life Shrimp en dietas de camarón ha permitido mejorar su respuesta al estrés
Figura 4. Proporción de camarones estresados (antenas rojas) en semana 4. ***Diferencias muy significativas por prueba khi2 (P<0.0001).
Figura 5. Tiempo de inmovilidad promedio tras un estrés agudo en semana 4, *p<0,05.
Figura 6. Biomasa total al final del experimento, *p<0,05.
y su comportamiento alimenticio en general. Este ensayo demuestra que Optifeed Life Shrimp ayuda a enfrentar los diferentes efectos adversos ocurriendo durante el ciclo de producción, como manejos, transiciones alimenticias, o cambios ambientales entre otros; mejorando el consumo, el nivel de supervivencia, y consecuentemente la biomasa total.
Estos resultados sugieren el uso de Optifeed Life Shrimp una solución neurosensorial eficiente para mantener un alto nivel de productividad.


Referencias utilizadas por los autores en la elaboración del artículo disponibles bajo previa solicitud.
Más información: https://www.phode. com/es/animal-care/

La camaronicultura permanece altamente dependiente de la disponibilidad de alimentos frescos y vivos como pilares de los programas de alimentación de reproductores. Esta dependencia ha costado a la industria miles de millones de dólares debido al muy bien documentado rol de estos alimentos en la transmisión de enfermedades tales como WSSV, AHPND y EHP. Alcanzar el 100% de reemplazo de alimentos frescos y vivos requiere de un esfuerzo sostenido de la industria, para asegurar que los programas de reproductores en todos lados converjan con la creciente demanda de nauplios de alta calidad.

La industria de los reproductores de camarón está avanzando rápidamente, trayendo nuevos potenciales para crecimiento, resistencia a enfermedades y otras mejoras genéticas. Los adelantos en nuestro conocimiento sobre los requerimientos nutricionales y fisiológicos del proceso de maduración nos han llevado a mejoras en los programas de alimentación para maduraciones. Dietas preparadas diseñadas específicamente para las diferentes necesidades fisiológicas de cada etapa del desarrollo de los reproductores están disponibles hoy en día. Cuando el uso de estas dietas se acompaña de programas de alimentación personalizados, los productores pueden llevar a cabo ganancias significativas en la calidad y consistencia del nauplio, al mismo tiempo que se mejora la bioseguridad.
A pesar de estos avances, la industria permanece altamente ligada a depender de alimentos frescos y vivos como pilares de los programas de alimentación de reproductores. Esta dependencia ha costado a la industria miles de millones de dólares debido al muy bien documentado rol de estos alimentos en la transmisión de enfermedades tales como WSSV, AHPND y EHP. Ahora
de camarón.
La industria de los reproductores de camarón está avanzando rápidamente, trayendo nuevos potenciales para crecimiento, resistencia a enfermedades y otras mejoras genéticas.
Un programa nutricional para reproductores bien diseñado asegura que niveles precisos de nutrientes y energía sean entregados a los animales a través del proceso de maduración para producir consistentemente nauplios saludables de alta calidad.
y vitaminas en los niveles requeridos por cada etapa de desarrollo. Las dietas avanzadas de reproductores contienen aditivos para asegurar un balance inmune sólido y buena salud intestinal. Las dietas fabricadas ofrecen las más seguras y confiables opciones para proveer del balance apropiado de nutrientes y aditivos de salud.
más que nunca, las brechas críticas en la nutrición y la bioseguridad de los programas de maduración deben ser priorizadas, evolucionando los programas de alimentación para reproductores para maximizar las ganancias potenciales de los avances genéticos. Alcanzar el 100% de reemplazo de alimentos frescos y vivos requiere de un esfuerzo sostenido de la industria, para asegurar que los programas de reproductores en todos lados converjan con la creciente demanda de nauplios de alta calidad.
Basados en una investigación diligente y sobre dos décadas y media de experiencia produciendo dietas para reproductores de camarones, y basados también en la experiencia mundial de 85 años de historia en la fabricación de alimentos desarrollamos este artículo para compartir perspectivas sobre este tema en especial.
Los procesos fisiológicos asociados con la maduración son complejos y dinámicos. Los requerimientos nutricionales del camarón cambian
conforme el camarón avanza a través del proceso de maduración. Un programa nutricional para reproductores bien diseñado asegura que niveles precisos de nutrientes y energía sean entregados a los animales a través del proceso de maduración para producir consistentemente nauplios saludables de alta calidad. Las dietas personalizadas para reproductores deberán ser introducidas en la alimentación de los animales desde edades tempranas para maximizar su potencial y poner al productor en control. Conforme el camarón se acerca a su madurez sexual, se debe introducir una dieta escalonada más densa en nutrientes mejorando el desarrollo y acondicionamiento gonadal. A medida que los camarones inician la reproducción activa, una dieta especial de maduración debe ser proporcionada para apoyar los desoves repetitivos de huevos saludables en las hembras y esperma en los machos.

Las dietas apropiadamente formuladas y los buenos protocolos de alimentación aseguran que los animales tengan una entrega consistente de nutrientes tales como fosfolípidos, HUFAs, carotenoides, aminoácidos
Una amplia variedad de alimentos vivos y frescos se usan comúnmente en los programas de alimentación en la maduración, incluidos calamares, poliquetos, mejillones, ostras, almejas, biomasa de artemia adulta y krill. El perfil nutricional y sobre todo la calidad de estos alimentos varían de acuerdo a su origen, estacionalidad y cambios en las condiciones ambientales. Además, prácticamente todas las instalaciones de maduración usan diferentes combinaciones y porcentajes de alimentos vivos y frescos, resultando en amplias variaciones nutricionales entre laboratorios
En Asia, los poliquetos vivos son comúnmente usados porque dan apoyo a niveles muy altos de producción de nauplios. Esta dependencia en los poliquetos vivos silvestres para mejorar la fecundidad es el mayor contribuyente a la introducción y diseminación de enfermedades tales como WSSV, AHPND y EHP. Y, aunque congelar los gusanos puede reducir el poder infeccioso de algunos patógenos, la productividad de nauplios se puede afectar y muchos productores no están dispuestos a sacrificar una producción más alta de nauplios en aras de una mejora en la bioseguridad.
Los poliquetos cultivados congelados son una alternativa segura a los poliquetos vivos. De igual manera, calamares congelados procedentes de áreas aisladas geográficamente de regiones productoras de camarón también reducen el riesgo de introducción de patógenos al laboratorio. Sin embargo, los alimentos frescos congelados se componen de un 80-90% de agua, por lo que el transporte aéreo incluye una significativa inversión por unidad de peso seco nutricional.
El manejo de inventarios de alimentos frescos o vivos presenta sus propios retos. Los alimentos frescos congelados de alta calidad son típicamente importados usando una cadena de frio que añade costos y riesgos para mantener su vida de anaquel. Alternativamente, las dietas elaboradas ofrecen una vida de anaquel más prolongada, facilitando el manejo de inventarios y asegurando enormemente la consistencia de un programa de maduración.

Para minimizar el riesgo de introducción de una enfermedad por parte de animales criados en granjas, el uso de reproductores libres de enfermedades específicas (SPF) se ha venido convirtiendo rápidamente en un estándar en la industria. Los gobiernos también están regulando estrictamente los procesos de importación. Todo esto viene a representar un costo significativo para los productores. Irónicamente, una vez que llegan al laboratorio, el estatus de los organismos libres de enfermedad que el gerente pagó por obtener se ve frecuentemente comprometido por la alimentación con productos vivos, frescos o congelados para maximizar su producción de nauplios. Si bien esto podría incrementar en el corto plazo las ganancias para el dueño del laboratorio, las pérdidas económicas para los operadores de las granjas y para la industria alcanzan miles de millones de dólares cada año.
Una transición necesaria
Los argumentos para incrementar el uso de dietas elaboradas son abrumadores pero la resistencia al cambio es bastante significativa. Tal como Albert Tacón, un reconocido líder en el tema de nutrición en acuicultura lo ha declarado: “en vista de los riesgos potenciales de enfermedades por el uso de alimentos naturales frescos y vivos contaminados con patógenos, sería prudente que la industria del camarón sacrificara menos el rendimiento del criadero y la contaminación de sus valiosos reproductores libres de patógenos específicos al pasar por completo al uso de alimentos para larvas y maduración bioseguros fabricados comercialmente” (Journal of the World Aquaculture Society Volume 48: 381-392).
Un programa de alimentación de maduración bien diseñado utiliza
alimentos bioseguros en cantidades ajustadas para los niveles de consumo de sus reproductores. Para ser efectivos, las dietas preparadas deben ser consumidas en las cantidades necesarias para proveer el impacto nutricional deseado. Debido a que los diferentes alimentos varían con respecto al contenido de humedad y los nutrientes disponibles están enormemente asociados con la materia seca, las tasas de alimentación deberían de estar basados
en el porcentaje de la materia seca en los alimentos. El reemplazo total de todos los alimentos congelados diferentes al calamar ha sido exitosamente alcanzado usando alimentos formulados de alta calidad para reemplazar los alimentos frescos sobre una base de peso seco equivalente.
Cuando las dietas fabricadas son introducidas, un enfoque muy conservador puede impedir los progresos. Tradicionalmente, las dietas
elaboradas son alimentadas de entre un 1% a un 1.5% de la biomasa del tanque. Sin embargo, la alimentación con estas dietas de alta calidad, a tales niveles bajos, reduce su impacto nutricional. Para mejores resultados, una dieta muy atractiva y avanzada debiera ser alimentada a tasas >2.5% de peso seco a la biomasa del tanque. Las dietas elaboradas debieran ser más que el 50% del total del peso seco alimentado. El uso de animales viejos que han sido
El programa de maduración de reproductores 1-2-3 exclusivo de Zeigler (Broodstock 1-2-3 Maturation Program) abarca una gama de dietas especialmente adaptadas para cada fase de un programa de reproductores.
Una vez que los animales se han aislado para futura reproducción, el acondicionamiento puede ser iniciado para prepararlos para unos resultados a largo plazo. Un alimento a la medida como el Shrimp Broodstock de Zeigler puede ser introducido a los animales desde los 7 gramos y es adecuado para ser usado en sistemas abiertos.

Cuando los animales inician la fase de desarrollo fisiológico gonadal más demandante, la necesidad de más nutrientes densos se agudiza. El alimento de Zeigler Shrimp Maturation Conditioning Diet está formulado con micronutrientes que ayudan a optimizar las reservas gonadales, acelerar las tasas de copulas e incrementar los tamaños de los desoves. Esta dieta está especialmente diseñada para su uso en sistemas de tanques controlados.
Cuando los reproductores alcanzan la fase de desove activa el abasto consistente de una nutrición optimizada alcanza nuevos niveles de importancia a medida que aumentan las demandas metabólicas de los reproductores. Zeigler ofrece dos dietas exclusivas para esta etapa, EZ Mate y Redi-Mate, ambas contienen niveles extremadamente altos de carotenoides y vitaminas para promover y sostener buenas tasas de desoves e incrementar el número y la calidad de nauplios por desove. Ambas dietas han sido cuidadosamente desarrolladas para maximizar la atractabilidad y asegurar la absorción de una nutrición vital para sustentar una producción optimizada.
EZ Mate es una dieta altamente adaptable en forma de polvo que el cliente puede hacer una masa que le permite la personalización del alimento mediante la adición de otros ingredientes y moldear la dieta en el formato preferido.
Redi-Mate es la más nueva dieta para reproductores de Zeigler, abarca la ciencia nutricional y las tecnologías de fabricación más recientes, lo que da como resultado un pelet semi húmedo muy atractivo, que está listo para ser proporcionado a los animales.
acostumbrados a alimentos frescos para probar nuevas dietas también puede ser problemático. Los animales más jóvenes acondicionados en dietas preparadas desde su siembra proveen mejores resultados.
En resumen, las tecnologías para dietas elaboradas de maduración están mejorando. Mejores ingredientes de composición nutricional optimizada, atractabilidad mejorada, aditivos efectivos y procesos de manufactura innovadores están
contribuyendo sinérgicamente para mejorar los desempeños. Cuando estos alimentos son apropiadamente incorporados en un programa de maduración completo, proveen una base para reducir el uso de alimentos vivos y frescos, permitiendo una producción de nauplios sólida y más biosegura.
*Más información en: https://www.zeiglerfeed.com/
Los brotes bacterianos, como la Vibrios, representan una problemática frecuente ante la realidad del camaronero ecuatoriano. En este contexto, Nicovita amplía su portafolio con su nuevo producto en la línea de salud, el nuevo Nicovita TÉRAP E+ que busca una mayor productividad de cosecha comprobada frente a escenarios adversos.
Vitapro y su marca Nicovita conocen el nivel de impacto que tienen las enfermedades en la etapa de engorde de los cultivos de camarones. Ante la complejidad de esta problemática, guiados por el compromiso de desarrollar soluciones nutricionales ajustadas a la realidad actual de los productores camaroneros, desarrolló un nuevo producto para enfrentar a los brotes bacterianos causados por la vibriosis, que representa una gran amenaza para la sobrevivencia y eficiencia de los cultivos.
Se trata del nuevo Nicovita TÉRAP E+, una dieta terapéutica viva, diseñada especialmente para
tratar enfermedades bacterianas a causa de la Vibrio, con el mejor costo-eficiencia y en consideración de las necesidades de la industria en esta fase del cultivo. Para lograr resultados efectivos, este producto se ha desarrollado con las cepas más desafiantes de los principales campos del Ecuador; logrando exitosamente su principal objetivo que es maximizar la sobrevivencia y mantener el ritmo del crecimiento del cultivo.


Nicovita, líder en soluciones nutricionales y servicios para el cultivo de camarón en Latinoamérica, ha desarrollado esta dieta terapéutica que adicional a una base nutricional que asegura el consumo en esta etapa de alto desafío
para el camarón, contiene un mix antibacteriano de ácidos orgánicos y aceites esenciales exclusivo; usando tecnología intrapellet para asegurar el consumo óptimo del camarón y lograr mayor costo eficiencia en la producción. Esta dieta ha sido diseñada específicamente para la fase de engorde, entendiendo las particularidades del efecto bacteriano en dicha fase. Nicovita TÉRAP E+, es un producto que contribuye a combatir efectivamente las infecciones bacterianas en 10 días, para asegurar la mayor cantidad de camarones vivos y sanos al término de la cosecha, lo cual impacta positivamente en el negocio del productor.
Beneficios de la Tecnología Intrapellet del Nicovita TÉRAP E+
• Asegura la dosis óptima de ácidos orgánicos y aceites esenciales que actúan en sinergia para combatir y limitar los brotes bacterianos del género Vibrio de forma efectiva.

• Altamente palatable que garantiza el consumo del alimento, al ser de grato sabor al paladar del animal.
• No existe livixiación del antibacteriano, es decir, el producto no se disuelve en el agua y la dosis es consumida en su totalidad.
• Uso eficiente de recursos, dado que, este producto viene listo para abrir del saco y alimentar, así se genera un ahorro en compra de ácidos orgánicos y en la optimización de la mano de obra en campo.
Nicovita Terap E+ ha sido desarrollado en la red de Centros
Experimentales Acuícolas de Vitapro (CEA), recientemente ampliada gracias al convenio establecido con el Centro de Investigación en Alimentación y Desarrollo (CIAD), prestigiosa institución aliada de Nicovita desde hace más de 6 años, donde se ha consolidado la colaboración a la investigación y la ciencia inaugurando un módulo de pruebas de desafío exclusivamente dedicado al desarrollo de soluciones nutricionales para la salud de la industria. Dándole así, una mayor velocidad de respuesta y resultados contundentes frente a dichas problemáticas que enfrentan día a día los camaroneros. La investigación local enfoca las mejores soluciones sustentada en la realidad y necesidad del cultivo que se va evaluando constantemente y que garantiza una eficiencia del resultado en el tiempo.
La investigación se complementa con los servicios de asesoría especializados de Nicovita, basados en un conocimiento profundo del entorno local. Además, se conjugan con la aplicación de tecnologías en campo como la alimentación automática y permiten ayudar al productor camaronero para hacer más eficientes los procesos y operaciones de su negocio. Todas estas variables, sumadas a la transferencia constante de conocimiento, derivan en programas integrales que agregan valor a los procesos de producción de camarón.
Vitapro tiene como propósito transformar la acuicultura para nutrir el mañana, y se dedica, a través de su marca Nicovita, hace más de 35 años, al desarrollo de soluciones nutricionales sustentables para la acuicultura en Ecuador y otros países.
Más información: https://nicovita.com/









































































































Este estudio desarrollado por investigadores de la Universidad Autónoma Metropolitana y la Universidad Nacional Autónoma de México fue estimar los efectos de Interacción de genotipo por ambiente (IGA) para peso corporal (PC) y supervivencia a cosecha (SC) en dos ambientes comerciales (presencia o ausencia de brote natural del Síndrome de la Mancha Blanca), en dos líneas genéticas de camarón blanco del Pacífico (Penaeusvannamei); una seleccionada para crecimiento y otra con antecedentes de resistencia a la enfermedad.
La producción mundial de camarón blanco del Pacífico (Penaeus vannamei) se ha basado en la producción de líneas genéticas que han sido seleccionadas para crecimiento y supervivencia general. Al mismo tiempo, las unidades de producción han sido afectadas por varias enfermedades con altas tasas de morbilidad y mortalidad; entre ellas, el Síndrome de Mancha Blanca (SMB).
El control de SMB ha sido una meta difícil y se ha optado por añadir criterios de selección relacionados a la resistencia de esta enfermedad, al objetivo de selección de Programas de Mejoramiento Genético (PMG) en peneidos. En este sentido, es importante tener estimadores adecuados de heredabilidad (h2) y correlación genética (rG) para la formulación de estrategias de selección. Estos parámetros genéticos, estimados en condiciones de brote natural, pueden brindar información importante para ser considerada en los PMG.

La estimación de estos parámetros para la misma característica en ambientes diferentes puede interpretarse como una interacción de genotipo por ambiente (IGA). Dicha IGA, puede modificar la estimación de h2 y rG entre criterios de selección, provocando respuestas poco precisas y alteraciones en el ordenamiento de los candidatos a reproductores.
No hay información sobre cómo se modifican estas rG para peso y supervivencia a través de diferentes ambientes en la producción de camarón. Es por ello que, es importante estimar estos parámetros genéticos (h2 y rG) en presencia o ausencia del SMB para el diseño óptimo de los PMG.
En tal sentido, el objetivo de este estudio fue estimar los efectos de IGA para PC y SC en dos ambientes comerciales (presencia o ausencia de brote natural del SMB), en dos líneas genéticas de camarón blanco del Pacífico (Penaeus vannamei); una seleccionada para crecimiento y otra con antecedentes de resistencia al SMB.
Los datos fueron obtenidos de una compañía de producción de larvas de camarón, localizada en el noroeste de México. Los registros incluyeron camarones del ciclo de producción 2016. Los camarones fueron criados bajo condiciones comerciales en tres estanques. Dos estanques presentaron un brote natural de SMB (SMB-presencia), donde el diagnóstico se realizó a partir de la sintomatología y cambios macroscópicos típicos del SMB durante el ciclo de producción y confirmado mediante análisis de PCR. En el tercer estanque, se realizaron procedimientos estrictos de bioseguridad y no se detectaron síntomas de SMB, ni hubo diagnóstico positivo por PCR (SMBausencia).
Se utilizó una línea seleccionada desde 1998 para crecimiento y SC
(CRE), y otra línea con antecedentes de resistencia a SMB (RES). Las familias fueron producidas mediante inseminación artificial, utilizando una relación de un macho por cada dos hembras para la formación de familias de medios hermanos. La alimentación en las fases larvarias se basó en micro-pellets comerciales con 40% a 50% de proteína y 8% a 10% de grasa, microalgas Chaetoceros, Spirulina spp, y Artemia spp., y la constitución de la dieta se adecuó a cada estadio.
Posterior a 70 días de la siembra se recuperó la totalidad de los organismos de los estanques, y de cada uno se identificó la familia de origen, el sexo y peso corporal. Se eliminó la información de individuos con deformidades, sin identificación confiable o sexo indefinido. Para la estimación de la SC se consideró a los animales recuperados al final del periodo como vivos (1) y los animales no recuperados, considerando la diferencia como muertos (0).

Los parámetros genéticos para PC y SC fueron estimados para cada línea, usando un modelo animal y máxima verosimilitud restringida, con el software ASReml. Considerando los criterios de aproximación de una distribución binomial a una distribución normal se asumió normalidad en el análisis de SC.
En la estimación de los parámetros genéticos para el PC, los efectos fijos incluidos en el modelo fueron: sexo, edad a la cosecha lineal y cuadrática. Adicionalmente, en el caso de SMB-presencia, se incluyó el efecto de estanque (Kino y Marea alta). En cuanto a la SC para los estanques afectados, el único efecto fijo considerado fue el de estanque en SMB-presencia; mientras que en el ambiente SMBausencia no se consideró ningún efecto fijo.
La varianza fenotípica para cada característica se estimó como la suma de los componentes de varianza de los efectos aleatorios (genético del animal y común de familia). La h2 se estimó como la proporción de la varianza fenotípica que se debe a la varianza genética aditiva, y la rG se estimó como la covarianza dividida en el producto de las correspondientes desviaciones estándar. Finalmente, para analizar si el comportamiento de las características entre líneas genéticas fue similar, se realizó una comparación de las rG estimadas en cada línea
Los resultados muestran diferencias en SC, donde la línea CRE tiene una baja SC en SMB-presencia; mientras que los camarones de la línea RES poseen una menor SC en SMB-
presencia. Adicionalmente, existe interacción línea por ambiente en las dos características. Dichas interacciones de línea por ambiente resaltan la importancia de considerar la probabilidad de ocurrencia de la enfermedad SMB, cuando se elige la línea en el programa de mejoramiento genético.

Las heredabilidades en SMBausencia fueron consistentes con los presentados por autores como Tan et al. (2017), Trang et al. (2019) y Ren et al. (2020). Por otro lado, las heredabilidades para SMB-presencia son similares a los estimados por Caballero-Zamora et al. (2015), quienes también usaron datos provenientes de un brote natural de SMB.


El efecto de plasticidad fenotípica debería ser considerado en los programas de mejoramiento genético de camarón, procurando que los ambientes de desempeño a analizar sean lo más parecidos a las condiciones de producción.
La diferencia entre las heredabilidades para SMB-presencia y SMBausencia, puede ser un indicador de heterogeneidad de varianzas; pero en este caso, además de cambios en la varianza genética aditiva, la fuente de esta heterocedasticidad puede estar contenida en cambios en la varianza ambiental por la sensibilidad micro ambiental de los individuos. En el caso de SMBpresencia, es importante mencionar que la poca precisión en el estimado de h2 puede deberse a la estructura de datos resultante de la alta mortalidad.
Las variaciones en los estimadores de heredabilidad para PC pueden ser resultado de la sensibilidad micro ambiental de los individuos. Dado lo anterior, es importante tener en cuenta que estos cambios en la heredabilidad pueden alterar la precisión de la predicción de la respuesta a la selección.
La rG estimada para los PC entre ambientes en la línea CRE fue negativa y no significativa, aunque en las estimaciones con modelos preliminares fue consistentemente negativa. El valor poco preciso de la estimación puede ser consecuencia de los bajos valores de la varianza genética aditiva de PC en SMS-presencia, lo cual complica la evaluación de efectos de IGA en esta línea; mientras que en la línea RES, esta correlación no fue diferente de 1; señalando que los efectos genéticos aditivos para PC son muy similares en los dos ambientes. En otras palabras, no existe efecto de IGA en RES para PC. Considerando que ambas líneas estuvieron en las mismas condiciones ambientales de manejo y expuestas al mismo patógeno (SMB), es posible asumir que las diferencias en los estimadores de ambas líneas son resultado de la baja tasa de SC de la línea CRE.
Heredabilidades para supervivencia a la cosecha en ambas líneas genéticas
Las heredabilidades en CRE fueron esencialmente cero en ambos ambientes, lo cual representa mínimas posibilidades de avance genético por selección para esta característica en ambos escenarios. El avance mínimo por selección
podría estar relacionado con la dificultad en la estimación a causa de la tasa de mortalidad por parte de los modelos estadísticos, una proporción genética muy baja en la expresión de la supervivencia, o posiblemente, el daño en la estructura de relaciones genéticas de familia cuando SMB estuvo presente.
Las heredabilidades estimadas para SC en RES para SMB-presencia y SMB-ausencia, no fueron diferentes estadísticamente a las estimadas para la línea CRE. Las heredabilidades de SC para ambos ambientes fueron consistentes en ambas líneas, sugiriendo que no existe una compresión de la varianza aditiva, en las líneas, asociada al ambiente.
Correlaciones genéticas entre peso corporal y supervivencia a la cosecha
Las correlaciones genéticas por ambiente entre PC y SC se estimaron considerando el efecto común de familia independiente entre ambientes. La correlación genética entre las dos características no pudo ser estimada en SMB-presencia en la línea CRE, posiblemente por la afectación en la estructura de la información asociada con la alta mortalidad presentada en esa línea. Las diferencias entre la correlación genética en RES pueden ser indicador de cambios en los componentes de varianza posiblemente asociados a IGA, a su vez relacionada con las covarianzas correspondientes, lo que tendría implicaciones en la respuesta a la selección correlacionada.
Los resultados de este estudio sugieren que los índices de selección para PC deben tener en cuenta la línea genética usada en el programa de mejoramiento. Por otro lado, la estimación de los parámetros genéticos relacionada a PC debe considerar la presencia de enfermedades endémicas, como es el caso de SMB en el cultivo de camarón y visualizar la SC en presencia y ausencia de SMB como características independientes, en ambas líneas genéticas.
Además de los cambios en las heredabilidades y correlaciones genéticas en ambas líneas, la productividad en éstas fue diferente en
los ambientes estudiados, lo cual, podría interpretarse como un indicador de plasticidad fenotípica, que puede ser común en organismos marinos y puede entenderse como la expresión de diferentes fenotipos en individuos con el mismo genotipo, pero bajo diferentes condiciones ambientales. En consecuencia, dicho efecto de plasticidad fenotípica debería ser considerado en los programas de mejoramiento genético de camarón, procurando que los ambientes de desempeño a analizar sean lo más parecidos a las condiciones de producción.
*Esta es una versión divulgativa desarrollada por el equipo editorial de Panorama Acuícola Magazine del artículo: “Interacción genotipo por ambiente en camarón blanco asociada a Síndrome de Mancha Blanca” autoría de CalaMoreno Nelson, Campos-Montes Gabriel, Caballero-Zamora, Alejandra, BerruecosVillalobos José y Castillo-Juárez Héctor que fue originalmente publicado a través de la revista Abanico Veterinario en Dialnet en su volumen 11 de enero – diciembre, 2021 en las páginas 1 a 16. La versión original se puede consultar en línea a través de este enlace: http:// dx.doi.org/10.21929/abavet2021.13
Autor para la correspondencia: Nelson Cala Moreno: necamo1980@gmail.com

La acuicultura ha ganado una muy mala imagen social a lo largo de su relativamente corta etapa de expansión, tanto a escala global como regional. No ha sido sin razón que múltiples sectores de la sociedad, quizás algunos más sesgados que otros, han denunciado públicamente impactos ambientales de naturaleza diversa, derivados de prácticas acuícolas poco responsables con el entorno y con las comunidades que comparten el uso de los ecosistemas donde se practica el cultivo de organismos acuáticos. Sin que esto sea privativo de una escala en particular, por supuesto las presiones sociales se centran, quizás con razón por la magnitud del impacto, en la acuicultura industrial.
No es fácil borrar de la memoria colectiva -ni debe hacerse- la pérdida del 20% de los manglares en algún país de las Américas para la instalación y expansión de la camaronicultura; ni la casi extinción de algunas especies endémicas en otros países por la siembra sin previo análisis de riesgos de especies exóticas de alta agresividad ecológica.
Es muy alentador ver, sin embargo, que la mayoría de los marcos legislativos tanto ambientales como de la acuicultura en países de América Latina, han incorporado una serie de medidas restrictivas bien fundamentadas, para impedir que dichas atrocidades vuelvan a ocurrir. Más aún, sin negar que aún estamos lejos de alcanzar la convicción de todos los actores de la producción de implementar prácticas más sostenibles, la tendencia es evidente, existe un creciente número de empresas y unidades de producción acuícola, que han mejorado sus diseños, manejo y bioseguridad, coadyuvando a que, con mayor superficie abierta al cultivo, se registren menos incidentes ambientales.
Pero una dimensión muy poco visible de la acuicultura, es la de su rol como herramienta bio-productiva para contribuir a la reproducción masiva y con ello restauración de
poblaciones de especies amenazadas o en peligro de extinción; o la acuicultura que es pilar de programas de repoblamiento de especies que sostienen pesquerías acuiculturales y coadyuvan a su sostenibilidad que, de otra forma, estarían destinadas en la mayoría de los casos a la sobreexplotación.
Existen múltiples ejemplos y evidencias, algunos cercanos que vale la pena destacar; tales como el importante programa de reproducción de la totoaba en el Golfo de California, en el que participan instituciones del sector privado y del Gobierno de México. Sus resultados generan esperanza no solo para esta especie, sino, concomitantemente, para la muy deseada recuperación de la vaquita marina, lo que es una excelente noticia. También en México es importante mencionar el programa de investigación en Michoacán que ha permitido, al menos inicialmente, reforzar la esperanza de la recuperación del pescado blanco.
Las pesquerías acuiculturales con tilapia de México y Cuba; con especies Amazónicas en Brasil y Paraguay; así como la pesquería deportiva del pejerrey en múltiples embalses de Argentina, dependen totalmente de la producción de alevines y juveniles en sistemas controlados de producción y liberados
regularmente. De igual forma, la acuicultura ha permitido que diversas especies que han sido puestas en niveles biológicamente no sostenibles, se recuperen al alcanzarse los niveles de producción masiva, que sustituyen gradualmente la explotación de existencias silvestres; tal es el caso del paiche, el surubí, el tambaquí y el pacú, en la cuenca Amazónica. El resultado es un alivio en la presión sobre la biodiversidad.
Otra dimensión poco reconocida de la acuicultura, es su contribución a la investigación científica en áreas diversas de la farmacognosia. Un ejemplo es sin duda el programa de investigación en neurología que se ha desarrollado por muchos años, teniendo como base el cultivo de pulpo (tanto Octopus vulgaris como O. maya ) en el Instituto Biomédico Marino de la Universidad de Texas, o los subproductos derivados del salmón como aceite, como fuente de ácidos grasos poli-insaturados del tipo Omega3, que hoy son ampliamente distribuidos a escala global como suplemento alimenticio. Vale la pena hacer un esfuerzo por ver también este lado de la moneda.
*
| www.fao.org





La llamada a trabajar todos en equipo para el bien del sector resultan una bocanada de aire fresco para esta actividad que, sin duda, tiene la mayor capacidad de crecimiento de todas las formas de producción primaria y además es la forma más sustentable de producir proteína en el mundo.

Recientemente recibí una llamada telefónica del nuevo Comisionado de Acuaculutra y Pesca de México, Octavio Almada. Fue una gran sorpresa porque a pesar de cola-
borar directamente o indirectamente con los anteriores Comisionados siempre se sentía una gran distancia entre ellos y las personas que llevamos muchos años en esta actividad. La sencillez y sobretodo la llamada
a trabajar todos en equipo para el bien del sector resultan una bocanada de aire fresco para esta actividad que, sin duda, tiene la mayor capacidad de crecimiento de todas las formas de producción primaria y
además es la forma más sustentable de producir proteína en el mundo.
Tal vez lo mejor que le pueda pasar a la acuicultura es que alguien que no proviene del sector pesquero y tiene ideas preconcebidas analice a la acuicultura por su justa dimensión. Tal vez un análisis frío e imparcial permita que se valore a la actividad y se luche por convertirla en una prioridad de la política pública alimentaria del país. Tal vez esta visión crea y apoye a la ciencia, fomente el desarrollo de capacidades, genere las condiciones para que la CONAPESCA trabaje en equipo con el INAPESCA y estas a su vez con las diferentes asociaciones que apoyan a la acuicultura a lo largo y ancho del país; como es la recién creada Sociedad Mexicana de Acuacultura. Una visión fresca que busque fomentar a la acuicultura sin confrontarla con la pesca, que no trate de transformar a los pescadores en acuicultores, sino encontrar a quién de verdad tenga vocación acuícola para desarrollar los proyectos.

Alguien que no proviene del sector puede darse cuenta de que un proyecto estratégico acuícola o un macro proyecto no tiene que ser exclusivo de grandes inversionistas, sino que puede incluir a todos los niveles de inversión. Que hay grandes áreas que aún no se han explotado en México con gran potencial, como la acuicultura no alimentada que incluye el cultivo de bivalvos y macroalgas, actividades que por su naturaleza requieren poco capital de trabajo y pueden detonar a muchas zonas marginadas de nuestro país. Alguien sin vicios puede lograr que se trabaje a los tres niveles de gobierno, ya que tanto la federación, los gobiernos estatales y los municipios tienen que involucrarse en detonar a la acuicultura.
Desde una mirada fresca puede entenderse que una ley sin reglamento perjudica más de lo que beneficia al país, y tal vez, ¿por qué no?, promover una ley para la transición del sector pesquero al sector acuícola en México. A nuestra generación le ha tocado la responsabilidad de administrar esta transición, es momento de que afrontemos dicho reto. Y no, el sector no quiere que regresen los apoyos a fondo perdido, pero sí que empiece la época del crédito con tasas preferenciales para las actividades de
producción primaria que detonen a la actividad más noble y eficiente que es la acuicultura.
El verdadero líder que necesita este sector no es alguien de discursos y promesas, sino un hombre humilde y accesible que gestione a nivel parlamentario los cambios necesarios para impulsar a la actividad, que fomente la inversión y que se rodee de gente profesional que lo apoye. Una persona ajena al sector que no tiene intereses en el mismo podrá tomar las decisiones necesarias, algunas de ellas difíciles, para dar ese gran paso en beneficio de la acuicultura. Ojalá y hoy haya llegado ese líder, a quien le guste trabajar en equipo y sobretodo pensar no en las siguientes elecciones, sino en las generaciones del mañana; la acuicultura y el país se lo merecen.
Antonio Garza cuenta con Maestría y Doctorado en Acuicultura por la Universidad de Auburn, EE.UU.
Rector, Universidad Tecnológica del Mar de Tamaulipas Bicentenario (UTMarT) Presidente-Electo, Sociedad Mundial de Acuacultura (WAS)
Experto acuícola, consultor de la FAO, así como especialista en planeación estratégica. Ex-director de Extensión y Entrenamiento Internacional de la Universidad de Auburn y creador de la Certificación para Profesionales en Acuicultura. Fundador de la Iniciativa Global para la Vida y el Liderazgo a través de los Productos Pesqueros. Recientemente fungió como Director General de Planeación, Programación y Evaluación de la CONAPESCA, en México. Su trabajo lo ha llevado a participar en el desarrollo de proyectos alrededor del mundo.
Tradicionalmente se ha considerado que la función fundamental de una organización de productores es interactuar con el gobierno, si bien esto es algo importante, no es lo único que las organizaciones pueden gestionar para sus agremiados.

Conforme los recursos presupuestales para los programas gubernamentales de apoyo a la acuicultura empiezan a reducirse, pareciera que asimismo la gestión y energía de muchas organizaciones disminuye y en algunos casos hasta desaparece. Esta situación nace de la percepción de muchos productores de que la única razón de existir de las organizaciones es gestionar los apoyos del gobierno, y al desaparecer estos, consideran que, de igual manera, desaparece el objeto de las mismas.

Sin embargo, esta es una visión muy parcial de los alcances que puede tener una organización para gestionar beneficios para sus asociados. Cuando existe unidad, un objetivo común y la madurez institucional necesaria, se pueden llevar a cabo acciones y programas que se financian inicialmente con aportaciones moderadas de los agremiados y que posteriormente pueden llegar no solo a ser autosuficientes, sino a generar ingresos adicionales. Algunos de los beneficios que se pueden alcanzar son:
Economías de escala y reducción de costos. La consolidación de las necesidades de los asociados, que normalmente son iguales o muy parecidas, permite integrar volúmenes de productos, representa una oportunidad muy importante de negociar descuentos con los proveedores. No es difícil entender que podemos obtener mejores
precios y condiciones de pago si negociamos la compra de 1,000 toneladas de alimento balanceado que se requiere entre todos los Asociados, a que cada uno quiera negociar las 10 ó 100 que puedan necesitar individualmente.
Mejores clientes y precios. Al igual que el hecho de concentrar las compras tiene un beneficio en la reducción de costos, la concentración del producto a venta abre las puertas para obtener mejores
contratos y precios en compradores que requieren altos volúmenes de producto y con regularidad en las entregas.
Capacitación y transferencia tecnológica. Este insumo es uno de los grandes ausentes en muchos programas de gobierno. Las agrupaciones gremiales pueden cumplir con esta importante función mediante el intercambio de experiencias entre los socios, organización de talleres y la contratación,
entre todos, de un técnico que genere el acompañamiento tecnológico que se requiere. Cuando así sea necesario, la Asociación podrá contratar expertos en temas específicos como sanidad, reproducción, nutrición, etcétera, que sean solicitados por los agremiados.
Integración de la cadena de valor. Para la mayoría de los productores acuícolas, el poder contar con su laboratorio propio de producción de crías (ya sean semillas de moluscos, postlarvas de crustáceos o alevines de peces), así como su propia planta de procesamiento es un sueño lejano, difícil de hacer realidad. En la suma de los esfuerzos de muchos productores organizados, ese sueño se puede volver realidad.
Los laboratorios de crías tienen una importancia económica al poder obtener las crías a menor precio, sin embargo, su verdadera importancia es de carácter estratégico, ya que nada resulta más caro para el acuicultor como no tener disponibilidad de sembrar en las fechas que se requiere o que la calidad genética que se compra da pésimos resultados de crecimiento y sobrevivencia. Los laboratorios pueden ser modestos al principio, utilizando recursos que ya se tienen para posteriormente ser autosuficientes financieramente con la venta de las crías. En muchos casos, una vez abastecida la demanda de los asociados, la venta de excedentes puede constituir una importante fuente de ingresos para fortalecer las actividades de la Asociación.
Al consolidar volumen, se puede convertir en realidad la construcción de plantas de procesamiento, que pueden ser sencillas y austeras al principio y de crecimiento modular. Las plantas les permiten a los productores ingresar a mercados de valor agregado, de mayor margen de utilidad, a los que por sí solos es prácticamente imposible. Al igual que los laboratorios, la planta procesadora no solo le reduce los costos al acuicultor, sino que se puede convertir en un centro generador de ingresos al procesar productos de terceros.
Fomento al consumo y promoción del producto nacional. En un mercado cada vez más competido por diversas fuentes de pro-
teína e importaciones, es necesario promover constantemente el incremento del consumo de productos acuáticos. El fomento al consumo es una actividad que se encuentra normalmente entre las responsabilidades de la mayoría de las autoridades pesqueras y acuícolas en los diversos países, sin embargo, por diversos motivos algunas de estas autoridades no la llevan a cabo. El incremento al consumo es el motor del crecimiento de la producción, de ahí viene su importancia, es por esto que, ante la falta de acción de la autoridad correspondiente, los productores deben organizarse para llevarla a cabo.
Vinculación y colaboración entre Asociaciones. El desarrollo y consolidación de la actividad acuícola puede ser acelerado por medio de la vinculación entre diversos organismos gremiales de diferentes áreas del país e incluso de otros países. No hay necesidad de repetir los mismos errores una y otra vez cuando probablemente la solución a los mismos ya ha sido identificados y resueltos en otras partes del país o del mundo. Las tecnologías actuales de comunicación basadas en internet han venido a revolucionar las comunicaciones. Ya no existen distancias ni costos excesivos que impidan sostener reuniones virtuales a cualquier hora y con participantes en diversas partes del mundo, esto es algo que debemos capitalizar para fortalecer el intercambio de experiencias y establecer redes de conocimiento.
Existen muchas otras gestiones que pueden ser logradas por las Asociaciones, como pueden ser las dispersoras de financiamiento, el establecimiento de fondos de contingencia, laboratorios de análisis sanitarios, etcétera.
Todo lo anterior requiere de recursos económicos para ser realizado, recursos que anteriormente provenían de los gobiernos y que en muchos casos ya no existen. Sin embargo, el potencial está ahí, se requiere, a través de la organización, unidad y disciplina de las Asociaciones, que se busquen en forma profesional las alternativas de financiamiento que vengan a substituir el hueco que dejan los programas estatales cuando se van. El reto no es menor, ya que no es
solo financieros, sino cultural y hasta emocional. Debemos aprender a valorar el bien común dejando aparte los intereses particulares y entender que cuando hablamos de bien común, nosotros estamos incluidos en ese concepto.
Es cierto que son nuevos tiempos, pero el potencial de la acuicultura sigue ahí. Es tiempo de hacer las cosas diferentes y eso aplica a la organización, gobernanza, valores y disciplina de las Asociaciones de productores acuícolas. Es tiempo de cambios. Es necesario cambiar de estrategias, cambiar el marco mental establecido por las condiciones pasadas y construir un nuevo marco de acuerdo con las condiciones actuales.
*Roberto Arosemena es Ingeniero Bioquímico con especialidad en Ciencias Marinas por el Instituto Tecnológico y de Estudios Superiores de Monterrey, Campus Guaymas, y Maestro en Acuicultura por la Universidad de Auburn, Alabama, EE.UU. Cuenta con más de 30 años de experiencia en el sector acuícola de México e internacional. Ha ocupado diversos cargos tanto en el sector privado como en el público. Entre ellos: Presidente fundador de Productores Acuícolas Integrados de Sinaloa A.C., Director General del Instituto Sinaloense de Acuacultura, Secretario Técnico de la Comisión de Pesca en la Legislatura LXII en la Cámara de Diputados del Congreso de la Unión.
Actualmente es asesor de diversos legisladores en materia de pesca y acuicultura en la Cámara de Diputados del Congreso de la Unión, así como de diversas empresas privadas; además es embajador en México del Capítulo Latinoamérica y el Caribe de la Sociedad Mundial de Acuicultura (WAS), Director General del Consejo Empresarial de Tilapia Mexicana A.C. y Director General de NDC Consulting Group. Director de la Asociación Nacional de Piscicultores Marinos A.C. Opiniones y propuestas emitidas a título personal por el autor.
Referencias citadas por el autor, disponibles bajo previa solicitud a nuestro equipo editorial.
Los niveles de oxígeno disuelto en el agua dependen de varios factores ambientales, incluida la temperatura, la altitud (presión barométrica) y la salinidad. Actualmente hay una variedad de tipos de medidores disponibles para su uso en campo, desde el simple oxígeno disuelto y la temperatura hasta las unidades multiparamétricas con todo incluido.
Hablemos de oxígeno disuelto. Este es, sin duda, uno de los parámetros de calidad del agua más importantes a monitorear en los sistemas de acuicultura. La tecnología ha recorrido un largo camino, desde los medidores analógicos con apariencia de caja de radio que comencé a usar hasta los medidores ópticos más nuevos con lecturas inmediatas y que requieren muy poco mantenimiento. Existe una gran variedad de marcas para estos equipos. Sin embargo, este artículo se centrará en los tipos de medidores y sondas que están disponibles actualmente.

Durante los inicios de la acuicultura, no había muchas opciones para medir el oxígeno disuelto. Las lecturas se realizaban mediante procesos químicos. A medida que avanzaron las cosas, se pusieron a disposición del sector medidores electroquímicos como el Modelo 51 de YSI. Estos eran medidores analógicos y fueron caballos de batalla durante varias décadas antes de que los medidores digitales más modernos comenzaran a estar disponibles en el mercado.
Los niveles de oxígeno disuelto en el agua dependen de varios factores ambientales, incluida la temperatura, la altitud (presión barométrica) y la salinidad. Las primeras versiones de los medidores de OD requerían una compensación

manual para estos. Los modelos actuales casi siempre incluyen compensación de temperatura y pueden tener también opción de compensación de salinidad y altitud.
A medida que la industria ha crecido, también lo hizo la inversión de varias empresas en mejores tecnologías para que las utilicen los acuicultores y ambientalistas. Hay una variedad de tipos de medidores disponibles para su uso en campo en estos días, desde el simple oxígeno disuelto y la temperatura, hasta las unidades multiparamétricas con todo incluido.
Uno de los factores a considerar al comprar un medidor de OD es qué tipo de sensor utiliza. Están los sensores galvánicos y polarográficos basados en electroquímicos de estilo antiguo y el sensor óptico que es más novedoso, cada uno de ellos se describe a continuación.
Los sensores polarográficos son el sensor electroquímico original. Este estilo de sonda utiliza un ánodo de metal plateado y un cátodo de metal dorado. Los sensores polarográficos
requieren que el usuario permita que el sensor se caliente o polarice. Una vez que el sensor se calienta o polariza, las lecturas del medidor son rápidas.



Los sensores galvánicos generalmente usan un ánodo a base de plomo y un cátodo de plata. Estos sensores son autopolares y requieren muy poco tiempo de calentamiento previo a su uso.
Tanto el sensor galvánico como el sensor polarográfico requieren un flujo a través de la membrana para proporcionar lecturas precisas. Ambos sensores usan una membrana removible a través de la cual pasa el oxígeno para reaccionar con el sensor y poder determinar
la concentración de oxígeno a través de una reacción de reducción química.
Estos dos estilos requieren cambios periódicos de membrana y solución, y deben calibrarse con frecuencia. Afortunadamente, la mayoría de los fabricantes de sensores han adoptado una membrana con tapón de rosca que es mucho más fácil de cambiar que la membrana y la junta tórica de estilo antiguo.
La sonda debe recibir un mantenimiento adecuado para obtener lecturas precisas. Esto incluye cepillar las partes exteriores de las sondas para eliminar cualquier acumulación de compuestos y asegurarse de que la nueva membrana esté completamente llena de la solución de la sonda sin burbujas de aire.
Sensor
¡Estos se han convertido en furor dentro del sector, y por muy buenas razones! Los sensores de estilo óptico utilizan una capa de fosforescencia en la tapa del sensor. La sonda emite una luz pulsante que hace que la tapa del sensor resplandezca según la concentración de oxígeno disuelto en el agua. Los medidores que utilizan este estilo de sensor tienen una memoria de calibración que requiere muy poco ajuste, y no reacciona a los gases disueltos en la fuente de agua.
Estos sensores son más costosos que los tradicionales, pero las lecturas son más estables, requieren menos calibración y mantenimiento, y no requieren flujo o que el usuario agite el agua alrededor de la sonda. Este estilo es una excelente opción para medidores que se utilizan constantemente en el campo.
Todos estos sensores están disponibles con varias opciones en términos de interfaz de usuario. Algunos de los más económicos no son impermeables, mientras que los modelos más caros incluyen carcasas impermeables, memoria interna y descargas opcionales de software que ayudan a mantener disponible la información de tendencias, lo que permite una mejor gestión de los sistemas acuáticos.
Los modelos de gama alta incluyen sensores adicionales como pH, ORP, conductividad y otros parámetros comunes de calidad del agua. La decisión final sobre qué modelo elegir depende de la aplicación. Al final del día, es muy importante que las instalaciones tengan una forma de monitorear el oxígeno en su sistema, para ayudar a evitar pérdidas catastróficas debido a la variabilidad del OD en sus sistemas de producción.
Contacto: amy@aquaticed.com


La tecnología, las redes sociales y las plataformas digitales evolucionan constantemente, por lo que es responsabilidad de una empresa mantenerse actualizada sobre los posibles problemas que surjan en estos medios, ya que esos problemas no solo influyen, sino que también determinan las acciones que realiza un negocio con presencia en línea.
La tecnología, las redes sociales y el panorama de conectividad vía internet están en constante evolución, lo que puede ser un desafío para mantenerse al día sobre las nuevas características y actualizaciones de una determinada plataforma, las tendencias cambiantes de la audiencia y los problemas sociales y regulatorios relacionados con estas plataformas de comunicación. Con eso en mente, a continuación se analizan cinco temas que las empresas deben considerar con respecto a su estrategia en línea.
¿Por qué considerar el uso del comercio social cuando es posible que ya tenga una tienda en línea en su sitio web? Cuando se pregunta
a los consumidores, estos clasifican constantemente el aprendizaje e zvstigación de productos como una de las principales razones por las que siguen a una empresa en las redes sociales. Por ello, el comercio social puede ayudar a reducir la barrera de compra al disminuir la cantidad de pasos que debe seguir un cliente para comprar un producto que aparece en las publicaciones de las redes sociales. Las funciones del comercio social en plataformas como Facebook e Instagram permiten etiquetar publicaciones de fotos y videos con un enlace que lleva al cliente directamente a ese producto en una tienda en línea. El cliente no tiene que abrir una nueva página del navegador, navegar al sitio web de la empresa, encontrar el artículo que vio en la publicación y, según la
plataforma de comercio electrónico utilizada; es posible que no necesiten siquiera agregarlo a su carrito de pago. Estas acciones se agrupan en un solo paso para ellos.
Además, considere cómo es que la gente compra en persona. La compra por impulso no es poco común. La información de Statista muestra que la proporción de compras realizadas por impulso oscila entre el 35% para los mayores de 65 años y el 49% para los de 18 a 24 años. Y aunque las compras a través del comercio social aún no están muy extendidas, las encuestas muestran que las personas más jóvenes han comprado con mayor frecuencia a través del comercio social y están más interesadas en el estas plataformas. Por lo tanto, considere la composición de su base
de clientes, su segmento de clientes ideal y su uso de las redes sociales al evaluar si debería o no adoptar el comercio social con su empresa.

La privacidad sigue siendo una preocupación importante tanto para los consumidores como para las empresas. Según el Centro de Investigación Pew, el 63% de los usuarios de redes sociales sabe poco sobre las leyes y regulaciones de privacidad actuales, el 72% cree que se está rastreando las actividades en línea y el 79% está preocupado por lo que se hace con los datos recopilados sobre ellos.
Las preocupaciones por la privacidad llegaron a los titulares mediáticos en Estados Unidos cuando, en 2016, Cambridge Analytica, una firma de datos políticos, pudo acceder a información privada sobre millones de usuarios de Facebook. Esta información “incluía detalles sobre las identidades de los usuarios, las redes de amigos y los me gusta” (New York Times, 2018). Luego, en 2018, se promulgó el Reglamento General de Protección de Datos (GDPR) en la Unión Europea, en respuesta a las preocupaciones sobre la privacidad. El GDPR otorgó a los residentes de la UE el derecho
a conocer y controlar los datos que las empresas recopilan y conservan sobre ellos. “En el momento en que una empresa de este tipo captura una dirección de correo electrónico de un residente de la UE con la intención de comunicarse con él y realizar un seguimiento de su respuesta, la empresa se convierte en objeto del GDPR, independientemente de dónde se encuentre ubicada la empresa, el servidor o el asunto en ese momento” (Arke sitio web, 2018). Más recientemente, Apple ha anunciado su intención de implementar el sistema Identifier for Advertisers (IDFA) para brindar mayor transparencia a los usuarios de la aplicación. Según las noticias de CNBC, la configuración para optar por el seguimiento de datos se presentará a los usuarios en una ventana emergente cuando la aplicación se inicie por primera vez, en lugar de proporcionar una configuración de exclusión voluntaria en lugar de que los usuarios tengan que navegar a ello por si mismos en la aplicación. Los datos de usuario recopilados por las plataformas de redes sociales se utilizan luego dentro de la rama de publicidad de una plataforma por parte de las empresas para orientar sus campa-
ñas publicitarias. Esto ha llevado a Facebook a argumentar que el resultado probable del uso del IDFA será un aumento en los usuarios de aplicaciones que optarán por no realizar el seguimiento, lo que generará menos datos y, por lo tanto, una disminución de la efectividad de los anuncios para las pequeñas empresas que dependen de esos datos al configurar sus campañas publicitarias.
El panorama tecnológico está evolucionando para beneficiar una vez más a las empresas que recopilan y mantienen sus propias listas para la comunicación directa con los clientes. Sin embargo, al hacerlo, será crucial resaltar la posición de la empresa sobre la transparencia y el control de clientes y seguidores con respecto al uso de sus datos.
La capacidad de las empresas para proyectar autenticidad y generar confianza con su audiencia en línea sigue siendo importante. Las investigaciones han demostrado que los consumidores confían en las recomendaciones de amigos y familiares. Con eso en mente, las empresas se han volcado cada vez más
bien existe cierto grado de riesgo al compartir valores más personales y profundamente
a la curaduría y el intercambio de contenido que destaque sus productos o negocios que fueron creados y publicados por primera vez por miembros de su audiencia o clientes. Sin embargo, si lo hacen, se corre el riesgo de entrar en un potencial campo legal minado de propiedad del contenido. Las empresas que deseen compartir el contenido de otros deben tomar medidas para obtener el permiso del creador original. Hacerlo garantiza que no se violen los derechos de autor y que el creador / propietario se sienta cómodo con el uso previsto del contenido y lo apruebe.
Las empresas se han sentido cómodas contando su historia a través de su presencia en línea al compartir la historia de la empresa, dar una mirada “detrás de la cortina” o perfilar a los propietarios y empleados que la integran, sólo por nombrar algunos ejemplos, para establecer una conexión más personal con los consumidores. Sin embargo, a medida que los consumidores expresan cada vez más su deseo de conectarse y apoyar a las empresas con las que se identifican o que apoyan cuestiones importantes para ellos, compartir los valores comerciales y de los propietarios se ha vuelto más importante. Algunos de estos valores incluyen el apoyo propio de la empresa a su comunidad local u
organizaciones benéficas, prácticas de sostenibilidad, inclusión y más. Si bien existe cierto grado de riesgo al compartir valores más personales y profundamente arraigados, de manera sensible y respetuosa, las empresas pueden aprovechar el deseo de los consumidores de conectarse con empresas de ideas afines compartiendo sus posiciones sobre temas relevantes.
Durante el último año, los eventos y experiencias virtuales como recorridos en línea, ferias y exposiciones, conferencias, etcétera se han vuelto vitales para muchas empresas, tanto las que dirigen el mercado como las que no lo hacen. En el futuro, se anticipa que las experiencias virtuales continuarán ofreciéndose en algún nivel ahora que los consumidores y las empresas se sienten cómodos con el formato. Sin embargo, las experiencias virtuales no pueden reemplazar totalmente a la experiencia en persona. Por tanto, es fundamental determinar los objetivos e identificar las expectativas del cliente. Al planificar una experiencia virtual, las empresas deben:
• Emparejar el formato de la experiencia y la plataforma utilizada con los objetivos establecidos.
• Asegurarse de que las expectativas del cliente se establezcan de manera adecuada al comercializar experiencias virtuales.
• Considerar la cantidad de participantes alojados para eventos individuales. Si bien ofrecer eventos virtuales permite que una empresa llegue a audiencias más grandes, considere si se sacrificará la experiencia del cliente.
• Probar siempre la plataforma tecnológica y el equipo que se utilizará. Si bien la mayoría de los consumidores comprenden los problemas técnicos, aún esperan que cuando las empresas ofrecen experiencias virtuales, particularmente por una tarifa, exista un conocimiento razonable de cómo usar la tecnología y el equipo a los que se recurre.

• Asegurarse de que el entorno es propicio y apropiado para el evento virtual.
• Considerar el tiempo que llevará la experiencia virtual. Es posible que el tiempo dedicado a una actividad o experiencia en persona no se traduzca bien en una experiencia virtual.
El panorama tecnológico cambia continuamente y, con él, las opciones de las empresas para utilizar esa tecnología. El panorama social y legal también evoluciona, por lo que es responsabilidad de la empresa mantenerse actualizado sobre los temas pertinentes, ya que esos temas pueden no sólo influir, sino también determinar las acciones que una empresa toma en línea.
Referencias citadas por la autora en la elaboración de esta columna disponibles, bajo previa solicitud a nuestro equipo editorial.
* Sarah Cornelisse forma parte del equipo de extensión en emprendimiento agrícola y gestión empresarial en la Universidad de Penn State dentro del Departamento de Economía Agrícola, Sociología y Educación. Sarah tiene experiencia en marketing directo, valor agregado, espíritu empresarial y marketing de productos alimenticios. Se especializa en el uso de medios digitales y sociales para la producción agrícola, el marketing de empresas alimentarias, su planificación y toma de decisiones en negocios. Es originaria del estado de Nueva York, tiene una licenciatura en matemáticas por la Universidad Estatal de nueva York y dos grados de maestría en Economía Agrícola y Ciencias Animales, ambos por la Universidad de Penn State. Correo electrónico de correspondencia: sar243@psu.edu
Si
arraigados, de manera sensible y respetuosa, las empresas pueden aprovechar el deseo de los consumidores de conectarse con empresas de ideas afines compartiendo sus posiciones sobre temas relevantes.

Acuicultura
Esta nueva tecnología acuícola supone un importante avance en el desarrollo e innovación de la acuicultura moderna y viene a reafirmar la importancia y versatilidad de la acuicultura simbiótica en la actualidad.
La acuicultura multitrófica integrada conocida por sus siglas como AMTI, ha sido usada en Asia desde hace siglos, donde policultivos de algas, camarones y peces eran cultivados de forma conjunta en bahías poco profundas (Li, 1987; Chan, 1993).

En un sistema clásico multitrófico integrado, se define una especie objetivo sobre la cual se concentra el esfuerzo en alimentación. Los residuos generados en el cultivo de la misma suponen la fuente de materia y energía para el crecimiento de una segunda especie que conforma el segundo nivel trófico. Los residuos generados en el segundo nivel, sirven como alimento y/o fertilizante para el desarrollo de un tercer nivel trófico. Estos residuos están compuestos en su mayor parte por materia orgánica disuelta, suspendida o sedimentada y sustancias inorgánicas nitrogenadas y fosfatadas. Normalmente, los primeros niveles tróficos están compuestos por especies cultivadas omnívoras o carnívoras (peces o camarones), los niveles finales tróficos están compuestos por especies animales filtradoras (moluscos bivalvos) o especies vegetales (algas).
En AMTI se ofrece un beneficio claro a los organismos co-cultivados al convertir el alimento no consumido y los desechos en recursos (fertilizantes o alimentos) para el resto de organismos cultivados. A su vez, el consumo de materia orgánica y desechos supone una importante mejora de la calidad del agua, lo que beneficia a todos los organismos involucrados en el sistema.
En AMTI se genera un cierto beneficio entre las especies cocoultivadas, ya que los niveles subsiguientes se caracterizan por retirar ciertas sustancias orgánicas e inorgánicas de desecho lo cual repercute en una mejora de la calidad de agua en general. Por ello, AMTI puede considerarse, en parte con una cierta funcionalidad simbiótica. Sin embargo, los organismos cultivados implicados en AMTI no generan ningún otro beneficio de vuelta a los niveles anteriores.

La acuicultura simbiótica se basa en incentivar relaciones mutuamente beneficiosas entre dos o más partes. En la mayoría de las tecnologías simbióticas: tecnología biofloc (BFT), tecnología aquamimicry (AQT) o tecnología bioaquafloc (BAF, tecnología híbrida entre las dos primeras) una de las partes beneficiadas está compuesta por ciertos microorganismos (bacterias, protozoarios, microalgas y zooplancton), siendo los organis-

mos de cultivo los que conforman otra parte.

En la acuicultura simbiótica los microorganismos conformantes de los bioflóculos y el zooplancton generan ciertos servicios al cultivo: i) biorremediación, ii) eliminación de agentes patógenos, iii) sirven como alimento natural y iv) aumento de la supervivencia. Los organismos de cultivo, de vuelta, aportan a los microorganismos un lugar donde proliferar y alimento en forma de heces, alimento no ingerido y sustancias tóxicas resultantes del metabolismo tal como amonio NH4+y amoniaco NH3. Normalmente estas sustancias no ingeridas, no digeridas y/o tóxicas se generan en altas concentraciones justificando en las diversas tecnologías simbióticas, el uso de sedimentadores externos o toilets acuícolas.
La acuicultura simbiótica se enfoca en usar los sólidos suspendidos como un insumo para el cultivo de otros organismos acuícolas. Estos sólidos suspendidos están conformados principalmente por bioflóculos, zooplancton, alimento no ingerido y heces (alimento no digerido o semi digerido). Tanto bioflóculos como zooptlancton presentan perfiles nutricionales de altísima calidad con presencia de ácidos grasos esenciales de gran valor nutricional tal como el ácido eicosapentanoico (EPA) y ácido docosahexaenoico (DHA), (Cardona et al 2016, Crab et al 2010, Promthale el al 2019). También presentan perfiles de aminoácidos esenciales, fósforo, vitaminas y minerales esenciales para el cultivo de organismos acuáticos (Avnimelech 2015).

Nacimiento de la acuicultura multitrófica integrada simbiótica - AMTIS
La acuicultura multitrófica integrada tradicional o clásica (AMTI) se caracteriza por definir niveles tróficos jerárquicos claros, uno seguido de otro, donde los residuos del primer nivel sirven como insumo para el nivel trófico siguiente y la repetición de este patrón. La única conexión entre niveles tróficos en AMTI es, como se comentó anteriormente, un
cierto mejoramiento de la calidad del agua.
Si se aplica la tecnología simbiótica a la AMTI surge un nuevo nivel trófico especial, caracterizado por no contener una especie de cultivo, es transversal y genera beneficios a las especies cultivadas del resto de los niveles tróficos. Este nuevo nivel está compuesto de microorganismos en forma de bioflóculos y zooplancton.
La unión de AMTI y la tecnología simbiótica da lugar a una nueva tecnología llamada acuicultura multitrófica integrada simbiótica (AMTIS).

Esta se asemeja a la acuicultura simbiótica tradicional (reducción del recambio de agua, aplicación de fuentes de carbono tales como melaza y/o fermentos, altas densidades de cultivo y ciertos incentivos) pero en condición de policultivo y limitando la extracción de sólidos.
Beneficios de la acuicultura multitrófica integrada simbiótica - AMTIS

En el caso de AMTIS, todos los organismos de cultivo implicados generan un aporte de materia orgánica e inorgánica que supone el principal sustento para bioflóculos y zooplancton. Ya no solo hay una transferencia de materia orgánica e inorgánica (heces, alimento no ingerido, amoniaco, amonio entre otros) de un nivel a otro, sino que existe otro nivel trófico formado por microorganismos, que es central y transversal al resto de niveles tróficos que aporta diversos beneficios. Entre estos beneficios se observa el desplazamiento de agentes patógenos, el aumento de la densidad de cultivo, la generación de alimento natural, limitación de los recambios de agua, el aumento de la supervivencia y el mejoramiento de la calidad de agua principalmente.
Por otra parte, las bacterias conformantes de los bioflóculos en
AMTIS generan moléculas orgánicas tales como el polihidroxibutirato (PHB), ácido butírico, valérico, propiónico, fórmico, acético láctico entre otros que tienen un efecto antagónico con diversos patógenos.
La presencia de bioflóculos también genera ciertos benéficos a nivel fisiológico en la salud de los organismos (Ekasari et al 2014 y Xu y Pan 2013). Entre estos está el aumento de los hemocitos totales y de la actividad fagocítica. También se determinó un aumento en la actividad de la enzima prophenoloxidasa (proPO) que está relacionada con la defensa antioxidante. Asimismo, se genera un aumento de la actividad “explosión oxidativa” que es un mecanismo relacionado con la defensa microbiana.
La nueva AMTI simbiótica está siendo aplicada en Asia y Latinoamérica de manera exitosa principalmente con organismos animales acuáticos sin intervención de niveles tróficos fotoautotróficos (vegetales). Este es el caso de los cultivos en multinivel trófico de cultivo de tilapia (Oreochromis niloticus), camarón (Litopenaeus vannamei) y el mejillón caballo (Modiolus modiolus) en Tailandia por la empresa Venture farm Pte. Ltd.
*Referencias citadas por el autor disponibles bajo previa solicitud a nuestro equipo editorial.
Doctor en ecología marina, Máster en acuicultura y Licenciado en Ciencias Ambientales por la Universidad de Murcia. Colaborador de investigación en laboratorios en Francia, Corea del Sur, Australia y México. Fue investigador nacional SNI1 en México. Consultor de Conservation International Foundation en Costa Rica y Asesor internacional de empresas productivas en tecnologías acuícolas simbióticas. Revisor de la Revista Ingeniantes CITT. Tutor académico de tesis de doctorado en tecnologías simbióticas. Fundador y gerente de la web de acuicultura simbiótica www.bioaquafloc.com
Con el tiempo, P.vannamei se convirtió en la principal especie cultivada en América y el sudeste asiático. Esta especie está domesticada a todos los efectos prácticos y puede crecer en una amplia variedad de condiciones. Sin embargo en la actualidad parece que las presiones que impulsaron el advenimiento de la producción a gran escala de P.vannamei son tales que algunos están abogando por un retorno a la producción de P.monodon en una escala mucho mayor. En opinión del autor, la industria necesita limpiar sus prácticas actuales y encontrar soluciones para arreglar lo que está mal a nivel mundial y no creer que cambiar las especies es la solución.
Los camarones se cultivan desde hace mucho tiempo. Nadie sabe con certeza cuándo comenzó la captura de alevines de camarón que habían migrado a los charcos dejados por la marea, probablemente hace muchos siglos. Sin embargo, solo a partir de la década de 1960 se preparó el escenario para que la acuicultura evolucionara hacia los paradigmas de producción que vemos hoy. Esto fue resultado de los investigadores que descubrieron cómo desovar reproductores de camarón Kuruma (Penaeus japonicus) en cautiverio. Aunque algunos acuicultores todavía cultivan camarones atrapando los flujos de las mareas en los estanques, esto es solo un porcentaje muy pequeño del tonelaje total que se produce, la mayoría de la producción está basada en estanques.
En los primeros días del cultivo estructurado de camarón, gran parte de este se llevó a cabo en algunos países del sudeste asiático, con Japón (con el langostino Kuruma de agua fría), China (tanto en el continente como en Taiwán) y Tailandia a la cabeza de la lista. Había varios posibles animales candidatos para elegir, pero uno se destacó del resto, este era el camarón tigre o Penaeus monodon que fue la especie de camarón de cultivo comercial de más rápido crecimiento y tamaño más grande. Antes de la disponibilidad

de P. vannamei libre de patógenos específicos (SPF), P. monodon era la especie preferida en gran parte del sudeste asiático. P. vannamei fue la especie elegida para las Américas.
El cultivo de camarón presenta muchos desafíos, siendo quizás el mayor de ellos: la presencia de enfermedades. La industria está dominada por pequeños acuicultores con poca o ninguna comprensión de las herramientas necesarias para garantizar una producción exitosa y constante, el sello distintivo de la sostenibilidad. Los brotes masivos de una variedad de patógenos han interrumpido el negocio global con regularidad y, a pesar de que muchos deseen lo contrario, lo más probable es que continúen haciéndolo.
Siguiendo un enfoque para disminuir el impacto de las enfermedades en las especies cultivadas terrestres, el Oceanic Institute en Hawaii desarrolló cepas de P. vannamei que eran SPF. Esto no significa que no hubiera patógenos presentes y tampoco significa que los animales tuvieran la clasificación SPF porque fueran resistentes a estos patógenos específicos. Esto se comprobó en América Latina desde el principio y en Ecuador se hizo de manera incorrecta. Resultó que los organismos tenían una mayor susceptibilidad a uno de los virus comunes. Ha habido mucha especulación sobre el porqué de esto y, sin duda algu-
nos de los factores importantes que contribuyeron a esto fueron el uso de semillas silvestres y un enfoque que se preocupó poco en términos de controlar qué patógenos estaban presentes en el sistema de producción. En otros lugares, los animales parecían tener mejores resultados

El siguiente paso en la evolución del cultivo de camarón: ¿un paso hacia adelante o hacia atrás?
que los provenientes de semillas silvestres y hubo un movimiento lento pero inexorable para alejarse del uso de estas semillas de origen silvestre en muchas áreas. Las semillas silvestres no se utilizan ampliamente en la actualidad, aunque algunos productores todavía prefieren trabajar con ellas.
El origen de la semilla de P. monodon fue de reproductores silvestres. Muchos de estos animales transportaban, en ese momento, patógenos desconocidos a los sistemas de producción. Los brotes generalizados de enfermedades, el crecimiento y la supervivencia deficientes los hacían menos atractivos que P. vannamei P. monodon es carnívoro, mientras que P. vannamei es omnívoro. El alimento cuesta menos para P. vannamei. Además esta especie es mucho menos agresiva y se puede sembrar en densidades mucho más altas.

Con el tiempo, P. vannamei se convirtió en la principal especie cultivada en América y el sudeste asiático. Esta especie está domesticada a todos los efectos prácticos y puede crecer en una amplia variedad de condiciones. La producción se disparó incluso con los brotes periódicos de enfermedades graves. El mercado global aceptó fácilmente estos camarones y la producción, preCOVID-19, alcanzó su punto máximo en el rango de 4 a 5 millones de TM por año. Mientras tanto, algunos todavía producen P. monodon a bajas densidades y mayores costos de producción. La producción se ha estancado a nivel mundial en alrededor del nivel de 800 mil TM. Este es prácticamente el nivel máximo alcanzado antes de la disponibilidad de animales SPF de P. vannamei
Ha habido un esfuerzo concertado en los últimos años para mejorar la genética de estas dos especies, especialmente para P. vannamei. En este momento, el programa de genética de Charoen Pokphand (CP) en Tailandia parece estar muy adelantado en el tema ya que han domesticado con éxito a P. vannamei y
comercializan animales que pueden crecer más de un gramo por día en condiciones exigentes y aproximadamente la mitad de este promedio en escenarios de producción típicos. Sus organismos crecen muy bien a altas densidades (100 por m2), son refractarios a muchos factores estresantes comunes y además son tolerantes a varios patógenos muy importantes. Estos animales tienen el potencial de cambiar por completo los paradigmas de producción actuales. Otras empresas se están quedando atrás aunque no es ningún secreto que algunas de ellas han incorporado la línea de CP a sus propias líneas de producción. La domesticación de P. monodon es una prioridad menor actualmente, aunque CP también ha logrado avances significativos en este frente.
Las cepas domesticadas de P. vannamei que están disponibles actualmente son tales que hay pocas razones económicas para considerar volver al cultivo de P. monodon. Los primeros crecen mucho más rápido con un menor costo de producción. Sin embargo hay quienes ven la diferencia en los niveles de producción global como una oportunidad y hay áreas en las que se están cultivando ambas especies y, en algunos casos, los productores se están alejando cada vez más de P. vannamei

Como he escrito muchas veces, las razones por las que los acuicultores fracasan en el cultivo de P. vannamei no son situaciones que no podrían abordar si ellos y sus gobiernos regionales tuvieran la voluntad y estuvieran dispuestos a escuchar a los que saben lo que está sucediendo, y a lo que es real y lo que no lo es en el sector. Muchos proveedores de PL mezclan animales SPF de P. vannamei con reproductores de sus estanques y el espectro de la enfermedad continúa teniendo un impacto tremendo en los resultados generales.
La industria en su conjunto no parece entender lo que realmente significa SPF. Se hacen suposiciones
sobre la falta de un patógeno determinado en una población basándose en un método de prueba que no puede proporcionar esta respuesta. Un gran número de animales que contienen niveles bajos de las principales enfermedades y, hasta el momento, patógenos no caracterizados plantean obstáculos formidables para la sostenibilidad. Parece que las presiones que impulsaron el advenimiento de la producción a gran escala de P. vannamei son tales que algunos están abogando por un retorno a la producción de P. monodon en una escala mucho mayor. Hay poblaciones SPF de esta especie disponibles, e incluso posiblemente algunas que pueden estar absolutamente libres de patógenos.
En opinión del autor hay pocas razones para retroceder hasta cierto punto. La comunidad mundial debe centrarse en crear las mejores condiciones para un producto óptimo de animales genéticamente mejorados (no OGM). Hasta que la comunidad se ocupe de algunos de los problemas que subyacen en gran parte de los desafíos actuales, es muy probable que, si bien podemos ver mayores cantidades de P. monodon

en el mercado, las prácticas culturales actuales inevitablemente resulten en la falta de eficiencia que ha precedido fallos anteriores. La industria necesita limpiar sus prácticas actuales y encontrar soluciones para arreglar lo que está mal a nivel mundial y no creer que cambiar las especies es la solución.

La sabiduría de George Santayana es apropiada aquí “aquellos que no pueden recordar el pasado están condenados a repetirlo”. Hasta la fecha hay pocas razones para creer que la comunidad mundial de camaroneros haya aprendido las lecciones que necesitan para evitar repetir los fracasos masivos del pasado.
Stephen Newman es doctor en Microbiología Marina con más de 30 años de experiencia. Es experto en calidad del agua, salud animal, bioseguridad y sostenibilidad con especial enfoque en camarón, salmónidos y otras especies. Actualmente es CEO de Aqua In Tech y consultor para Gerson Lehrman Group, Zintro y Coleman Research Group.
Contacto: sgnewm@aqua-in-tech.com www.aqua-in-tech.com www.bioremediationaquaculture.com www.sustainablegreenaquaculture.com

AQUACULTURE AMERICA 2021
Ago. 11 – Ago. 14
San Antonio, Texas, E.U.A.
T: +1 760 751 5005
E: worldaqua@was.org W: www.was.org
WAS ACUACULTURA NORTE AMÉRICA
2021 Sep. 26 – Sep. 29
St John’s Newfoundland, Canada
T: +1 760 751 5005
E: worldaqua@aol.com W: www.was.org
AQUACULTURE EUROPE 2021

Oct. 4 – Oct. 8
Madeira, Portugal
T: +1 760 751 5005
E: worldaqua@aol.com W: www.was.org
RAS TECH 2021
Nov. 3 – Nov. 4
Hilton Head, Carolina del Sur, EE.UU.
T: +1 760 751 5005
E: worldaqua@aol.com W: www.was.org
WORLD AQUACULTURE 2021
Nov. 8 – Nov. 12
Mérida, México
T: +1 760 751 5005
E: worldaqua@aol.com W: www.was.org
AQUATIC ASIA 2021
Nov. 24 – Nov. 26
Tangerang, Indonesia
W: www.aquaticasia.comg
WORLD AQUACULTURE SINGAPUR
Dic. 5 – Dic. 8
Singapur, Singapur
T: +1 760 751 5005
E: worldaqua@aol.com W: www.was.org
AQUACULTURE AFRICA 2021
Dic. 11 – Dic. 14
Alejandría, Egipto.
T: +1 760 751 5005
E: worldaqua@aol.com W: www.was.org
AQUAFUTURE SPAIN 22 Mar. 24 – Mar. 26
Santiago de Compostela, España
T: +1 620 681 861
E: okeventos.juan@gmail.com W: www.aquafuturespain.com
ALIMENTOS BALANCEADOS
GPO GAM...........................................................1 y 10
Contacto: Adriana Armijo Tel: +668 817 5471
E-mail: ventaspacifico@gbpo.com.mx www.gbpo.com.mx
GRUPO NUTEC.........................................................35 www.gpnutec.com
National Renderers Association, Inc.....................73
Oficina para Latinoamérica: Sierra Candela 111 Oficina 501. Lomas de Chapultepec C.P. 11000 CDMX
Contacto: Luz María Cano. Tel: (55) 55 5980 6080
E-mail: nramex@nralatinamerica.org
NUTRIMENTOS ACUÍCOLAS AZTECA..................47
Calle Anillo Periférico Sur 6108, CP 45615, San Pedro Tlaquepaque, Jalisco, México.
Contacto: Ing. David González Contreras E- mail: azteca.planta@aztecamexico.mx Tel: +52 333 601 2035 Cel: +52 1 331 011 5849 www.aztecamexico.mx
MEGASSUPPLY..............................................10 y 103
EE.UU., Europa, Sudamérica, Asia y Medio Oriente. Tel.: +1 (786) 221 5660 Fax: +1 (786) 524 0208 www.megasupply.net
PHODÉ.....................................................................107
E- mail: phode@phode.com www.phode.com
PRAIRE AQUATECH.................................................91 https://prairieaquatech.com/
Proteínas Marinas y Agropecuarias S.A. de C.V...138
Calle 2 cañas #2775. C.P. 44470 Guadalajara, Jalisco, México Tel: +52 (33) 3810 2185
E-mail: contac@protmagro.com www.protmagro.com
SKRETTING.............................................................81
Km 6.5 vía Durán-Tambo, Durán, Ecuador
Contacto: Piero Botteri Tel: +593 9693 78133
E-mail: piero.botteri@skretting.com https://www.skretting.com/es-EC/
VITAPRO / NICOVITA......................................114-115
Av. Jorge Basadre 233, oficina 301, San Isidro. Lima–Perú.
Contacto: Margarita Ortiz de Zevallos Tel: (511)377 7370 – ext. 423006 Cel: 9855 92933
E-mail: mortizb@vitapro.com.pe www.vitapro.com.pe
Zeigler Bros, Inc.........................Segunda de Forros
400 Gardners, Station RD, Gardners, PA. 17324, EE.UU.
Contacto: Susan Thompson Tel: 717 677 6181
E-mail: sales@zeiglerfeed.com www.zeiglerfeed.com
ANTIBIÓTICOS, PROBIÓTICOS Y
DSM Nutritional Products Latin America..............53 San José, Costa Rica. E-mail: Thiago.Soligo@dsm.com www.dsm.com
INVE Aquaculture Inc...............................................79 3528 W 500 S-Salt Lake City. UT. PO 84104 EE.UU. Contacto: Teri Potter. Tel: (801) 956 0203 E-mail: tpotter@inve-us.com www.inve.com
LANXES Virkon Aquatic..........................................61
Tel: (593-4) 2133258 / 2133247 / 2133089 E-mail: informacion@chemicalpharm.com www.chemicalpharm.com
MSD MERCK............................................................17
Oficinas Corporativas San Jerónimo Avenida San Jerónimo 369 Piso 5. Col. la Otra Banda. Alvaro Obregón 01090 CDMX. Sitio de Producción Santa Clara Plásticos No. 28 Santa Clara Coatitla 55540 Ecatepec de Morelos, Estado de México. Tel: + 5255 5569 1227 http://www.msd.com/contact/contacts.html
Prilabsa International Corp....................................15 2970 W. 84 St. Bay #1, Hialeah, FL. 33018, EE.UU. Contacto: Roberto Ribas. Tel: 305 822 8201, 305 822 8211 E-mail: rribas@prilabsa.com www.prilabsa.com
ZOETIS.....................................................................19 https://www.zoetis.mx/
COSECHADORAS, MAQUINARIA Y EQUIPO PARA FABRICACIÓN DE ALIMENTOS E.S.E. & INTEC.......................................................135
Hwy 166 E., Industrial Park, Caney, KS, 67333, EE.UU. Contacto: Mr. Josef Barbi Tel: 620 879 5841, 620 879 5844 E-mail: info@midlandindustrialgroup.com www.midlandindustrialgroup.com
Extrutech.................................................................23
343 W. Hwy 24, Downs, KS 67437, EE.UU. Contacto: Judy Long. Tel: 785 454 3383, 785 284 2153, 52 2955 2574 E-mail: extru-techinc@extru-techinc.com, osvaldom@extru-techinc.com www.extru-techinc.com
IOSA DE LOS MOCHIS...........................................57
Av. Revolución 332 pte. Col. Miguel Hidalgo. Los Mochis, Sinaloa, México. Tel: 668 812 2399 www.iosa.lat
Magic Valley Heli-Arc & Mfg., Inc............................9
P.O. Box 511 Twin Falls Idaho, EE.UU. 83303
Contacto: Louie Owens Tel: (208) 733 0503
E-mail: louie@aqualifeproducts.com www.aqualifeproducts.com
Contacto en México: Agustín González E-mail: ventas@acuiprocesos.com Tel.: +52 (33) 3632-4042
Wenger.....................................................................29
714 Main Street PO Box 130.
Sabetha, Kansas EE.UU. C.P. 66534
Contacto: Rhonda Howard. Tel: 785-284-2133 E-mail: quin@magiccablepc.com www.wenger.com
Instruments México.....................................37
Vainilla 462 Col. Granjas México.CDMX, México. C.P. 08400
Contacto: Elizabeth Ante Ruíz Tel: +52(55) 5649 1185 E-mail: mkt_logistica@hannainst.com.mx www.hannainst.com.mx
PENTAIR...................................................................59
Tel: +1 407 886 3939 / +1 877 347 4788 www.penairaes.com
Sun Asia Aeration Int´l Co., Ltd.............................33 15f, 7, Ssu-wei 4 road, Ling-ya District, Kaohsiung, 82047 Táiwan R.O.C.
Contacto: Ema Ma. Tel: 886 7537 0017, 886 7537 0016 E-mail: pioneer.tw@msa.hinet.net www.pioneer-tw.com
Frizajal S.A. de C.V..................................................47 Melchor Ocampo 591-B Col. El Vigía C.P. 45140. Zapopan, Jalisco, México. Contacto: Erick Buenrostro Castillo. Tel: 33 3636 4142, Fax: 3165 5253 E-mail: frizajal@prodigy.net.mx
AQUACULTURE AMERICA 2021 SAN ANTONIO...................................................................121 11 al 14 de Agosto, 2021.San Antonio Texas, EEUU. Tel: +1 760 751 5005 E-mail: worldaqua@aol.com www.was.org
AQUACULTURE EUROPE 2021.....CONTRAPORTADA 4 al 7 de Octubre, Madeira, Portugal. www.aquaeas.eu
AquaFuture España 2022.....................................131 24 al 26 de marzo, 2022. Feira Internacional de Galicia ABANCA, Santiago de Compostela. https://www.aquafuturespain.com/
AQUA EXPO GUAYAQUIL 2020.............................95 24 al 26 de Noviembre, 2020. Guayaquil, Ecuador. E-mail: aquaexpoec@cna-ecuador.com
WORLD AQUACULTURE 2021..................................21 8 al 12 de Noviembre, 2021.Mérida Yucatán, México. Tel: +1 760 751 5005 E-mail: worldaqua@aol.com www.was.org
LABORATORIOS
AQUAMOL TILAPIA..................................................7
Km 6 Carretera Jamay / La Barca, Jalisco, México Contacto: 3337198590 E-mail: ventas@aquamolgenetics.com · http://www.aquamol.mx/
AQUATECH CENTER Aqua Array..........................43 E-mail: info@aquatechcenter.com www.aquatechcenter.com/aquaarray
GPO GAM LABORATORIO........................................5 Tel: +668 817 5471 / 8175975 E-mail: ventaspacifico@gbpo.com.mx www.gbpo.com.mx www.grupoacuicolamexicano.com.mx
Aqua In Tech, Inc..................................................137
6722 162nd Place SW, Lynnwood, WA, EE.UU.
Contacto: Stephen Newman. Tel. (+1) 425 787 5218
E-mail: sgnewm@aqua-in-tech.com
COMEPESCA...........................................................11
Contacto: Lu Fernández
Tel: +52 (55) 3959 2572
E-mail: lfernandez@comepesca.com
Empresarios No. #135 Int. Piso 7 Oficina 723 Col. Puerta de Hierro, C.P.45116. Zapopan, Jal. México. Cruza con las calles Av. Paseo Royal Country y Blvrd. Puerta de Hierro
Tels: +52 (33) 8000 0578
Contacto 1: Suscripciones
E-mail: suscripciones@panoramaacuicola.com
Tel: +52 (33) 8000 0629 y (33) 8000 0653
Contacto 2: Juan Carlos Elizalde, ventas y mercadotecnia
E-mail: crm@dpinternationalinc.com
Contacto 3: Claudia Marín, ventas E-mail: sse@dpinternationalinc.com www.panoramaacuicola.com

Design Publications International Inc. 203 S. St. Mary’s St. Ste. 160 San Antonio, TX 78205, EE.UU.
Oficina en EE.UU: +(210) 229 9036 Oficina en EE.UU, Directo: +(210) 504 3642 Oficina en México: (+52) (33) 3632 2355
Suscripciones: iwantasubscription@dpinternationalinc.com
Publicidad: crm@dpinternationalinc.com / sse@dpinternationalinc.com www.aquaculturemag.com
Los sistemas RAS que utilizan energías renovables como: eólica, solar, o geotérmica, se perfilan para asegurar la sostenibilidad ambiental y financiera de la acuicultura. No tanto por un aumento de la producción por unidad de área, sino por la disminución del desperdicio de recursos en el alimento no consumido en jaulas y estanques.
Por: Artemia SalinasEn un mundo que se hace cada día más pequeño, en donde ya se ve el límite de la explotación de muchos recursos naturales, que antes parecían infinitos, el reto de cualquier actividad económica es la posibilidad de mantenerse viable sostenible y financieramente en una escala de tiempo predecible.
En este sentido, el potencial perene que siempre hemos querido ver en la acuicultura, también dibuja sus límites en esa escala de tiempo, y aunque no haya explotado todo su crecimiento anhelado, su desarrollo podría quedar atrapado entre los desafíos del cambio climático, el aumento de los gases de efecto invernadero, la disponibilidad de agua, la viabilidad de la agricultura, y el desorden de la pesca.
La expansión acuícola no solo depende de la sostenibilidad ambiental y financiera de sus granjas y centros de producción, sino de la sostenibilidad de toda la cadena de insumos que hacen posible la producción de pescados y mariscos. Y en este sentido, los alimentos acuícolas tienen la mayor responsabilidad.
Es difícil imaginarse, en un mundo limitado por todos estos factores ambientales y económicos, la situación de alimentar camarones en un estanque, en donde sabemos con anticipación que un porcentaje mayor de este alimento no va a ser ingerido por los camarones en cultivo. Es decir, utilizamos 10 granos o pellets de alimento, para que tal vez un camarón ingiera íntegramente uno o dos. ¿Y el resto de los pellets? el resto de los pellets, si bien puede pasar a formar parte del alimento de una cadena de zooplancton, que después es asimilado por el camarón o colonizarse de bacterias y convertirse en un flóculo rico en nutrientes para ser ingerido
posteriormente por el camarón, es en realidad un desperdicio.
En este alimento desperdiciado, o fertilizante y floculo caro, van algunas toneladas de harina de pescado, harina de soya, de arroz, aceite, canola, y algunos kilos de otros insumos de alta tecnología y de alto valor, como: vitaminas, minerales, probióticos, y si queremos también péptidos, aminoácidos libres, ácidos orgánicos, aceites esenciales, etcétera. Está claro que no deberíamos de desperdiciar ni un gramo de tan basta variedad de insumos, provenientes de un desarrollo tecnológico soportado por el uso de otros recursos más y además con una considerable inversión financiera. Lo que convierte a este alimento no consumido en un verdadero despilfarro y derroche de valiosos recursos agrícolas, ganaderos y pesqueros, entre otros.
En este sentido, la acuicultura en general y en especial la acuicultura de camarón y de salmón, que son las que demandan la mayor cantidad de alimentos especializados con una composición de ingredientes de alto valor, deben de evolucionar urgentemente hacia sistemas tecnológicos de producción que minimicen el desperdicio de recursos.
Este es el gran reto que todos tenemos, y que las empresas de alimentos acuícolas deben liderar. Ya no se trata de hacer alimentos extruidos que duren más tiempo en el agua sin lixiviarse, o con aditivos atrayentes para sean consumidos en menos tiempo, o en alimentar a demanda con alimentadores automáticos. Que, si bien todas estas tecnologías le han dado a la acuicultura un avance importante, aún no limitan el desperdicio de recursos en alimento no consumido, lo que, en un mundo
convulsionado por la disponibilidad de recursos, no va a ser posible.
¿Cuál es el camino? la producción en sistemas RAS en donde se tenga el máximo control de todas las variables del cultivo, pero especialmente de la alimentación. En done cada pellet que se ponga en el agua se tenga la seguridad de que va a ser consumido por la especie en producción, limitando así, por un lado, la sobre formulación de aditivos para asegurar que van a llegar en cantidad y forma a los organismos en cultivo, y, por otro lado, la cantidad de alimento que se iba al desperdicio en los sistemas tradicionales.

Por último, para reflexionar. Si consideramos que el 10% del alimento que se dispersa por los estanques y piscinas de camarón en el mundo, no es consumido por los organismos en cultivo (lo cual es conservador), y que el FCA sea de 1.3 (** lo cual es conservador también) bien podíamos hablar de 650 mil toneladas anuales de alimento no consumido que es en realidad, un total desperdicio. Si multiplicamos estas 650 mil toneladas por US$850.00 por tonelada de alimento para camarón, tendíamos 552 mil millones de dólares anuales vertidos en los estanques de cultivo que el camarón no va a consumir, hasta que se conviertan en zooplancton o en flóculos de bacterias.
Una alianza de fabricantes mundiales de alimento para camarón que Constituya un Fondo de Inversión con estos 552 mil millones de dólares anuales para el desarrollo factible de tecnologías RAS con energías renovables, podría ser mejor idea, que tirarlos al desperdicio en los estanques de camarón.
**(Cifras basadas en los de producción en el 2020, según GOAL.)

